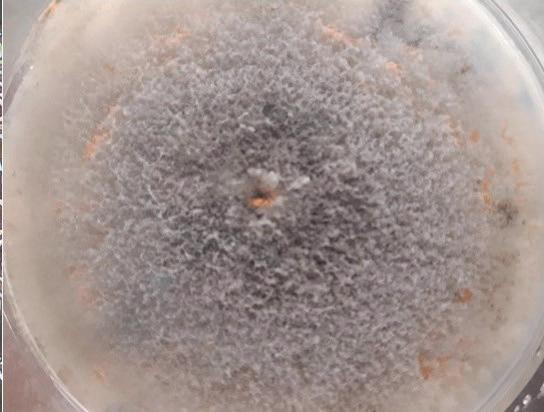

RAPPORTO
CENTRO TRASFERIMENTO TECNOLOGICO
Fondazione Edmund Mach
Email info.ctt@fmach.it Telefono 0461 615461 https://ctt.fmach.it
DIRETTORE EDITORIALE
Maurizio Bottura
CURA E REVISIONE TESTI
Erica Candioli, Franca Ghidoni
FOTOGRAFIE
Archivio FEM-CTT e autori, Archivio IDESIA, Roberta Cainelli, Erica Candioli, Giovanni Cavulli, Matteo de Concini, Matteo Festi, Franca Ghidoni
Pag. 47, 74, 76, 82, 88: Shutterstock
Pag. 95: Baofly
Copertina: Gabriele Iussig
REFERENZE PUBBLICAZIONI
Biblioteca FEM
PROGETTO GRAFICO ED EDITORIALE
IDESIA - www.idesia.it
ISSN 20-37-7541
© 2025, Fondazione Edmund Mach
Via Edmund Mach 1, 38098 San Michele all’Adige (Trento)
sostanza organica e le forme del carbonio che la compongono
IRRITRE: irrigazione di precisione per una gestione idrica consapevole in Trentino
Life Cycle Assessment delle forme di allevamento del melo: caso studio su spindle e guyot
Leaf Spot e Apple Bitter Rot
Colpo di fuoco batterico del melo: quattro anni di monitoraggio dopo l’epidemia del 2020
Sorveglianza fitosanitaria in Trentino: difendere colture ed ecosistemi da specie aliene invasive
Mele a polpa rossa: lo sviluppo di nuove selezioni passa anche da una buona conservabilità
L’annata ciliegio e piccoli frutti
Ceraseto pedonabile: esperienza con diverse combinazioni di portinnesto e forma di allevamento
Esperienze sulle modalità di distribuzione con irroratrici a cannone su fragola coltivata in tunnel
Paysandisia archon: una minaccia per le palme anche in Trentino
L’annata olivicola 2024
Valutazione di prodotti biologici per il contrasto della rogna dell’olivo
Prime evidenze dei funghi associati all’antracnosi del noce in Trentino
L’annata viticola 2024
Quali fattori determinano la biodiversità del suolo nei vigneti trentini?
Sperimentazioni in campo sull’irrigazione della vite
Monitoraggio territoriale delle principali avversità della vite
Rame e zolfo: sinergia per il controllo della peronospora in viticoltura biologica
Ruolo delle proteasi e del riscaldamento del mosto sull’aromaticità dei vini bianchi
L’impiego di Hanseniaspora vineae in enologia: strategie di inoculo e metabolismo aromatico
Interazioni tra lieviti e acido fumarico per nuovi approcci all’acidificazione di mosti e vini
Influenza del processo di dealcolazione del vino sul contenuto di residui di fitofarmaci
Il vino in PET: opportunità, criticità e nuove sfide
Nuove disposizioni per l’etichettatura del vino: ingredienti e tabella nutrizionale
Succo d’arancia e di limone: gli isotopi del carbonio nella determinazione della loro autenticità
Additivi, cottura e digestione: come nascono le nitrosammine nella carne
L’analisi isotopica per la tracciabilità della carne
La razza Rendena: patrimonio genetico e adattamento all’ambiente
Lo starter Fermalga, un aiuto per potenziare la difesa naturale del formaggio “Trentino di Malga”
Quanto la gestione in stalla può limitare la presenza di Escherichia coli STEC nel latte?
Il siero di latte come risorsa: le reazioni di Maillard
Articoli pubblicati su riviste scientifiche con fattore d’impatto
Articoli pubblicati su riviste tecnico-scientifiche e divulgative
PRESENTAZIONE
Questo Rapporto, attraverso l’articolazione dei suoi contenuti, rappresenta la più chiara dimostrazione di come l’attività del Centro Trasferimento Tecnologico della Fondazione Edmund Mach debba essere necessariamente definita “trasversale” rispetto alle altre strutture (Centro Istruzione e Formazione e Centro Ricerca e Innovazione).
Infatti, sia l’azione di supporto alle imprese agricole, sia quella di divulgazione dei dati nonché di formazione specifica (il “patentino” per i prodotti fitosanitari) non possono fare a meno di intersecarsi con l’intero complesso operante a San Michele.
Il Rapporto si articola praticamente in due parti distinte: la prima fornisce un dettagliato riassunto delle ricerche (tutte di natura applicativa) che hanno coinvolto nel corso del 2024 il personale del Centro Trasferimento Tecnologico, mentre la seconda sintetizza quella che possiamo definire la “fase esecutiva”.
Rispetto a quanto riportato nella pubblicazione, tuttavia va anche segnalato che molti operatori del Centro operano anche come concreto supporto alla docenza sia nell’ambito del Corso di laurea in viticoltura ed enologia, sia nelle varie articolazioni del Centro Istruzione e Formazione oltre che nella partecipazione attiva a convegni organizzati sul territorio trentino (e non solo).
Si dimostra così che il Centro Trasferimento Tecnologico è la struttura che nella Fondazione Edmund Mach si fa carico di quel compito istituzionale di un costante e proficuo rapporto con il territorio e soprattutto per quanto riguarda il mondo agricolo e quello ambientale.
Prof. Francesco Spagnolli Presidente Fondazione Edmund Mach
PREFAZIONE
Il Rapporto del Centro Trasferimento Tecnologico (CTT), giunto alla 16a edizione, rappresenta una fotografia dell’attività svolta negli ambiti di ricerca applicata, sperimentazione, consulenza tecnica e monitoraggio del territorio. Tutte queste attività vengono accompagnate dalla formazione e informazione alle imprese agricole, in quanto la divulgazione riveste un ruolo centrale, favorendo l’innovazione tecnologica e la sua applicazione nella quotidianità delle diverse realtà produttive della provincia.
I lavori più significativi realizzati nell’annata di riferimento dal personale del Centro sono il frutto dell’interazione sinergica tra il personale impegnato nella consulenza tecnica e quello nella sperimentazione. Gli obiettivi primari riguardano il raggiungimento di una maggiore sostenibilità delle aziende agricole, in primis economica, ma con ricadute importanti relativamente agli aspetti sociali, etici, ambientali e di presidio e cura del paesaggio, e quindi del territorio nel suo complesso.
Cambiamenti climatici, organismi invasivi, limitazioni legislative, gestione degli alpeggi sono temi che, inseriti nel contesto dell’agricoltura di montagna, mettono in evidenza come i costi di produzione rimangano costanti nella migliore delle ipotesi, ma spesso siano crescenti, considerati gli incrementi delle materie prime e dei costi energetici e alla luce delle dinamiche di mercato dei prodotti agricoli sempre più aleatorie.
Questo Rapporto completa l’attività di comunicazione che il CTT, mediante altri variegati strumenti, utilizza per diffondere sul territorio aggiornamenti tecnici ed indicazioni operative. Notiziari ed avvisi tecnici, incontri in campo e giornate tecniche, corsi in aula e video “tutorial”, sono strumenti di formazione ed informazione che raggiungono migliaia di utenti ogni anno, mantenendo vitale il legame fra la Fondazione E. Mach e il mondo agricolo.
Dott. Maurizio Bottura
Dirigente del Centro Trasferimento Tecnologico Fondazione Edmund Mach
Guida alla lettura
FOCUS SOSTENIBILITÀ
Accanto a questo simbolo gli autori mettono in evidenza come i risultati degli studi e delle sperimentazioni condotte contribuiscono nel concreto al miglioramento della sostenibilità, dal punto di vista ambientale, economico, sociale.
LE RELAZIONI

Andamento climatico 2024
MAURIZIO BOTTURA
Il 2024 è stata un’annata molto piovosa che ha determinato importanti ripercussioni produttive, contraddistinta da un inverno mite, una primavera nella media, un’estate più calda della media e un autunno leggermente superiore alla media.
Il mese di gennaio ha registrato temperature superiori alla media di oltre 1 °C, ma inferiori al 2023; il mese di febbraio ha visto valori di oltre 3 °C superiori alla media, con un picco di 7,5 °C, superiore alla media di alcuni mesi di marzo di annate fredde (dati della stazione meteo di San Michele all’Adige). Marzo si conferma un mese dalle temperature leggermente superiori alla media, mentre aprile ha registrato valori in linea rispetto alla media degli ultimi 25 anni. Aprile è stato caratterizzato da alcune notti di gelo che hanno determinato qualche danno qualitativo e quantitativo su
mele e ciliegie. Maggio e giugno sono stati caratterizzati da un andamento fresco e piovoso, con valori medi inferiori di 0,5 °C sia a maggio che a giugno, rispetto alla media di riferimento. Con luglio sono iniziati 4 mesi con temperature ben superiori alla media: a luglio di 1,5 °C, ad agosto di 2,5 °C (mese più caldo dell’anno), a settembre di 0,5 °C e a ottobre di 1 °C. In particolare, la media registrata in agosto è simile a quella registrata nello stesso mese del 2003. Novembre è stato più fresco della media, mentre dicembre si è attestato su valori superiori alla media di quasi un 1 °C. L’andamento, quindi, ha confermato la presenza di periodi prolungati sempre più caldi e di inverni sempre più miti. L’ultima volta in cui si sono registrate temperature medie negative è stata nei mesi di gennaio 2017 e 2021.
Nel 2024 le precipitazioni hanno raggiunto valori complessivi superiori ai 1.500 mm annui, seconde solo al totale delle piogge del 2014. Solo gennaio, aprile, agosto, novembre e dicembre hanno registrato valori di piovosità inferiori alla media di riferimento degli ultimi 25 anni. A gennaio sono caduti meno di 50 mm, febbraio e marzo hanno registrato valori elevati, con 167 e 158 mm di pioggia. Aprile si è attestato su 72 mm, valore leggermente inferiore alla media. Maggio e giugno sono stati mesi molto piovosi, con 237 mm a maggio e 165 a giugno. In alcune zone del sud del Trentino e della Valsugana si sono avute precipitazioni di oltre 100 mm superiori rispetto ai valori della stazione di riferimento di San Michele solo per il mese di maggio. Luglio, soprattutto nei primi 15 giorni, è stato piovoso con 148 mm di pioggia
caduta. Agosto ha concesso un po’ di tregua con soli 55 mm, mentre settembre e soprattutto ottobre hanno registrato valori record di 185 mm e 272 mm. Novembre, normalmente il mese più piovoso dell’anno, ha registrato invece il valore assoluto più basso dell’anno con 5 mm e dicembre, anch’esso poco piovoso, con 21 mm. Le forti piovosità di maggio e giugno hanno messo a dura prova i frutticoltori e i viticoltori nella difesa fitosanitaria per la ticchiolatura e la peronospora. Inoltre, grosse difficoltà si sono manifestate nella semina del mais e delle patate, nonché nel taglio del primo fieno. Le grandi piovosità poi di settembre e ottobre hanno determinato gravi problemi di praticabilità dei campi durante la raccolta di mele, uva e mais. Quindi il 2024 è stata un’annata molto difficile dal punto di vista agricolo.
Figura 1
Andamento della temperatura nel 2024 in confronto con la media 2001-2023 (stazione meteo FEM di San Michele all’Adige)
Figura 2
Andamento della piovosità nel 2024 in confronto con la media 2001-2023 (stazione meteo FEM di San Michele all’Adige)
DANIELA BERTOLDI
ANDREA CESCHINI
DANIELE
MERCI
La sostanza organica e le forme del carbonio che la compongono
La sostanza organica si forma a partire dai residui organici (es. foglie, parti legnose, ecc.) per azione degli organismi del suolo. Dal punto di vista agronomico, ricopre grande importanza soprattutto nella nutrizione vegetale e nel miglioramento della struttura del suolo. Favorire l’accumulo di carbonio organico nei suoli è anche una delle misure indicate dall’UE per proteggere e ripristinare i suoli con l’obiettivo di tutelare l’ambiente e la salute umana e di mitigare gli effetti del cambiamento climatico. Le pratiche di gestione agronomica che riducono la mineralizzazione della sostanza organica rendono il suolo un serbatoio di carbonio e contribuiscono a ridurre le emissioni di CO2. L’analisi più comune è quella del carbonio organico totale (TOC) da cui si ricava la sostanza organica semplicemente dividendo il valore ottenuto per 0,58 (essendo la sostanza organica composta mediamente per il 58% da C).
Il metodo attualmente più rapido, preciso e sicuro prevede l’analisi del carbonio totale dopo combustione a circa 1.000 °C mediante l’utilizzo di un analizzatore elementare. A questo si sottrae il carbonio inorganico, analizzato separatamente, per ottenere il carbonio organico. Oltre al carbonio organico totale è possibile riconoscere e determinare differenti frazioni e forme di carbonio separabili con metodi chimici o fisici.
In particolare, il carbonio organico si divide in una frazione ossidabile fino a 400 °C (TOC400) e una frazione detta carbonio ossidabile residuo
(ROC), ossidabile tra i 400 e i 600 °C. La prima è la frazione più facilmente degradabile, la seconda è più stabile. Questa analisi (descritta dal metodo internazionale UNI EN 17505:2024) è da qualche anno applicata anche nel Laboratorio chimico della FEM, che dispone di una strumentazione in grado di operare la combustione in un gradiente di temperatura. La frazione detta Particulate organic matter (POM) comprende le particelle di sostanza organica (es. residui parzialmente decomposti, ife, ecc.) di dimensioni comprese tra 0,053 e 2 mm. È una frazione considerata labile e degradabile dai microorganismi a differenza della sostanza organica più fine generalmente legata alla frazione minerale per formare macroaggregati e protetta quindi dalla degradazione. Viene descritta come un indicatore della qualità del suolo. Il POX-C è la frazione di carbonio ossidabile con permanganato. Vari studi indicano che il suo contenuto varia con le diverse pratiche di gestione del suolo (es. aratura, concimazione) ed è significativamente correlato al carbonio della biomassa microbica e alla respirazione del suolo. Per questo viene considerata come un indice indiretto dell’attività microbica ed è associata ad un suolo in buona salute e fertile. Presso la FEM, grazie alla collaborazione tra diversi gruppi di lavoro, sono in corso delle sperimentazioni per capire l’impatto di varie pratiche agronomiche e l’uso di ammendanti sulla variazione dei contenuti delle varie forme di carbonio.

IRRITRE: irrigazione di precisione per una gestione idrica consapevole in Trentino
IRRITRE è un progetto territoriale nato nel 2023 su impulso della Provincia Autonoma di Trento con l’obiettivo di rendere più efficiente l’uso della risorsa irrigua in agricoltura. L’obiettivo del progetto è introdurre tecniche e strumenti di irrigazione di precisione che permettano ai Consorzi di ridurre gli sprechi d’acqua garantendo al tempo stesso la produttività. I partner dell’iniziativa sono la Fondazione Edmund Mach, la Fondazione Bruno Kessler e Trentino Digitale.
La sperimentazione è stata avviata in tre aree pilota, diverse per coltura e clima: Tres in Val di Non per il melo, Roverè della Luna in Piana Rotaliana per la vite e Varone nella Valle del Sarca per l’olivo. In ciascuna di queste zone lo stato idrico del suolo è stato monitorato con sensori collocati a diverse profondità, in base alle caratteristiche dei terreni e della coltura. Parallelamente, i consumi idrici sono stati rilevati da contatori installati sulle valvole principali, fornendo dati essenziali per rendicontare a fine stagione l’utilizzo effettivo dell’acqua. Tutte queste informazioni alimentano e validano il modello SWAB (Soil Water Atmosphere Advanced Budget), sviluppato in FEM, che stima il bilancio idrico del suolo, considerando i fabbisogni delle piante, le irrigazioni effettuate, le fasi fenologiche delle colture, le condizioni climatiche e l’andamento meteorologico dell’annata. SWAB costituisce il cuore del consiglio irriguo, lo strumento che supporta i Consorzi
nel passaggio da una gestione irrigua “a calendario” ad un approccio dinamico, basato sulle necessità giornaliere delle colture.
Dal punto di vista operativo, IRRITRE si traduce in una piattaforma informatica che integra tutte le informazioni necessarie per pianificare gli interventi irrigui, ad uso dei Consorzi. I quantitativi d’acqua vengono calcolati sulla base delle proprietà idrauliche e allo stato idrico del suolo, delle precipitazioni, delle condizioni atmosferiche e delle irrigazioni precedenti. Il bilancio viene poi proiettato nel futuro utilizzando le previsioni meteorologiche, fornendo differenti scenari irrigui. La piattaforma consente inoltre di visualizzare gli andamenti delle sonde di umidità del suolo, offrendo una lettura immediata di come varia il contenuto idrico nei diversi strati di terreno in funzione delle piogge e delle irrigazioni.
Le attività svolte nei tre siti pilota hanno permesso di adattare il sistema alle esigenze concrete dei Consorzi coinvolti. La prospettiva è di estendere la piattaforma, rafforzando il legame tra enti del trasferimento tecnologico e gestori della risorsa idrica. La vera innovazione risiede proprio in questa capacità di adattamento: portare IRRITRE in contesti pedologici, climatici e colturali diversi significa aprire nuove strade per l’ottimizzazione dell’uso dell’acqua irrigua, contribuendo ad un uso più sostenibile e strategico della risorsa idrica trentina.


L’annata frutticola
MATTEO DE CONCINI
Il germogliamento e le fasi fenologiche iniziali del melo, nell’annata frutticola 2024, si sono verificati con un andamento allineato a quello osservato nel 2023. Tuttavia, i cambiamenti climatici stanno impattando in maniera significativa soprattutto sul momento di schiusura delle gemme: la data media dello stadio di punte verdi registrata nel quinquennio 2020-2024 è avvenuta con 4-5 giorni di anticipo rispetto al decennio 20102020, analogamente alla data di inizio fioritura. Inoltre, si è osservato che gli anticipi vegetativi sono più marcati in quota: negli ultimi anni si riscontra infatti una scarsa dilazione degli stadi fenologici alle diverse quote per cui anche areali frutticoli di alta collina presentano stadi avanzati nei mesi di marzo e aprile, rendendoli più esposti al rischio di gelate primaverili.
Il 2024 è stato caratterizzato da precipitazioni abbondanti e decisamente più alte della media. Questo ha influenzato in maniera importante lo sviluppo di diversi patogeni, in primis la ticchiolatura. In occasione delle consistenti piogge di fine marzo si sono pertanto verificati elevati voli ascosporici che hanno determinato gravi infezioni di ticchiolatura. Il risultato delle strategie di difesa consigliate è stato condizionato da vari fattori: aggressività del patogeno, difficoltà o impossibilità di accesso in sicurezza negli appezzamenti per le eccessive piogge, dilavamento sia dei prodotti preventivi che di quelli applicati in finestra di germinazione. A fine primarie, il 40% dei frutteti non presentava attacchi di ticchiolatura, il 30% presentava un attacco contenuto e il restante 30% un attacco più rilevante (con più del 5% di germogli colpiti da
ticchiolatura). La stagione primaverile è stata inoltre caratterizzata da un evento di gelata di media entità, avvenuto la mattina del 25 aprile. Le conseguenze di questi abbassamenti termici sono state localmente impattanti soprattutto dal punto di vista qualitativo, con presenza di frutti cinghiati e rugginosi. I danni quantitativi sono stati limitati a poche aree frutticole, e solitamente localizzati nella parte bassa delle piante, che hanno generalmente compensato con una maggior produzione sulle cime.
Le piogge hanno caratterizzato anche l’ultima parte della stagione, condizionando le operazioni di raccolta della frutta. Le piogge hanno inoltre favorito, a partire dalla metà di agosto, la diffusione della Glomerella negli areali di fondovalle a sud di Trento e in Valle dei Laghi. In diversi frutteti anche la presenza di fumaggini è stata riscontrata con percentuali di attacco significative.
Le condizioni meteo fresche e piovose hanno invece ostacolato la proliferazione degli insetti dannosi.
La difesa dagli afidi è stata influenzata dalle condizioni di applicazione dei
prodotti fitosanitari spesso avverse; tuttavia, dove si è riusciti ad intervenire con strategie adeguate il risultato è stato buono. La presenza di cimice asiatica nei frutteti è stata in linea con quella delle annate precedenti. Si conferma come gli areali di maggior diffusione di questo insetto siano quelli di fondovalle, in particolare a sud di Trento. A fine annata, pur registrando una generale buona riuscita della strategia di difesa, localmente si sono osservati danni anche rilevanti.
La produzione è stata buona in termini quantitativi, ma le condizioni meteo avverse durante la fase di raccolta hanno parzialmente inficiato la qualità dei frutti che in molti casi presentavano ammaccature, fumaggini, altri marciumi da conservazione e avanzato stato di maturazione.
A fine stagione si è confermato un deciso aumento della problematica degli scopazzi dovuto, oltre all’aumentare dell’età media degli impianti e alla presenza di frutteti incolti o mal gestiti, anche alla scarsa attenzione dei frutticoltori nell’estirpo di tutte le piante sintomatiche e nel trattare con puntualità gli insetti vettori.


Life Cycle Assessment delle forme di allevamento del melo: caso studio su spindle e guyot
MOE THAE OO*
DAMIANO MOSER
FRANCO MICHELI
* Dottoranda Università degli Studi di Padova
Come tutti i processi produttivi, anche la coltivazione delle mele genera una serie di effetti alteranti sull’ambiente in termini di utilizzo delle risorse energetiche e di materie prime. In questo studio, è stato misurato l’impatto ambientale del meleto utilizzando l’approccio della Life Cycle Assessment (LCA), che – conformemente a standard internazionali ISO 14040 e 14044 – analizza tutte le fasi del ciclo produttivo (compresi, ad esempio, la realizzazione, l’utilizzo e lo smaltimento dei mezzi meccanici impiegati), ed ha permesso di individuare gli “hotspots” per sviluppare strategie di mitigazione. Sono stati confrontati sistemi di allevamento spindle e guyot mediante un’analisi “cradle-to-farm-gate”, ossia considerando tutti gli aspetti che
possono avere un impatto ambientale, a partire dai mezzi necessari alla produzione fino alla fase di raccolta. I dati primari sono stati raccolti presso un vivaio, sei frutticoltori che adottano entrambi i sistemi di allevamento e l’azienda sperimentale FEM. I dati secondari, relativi alla produzione di macchine e dei vari input, sono stati reperiti da database aggiornati da enti di riferimento internazionali. L’unità funzionale considerata è stata di un ettaro, analizzato mediante il metodo di valutazione EF 3.1, adottato dai più diffusi software utilizzati per LCA, con focus sul cambiamento climatico (emissioni di CO2 equivalenti) e sulla domanda cumulativa di energia (CED).
I risultati indicano che l’impronta di
carbonio per un ettaro di melo è pari a 3.693 kg CO2eq nel sistema Spindle e 3.110 kg CO2eq nel sistema guyot (Figura 1). I principali contributori alle emissioni sono risultati il gasolio (789 kg CO2eq per lo spindle e 787 kg CO2eq per il guyot) e i fertilizzanti chimici (728 kg CO2eq e 708 kg CO2eq, rispettivamente), insieme all’utilizzo delle trattrici agricole e all’irrigazione. Le minori emissioni del sistema guyot derivano da una riduzione nell’impiego di agrofarmaci, delle piattaforme elettriche grazie all’architettura semplificata della pianta e alla riduzione delle piante per ettaro. Tuttavia, il sistema guyot ha registrato emissioni superiori per quanto riguarda le componenti strutturali dell’impianto. Analogamente, la CED totale è risultata pari a 105 MJ per lo spindle contro 94 MJ per il guyot, con una dipendenza superiore al 90% da fonti non rinnovabili (Figura 2a). In entrambi i sistemi, il gasolio e i fertilizzanti sono stati i maggiori contributori non rinnovabili, rappresentando oltre il 48% e il 12-14% rispettivamente. Il contributo da car-
ro raccolta elettrico è stato maggiore nel sistema spindle (12,5%) rispetto al guyot (5,3%) (Figura 2b).
I risultati raccolti suggeriscono che la scelta del sistema di allevamento influenza in modo sostanziale l’impronta ambientale della melicoltura offrendo un’alternativa più sostenibile, in virtù di emissioni di carbonio e consumi energetici ridotti ed un conseguente utilizzo più efficiente di gasolio e agrofarmaci. È importante considerare che lo studio si è potuto avvalere di poche aziende, storicamente orientate al sistema spindle e non adattate a meleti guyot; futuri studi di simulazione LCA potrebbero valutare come l’ottimizzazione del parco macchine resa possibile da un pieno adattamento al guyot potrebbe amplificare i benefici ambientali ed economici osservati. Lo studio rientra in un percorso di dottorato nell’ambito del progetto PNRR i-NEST, svolto presso l’Unità Bioeconomia FEM-CRI in collaborazione con l’Unità Sperimentazione in frutticoltura CTT.
Figura 1
Impronta di carbonio di un ettaro di melo nei due sistemi di allevamento
Elettricità
Strutture di sostegno
Irrigazione Piante di melo
Prodotti fitosanitari Regolatori di crescita
Letame bovino
Gasolio
Concimi minerali
Piattaforma di sollevamento (elettrica)
Trattori e macchine agricole
Figura 2
Domanda cumulativa totale di energia (CED) (a) e percentuale di contributo degli input alla CED per un ettaro di melo nei due sistemi di allevamento (b)
Trattori e macchine agricole
Piattaforma di sollevamento (elettrica) Gasolio
Concimi minerali Letame bovino
Prodotti fitosanitari Regolatori di crescita
Elettricità

Glomerella Leaf Spot e Apple Bitter Rot
MATTEO DE CONCINI
VALERIA GUALANDRI
Glomerella Leaf Spot è una malattia fungina conosciuta, fino a pochi anni fa, solo in Sud America e nel sud-est asiatico. Nel 2019 ha fatto la sua comparsa in Italia, prima in Emilia-Romagna e Veneto, per poi diffondersi rapidamente anche nelle altre regioni del nord Italia.
L’agente causale della sintomatologia conosciuta come GLS è un complesso di funghi appartenente al genere Colletotrichum. Tale genere rappresenta a livello mondiale uno tra i 10 principali funghi patogeni per le piante. Sono attualmente conosciute 344 specie di Colletotrichum distribuite in 20 complessi, tra questi quelli di maggior interesse sono il complesso Colletotrichum acutacum e C. gleosporiodes. All’interno di questi due complessi esistono diverse specie fungine in grado di provocare due principali sintomatologie identificate come Glomerella Leaf Spot (GLS) e Apple Bitter Rot (ABR). Quest’ultima, conosciuta da sempre come marciume amaro della polpa dei frutti, è una malattia tipica della fase di conservazione. Caratterizzata da marciumi estesi con tipica sporulazione color salmone del fungo, è presente sul nostro territorio da diversi anni. Al contrario, GLS è una sintomatologia nuova che si sta diffondendo in maniera molto veloce nei nostri ambienti. GLS è comparsa per la prima volta in Trentino dal 2021 quando si sono osservati i primi sintomi su frutto mentre, a partire dal 2022, è stata diagnosticata in laboratorio sia sui frutti che sulle foglie. Nel 2023 questa patologia si è diffusa soprattutto nelle zone della Val d’Adige a sud di Trento e in Valle dei Laghi, con frutteti che a fine stagione presentavano defogliazioni importanti. GLS si manifesta inizialmente con lesioni ne-

crotiche violacee sulle foglie che progrediscono espandendosi in macchie necrotiche di colore marrone (Foto 1 e 2). Nei casi più gravi si può ottenere la totale defogliazione della pianta. Sui frutti possono comparire piccole macchie marroni circolari e infossate generalmente centrate sulle lenticelle che li rendono non commercializzabili (Foto 3). Condizioni predisponenti l’infezione sono una prolungata bagnatura e temperature superiori ai 20 °C. In questi casi l’evoluzione dei sintomi può essere molto rapida, infatti, nel giro di pochi giorni si possono riscontrare elevate percentuali di frutti colpiti. Nel corso del 2024, in 3 areali considerati ad alto rischio è stato attivato un monitoraggio specifico con la raccolta di numerosi campioni di foglie e frutti provenienti da impianti con sintomi sospetti. Le analisi di laboratorio hanno confermato la presenza del complesso fungino del Colletotrichum sul materiale raccolto in campo a partire da metà agosto; tuttavia, soltanto il 20% dei campioni sono risultati positivi, il restante 80% erano sintomi causati principalmente da squilibri fisiologici con presenza di altri funghi saprofiti. Sempre nello stesso anno è stato inoltre attivato un monitoraggio aerobico per verificare i momenti di infezione del fungo posizionando un captaspore in un frutteto con forte inculo. Contestualmente si è provveduto a testare le migliori strategie di difesa da adottare nei frutteti potenzialmente esposti a questa problematica. Da una prima analisi è emerso come sia fondamentale
adottare una attenta gestione agronomica del frutteto al fine di mitigare i fattori che possono portare allo sviluppo di questa patologia: sfalciare frequentemente il cotico erboso, evitare l’irrigazione sovrachioma e ridurre tutte le condizioni che prolungano la durata della bagnatura e aumentano il tasso di umidità. L’impiego di alcuni fungicidi, se applicati con attenzione prima degli eventi piovosi, riesce nella maggior parte dei casi a limitare il progredire di questa malattia. Tuttavia, preoccupano per il prossimo futuro le condizioni climatiche sempre più favorevoli allo sviluppo di questo fungo, e la ridotta disponibilità di molecole in grado di contrastarlo. La Fondazione Mach è impegnata in un gruppo di lavoro interregionale con diversi enti tecnico scientifici, con l’obiettivo di meglio comprendere la biologia e l’epidemiologia di questo nuovo patogeno, fondamentali per sviluppare strategie di difesa efficaci e sostenibili.

Foto 2
Sintomi iniziali di GLS su foglie di melo cv Rosy Glow visibili da fine giugno
Foto 3
Sintomi di GLS su frutto di Pink Lady

Colpo di fuoco batterico del melo: quattro anni di monitoraggio dopo l’epidemia del 2020
SACHA BARGNA
VALERIA GUALANDRI
MATTIA ZAFFONI
MARIO BALDESSARI
Fire blight of apple: four years of monitoring after the 2020 outbreak
Fire blight, caused by Erwinia amylovora, affects apple, pear and other members of the family Rosaceae, including ornamental and forest species. The bacterium spreads through weather events, pollinating insects, and contaminated pruning tools. In 2020, a severe outbreak affected the apple-growing sector in Trentino, particularly in the Valsugana area. In the following years, its spread was progressively contained through the removal and sanitation of infected orchards, systematic monitoring, and awareness campaigns targeting farmers and the public. The endemic presence of E. amylovora in Valsugana and the central-eastern area of Val di Non makes regular orchard monitoring essential, especially during flowering and early summer, to prevent new outbreaks and ensure the sustainability of the provincial fruit production.
Il colpo di fuoco è una grave malattia batterica causata da Erwinia amylovora, che colpisce numerose specie di Rosaceae, sia coltivate – in particolare melo e pero – che spontanee e orna-
mentali. Originario del Nord America, il batterio si è diffuso nel corso del Novecento ed è oggi presente in oltre 50 Paesi (EPPO 2022 EPPO Bull. 52(2):198–224). Il ciclo infettivo ha ini-
zio in primavera, quando E. amylovora fuoriesce dai cancri corticali – sedi di svernamento del patogeno – sotto forma di essudato, contenente elevate concentrazioni di cellule vitali.
L’inoculo primario viene disperso principalmente da agenti atmosferici (pioggia, vento, grandine) e da insetti impollinatori. Anche l’attività antropica, in particolare l’uso di strumenti di potatura contaminati, può favorire la trasmissione del batterio da piante infette a piante sane.
Una volta raggiunta una nuova pianta ospite, E. amylovora penetra attraverso ferite o aperture naturali, in particolare i fiori, diffondendosi nei tessuti vegetali. Fiori, frutti e foglie disseccano, rimanendo mummificati sulla pianta, mentre i germogli apicali possono ripiegarsi ad uncino, sintomo caratteristico della malattia. Sugli organi legnosi si formano cancri corticali irregolari e leggermente depressi, accompagnati da imbrunimento dei tessuti sottostanti. Infine, viscoso essudato batterico può fuoriuscire da cancri, frutti o ferite, fungendo da fonte di inoculo secondario durante l’estate.
In primavera, l’avvio delle infezioni primarie richiede che le condizioni climatiche soddisfino alcuni requisiti minimi: temperatura media giornaliera di ≥15,6 °C, accumulo di 110 gradi-giorno >18 °C a partire da inizio fioritura e precipitazione ≥ 0,25 mm (Steiner 1990 Acta Hort. 273:139-148).
Epidemia in Trentino nel 2020: impatto e strategie di contenimento
In Trentino, il colpo di fuoco batterico rappresenta una seria minaccia per il comparto melicolo, che si estende su circa 10.000 ettari. Gli impianti di recente messa a dimora risultano particolarmente suscettibili, a causa della fioritura posticipata, rispetto a quelli adulti. Questo ritardo fenologico espone i fiori a condizioni meteo più favorevoli al patogeno – temperature miti e precipitazioni generalmente più abbondanti – che agevolano la colonizzazione dei tessuti da parte di E. amylovora
Una delle più gravi epidemie degli ultimi anni si è verificata nel 2020; in particolare il distretto frutticolo della Valsugana è stato il più colpito, con centinaia di frutteti infettati. In misura minore, l’epidemia ha interessato anche Val di Non, Val d’Adige e Valle del Sarca e, complessivamente, in Provincia sono stati accertati oltre 600 appezzamenti con piante sintomatiche. Oltre a questi, sono stati riscontrati diversi casi anche su piante ornamentali e spontanee (biancospino, piracanta, cotognastro) e un caso su Rosa canina. Per contenere l’evento epidemico, la Fondazione Edmund Mach insieme all’Ufficio Fitosanitario Provinciale ha avviato sul territorio un’intensa attività di monitoraggio. A questo si è affiancata la campagna di sensibilizzazione rivolta alla cittadinanza e l’attività di consulenza tecnica con avvisi ed incontri rivolti agli agricoltori per consigliare le migliori pratiche da adottare per la corretta gestione del colpo di fuoco. La necessità di raggiungere e coinvolgere velocemente un numero elevato di persone ha inoltre portato alla creazione del sito //fitoemergenze.fmach.it dove sono disponibili materiale iconografico e informazioni importanti per riconoscere e gestire la malattia. Il contenimento del patogeno si basa principalmente sull’estirpo delle piante gravemente colpite. Solo nei casi più lievi è prevista la tempestiva rimozione del materiale vegetale infetto con tagli eseguiti almeno 70 cm al di

Foto 1
Cancri corticali causati da Erwinia amylovora su tronco di melo
sotto del margine visibile dei sintomi, seguiti da bruciatura in loco e disinfezione degli strumenti di potatura.
A queste pratiche si affiancano interventi fitosanitari preventivi: in prefioritura, l’applicazione di prodotti a base di fosetyl-Al e acibenzolar-S-metile rafforza le difese naturali delle piante, mentre in fioritura l’impiego di microrganismi antagonisti – Bacillus subtilis, Bacillus amyloliquefaciens e Aureobasidium pullulans – contrasta l’infezione agendo per competizione sugli organi fiorali. Nei mesi estivi e autunnali, trattamenti rameici su varietà poco sensibili alla rugginosità contribuiscono a ridurre l’inoculo presente in campo. Infine, l’impiego di modelli previsionali, in grado di stimare il rischio di infezione in base a temperatura, umidità e

carica batterica, ha reso più efficace la gestione dell’epidemia, migliorando la programmazione dei trattamenti e indirizzando il monitoraggio verso le aree a maggior rischio.
Monitoraggio 2021-2024
L’attività di monitoraggio, dal 2021 al 2024, ha riguardato principalmente i nuovi impianti di melo e, in misura minore, quelli maturi e gli impianti di pero, con l’obiettivo di individuare tempestivamente eventuali infezioni e contenere la diffusione del patogeno.
Nel 2021 sono stati monitorati 110,64 ettari, distribuiti nei principali distretti frutticoli trentini: Valsugana, Val di Non, Val di Sole, Val d’Adige e Valle del Sarca. Sono stati rilevati 45 casi sintomatici (ovvero appezzamenti con almeno una pianta infetta), di cui 33 in Valsugana – uno su biancospino ornamentale – e 12 tra Val di Non e Val di Sole.
Nel 2022 il monitoraggio è stato concentrato nelle aree già colpite l’anno precedente, registrando un nuovo incremento dei casi. Dei 126 appezzamenti sintomatici rilevati, 61 sono stati individuati in Valsugana e 65 in Val di Non e Sole, 47 dei quali localizzati nell’areale centro-orientale della Val di Non, con epicentro nella zona di Coredo.
Nel 2023, a seguito della segnalazione di un frutteto gravemente colpito nel

Comune di Aldeno, il monitoraggio è stato esteso anche in questa zona della Val d’Adige. Complessivamente sono stati controllati in Provincia 89,22 ettari, nei quali sono stati riscontrati 10 casi: 1 in Valsugana, 7 nell’areale centro-orientale della Val di Non e 2 in Val d’Adige. Nel 2024 è stato rilevato 1 solo caso in Valsugana, 6 in Val di Non (di cui uno in foresta su biancospino), mentre nessun caso in Val d’Adige; per una superficie monitorata complessiva di 16,91 ettari.
Bilancio e prospettive nella gestione del colpo di fuoco batterico Dopo l’evento epidemico del 2020, l’incidenza del colpo di fuoco è progressivamente diminuita, raggiungendo nel 2024 livelli gestibili per il comparto frutticolo. I drastici interventi di pulizia ed estirpazione degli impianti, affiancati da una capillare campagna di sensibilizzazione e da
un costante controllo del territorio, hanno limitato la formazione di nuovi focolai. La presenza endemica di E. amylovora in Trentino, unita alla sua rapida diffusione in condizioni climatiche favorevoli, rende indispensabile una vigilanza continua. Monitorare regolarmente i frutteti, soprattutto durante la fioritura e l’inizio dell’estate, segnalare sintomi sospetti e rimuovere tempestivamente le piante infette con bruciatura in loco resta la strategia più efficace. Inoltre, è anche importante controllare le piante ospiti secondarie, potenziali fonti di inoculo sul territorio.
Per prevenire il ripetersi di epidemie simili, è necessario un approccio integrato che combini sorveglianza costante, campagne di sensibilizzazione e partecipazione attiva dei produttori, con particolare attenzione agli areali della Valsugana e della Val di Non centro-orientale, dove il patogeno risulta maggiormente diffuso.
Foto 3
Bruciatura in loco del materiale infetto rimosso da un impianto di melo durante l’epidemia del 2020 in Valsugana

La sorveglianza fitosanitaria è un’attività di prevenzione fondamentale per evitare o limitare l’insediamento e la diffusione di organismi esotici nocivi per le piante che potrebbero causare gravi ripercussioni economiche, ambientali e sociali.
SACHA BARGNA
Sorveglianza fitosanitaria in Trentino: difendere colture ed ecosistemi da specie aliene invasive
La sorveglianza fitosanitaria ha lo scopo di prevenire l’insediamento e la diffusione di organismi esotici nocivi per le piante. Una volta introdotti, potrebbero sopravvivere e moltiplicarsi, alterando l’equilibrio degli ecosistemi locali e causando gravi ripercussioni economiche, ambientali e sociali. L’Unione Europea attribuisce a questa attività un ruolo strategico: specifici Regolamenti stabiliscono le misure di protezione e impongono agli Stati membri monitoraggi sistematici attraverso ispezioni visive, trappolaggi, campionamenti e analisi di laboratorio. In Italia la competenza ricade sui Servizi Fitosanitari Regionali e, in Trentino, la Fondazione Edmund Mach collabora attivamente svolgendo rilievi in campo e analisi diagno-
stiche sui campioni raccolti. L’assenza di porti e aeroporti commerciali, unita alle caratteristiche orografiche del territorio, riduce il rischio di introduzione di organismi esotici; tuttavia, scambi di merci, flussi turistici e movimentazione di piante e materiali vegetali restano tra i principali canali di ingresso e diffusione di specie aliene, rendendo necessaria una costante vigilanza sul territorio. Tra gli organismi da quarantena rinvenuti in Trentino nel corso degli anni figurano i nematodi cisticoli della patata Globodera pallida e Globodera rostochiensis. Originari del Sud America, sono stati introdotti in Europa a metà Ottocento attraverso il commercio di patate da seme e, in Italia, sono diffusi in gran parte delle aree vocate alla
coltivazione delle solanacee. I sintomi sono aspecifici e comprendono ingiallimenti, avvizzimenti e necrosi fogliari, generalmente localizzati in alcune aree del campo. Le piante mostrano spesso ritardi vegetativi e i tuberi una pezzatura ridotta, con conseguenti perdite produttive. In Trentino, questi due nematodi sono stati segnalati a partire dal 2021 in diversi areali della porzione occidentale della Provincia, storicamente vocata alla produzione di patate.
Negli ultimi anni desta particolare attenzione Popillia japonica, insetto da quarantena originario dell’Asia nord-orientale e considerato di importanza prioritaria per l’Unione Europea. Altamente polifago, è temuto per i danni che può provocare a colture, piante ornamentali e specie forestali. In Italia, il primo focolaio è stato identificato nel 2014 nel Parco del Ticino e, dopo aver colonizzato vaste aree di Lombardia e Piemonte, si è diffuso anche in Emilia-Romagna, Valle d’Aosta e Friuli-Venezia Giulia. Nel 2023, per la prima volta in Trentino, un esemplare di Popillia japonica è stato catturato in una trappola presso l’area di servizio autostradale di Nogaredo. A seguito di questa intercettazione, la rete di monitoraggio è stata potenziata tramite
l’installazione di trappole aggiuntive lungo l’intera direttrice autostradale. Strade, autostrade e luoghi ad alta frequentazione turistica e commerciale sono considerate aree critiche: l’insetto può infatti essere veicolato dai mezzi di trasporto per lunghe distanze e originare nuovi focolai in zone ancora indenni. Sebbene nel 2023 non siano state registrate ulteriori catture, il monitoraggio rafforzato è proseguito nel 2024. A luglio, sette individui sono stati intercettati nelle trappole posizionate presso le stazioni di servizio autostradali di Nogaredo e Lavis. Indagini condotte per l’intero periodo di volo nelle aree circostanti i siti di ritrovamento non hanno però rilevato alcun focolaio né danni sulla vegetazione riconducibili a Popillia japonica. I ritrovamenti ripetuti negli anni confermano la capacità dell’insetto di diffondersi passivamente e il ruolo delle autostrade nella sua dispersione sulla lunga distanza. La prevenzione rimane la strategia più efficace per intercettare precocemente nuove introduzioni: informazione, sorveglianza costante, trappole attrattive e ispezioni mirate delle aree critiche sono strumenti essenziali per mantenere il territorio indenne e scongiurare la comparsa di eventuali focolai.

Foto 2
Danno da P. japonica su vite

Le mele a polpa rossa necessitano di un limitato numero di trattamenti per il contenimento delle malattie fungine e rappresentano un’alternativa sostenibile alle varietà tradizionali a beneficio dell’ambiente, dei produttori e dei consumatori.
LORENZO TURRINI
FABIO ZENI
ALESSANDRO PEDERGNANA
SARAH GIRARDI
MILENA VALENTINI
DARIO ANGELI
Mele a polpa rossa: lo sviluppo di nuove selezioni passa anche da una buona conservabilità
Red-fleshed apples: the development of new varieties also depends on good preservation
Red-fleshed apples, known for their resistance to scab, provide a sustainable alternative for differentiating the offer. The attractive red flesh color tends to develop more brownish hues with prolonged or inadequate storage. In this study, a new selection of red-fleshed varieties was chosen to test storage strategies designed to reduce browning. Controlled atmosphere (CA) storage exhibited the best storage performance, using the plant growth regulator 1-MCP, which allowed for good maintenance of the original color for a duration of six months in storage. The 1-MCP treatment also yielded excellent results in maintaining firmness, acidity, and juiciness, and in reducing rot. Better storage results were also observed for early harvests.
In un contesto di stagnazione dei consumi che caratterizza l’intero settore ortofrutticolo, la mela rimane il frutto più consumato dagli italiani, che nel 2022 e nel 2023 lo hanno preferito a banane e arance, anch’essi sul podio dei frutti più ap-
prezzati. Il rifornimento dei consumatori avviene in prevalenza tramite la Grande Distribuzione Organizzata che ne commercializza il 78% (Bosi e Lodi, 2024, Rivistafrutticoltura.edagricole.it). Nei supermercati, però, non c’è spazio a sufficienza per tutte le re-
ferenze e per i numerosi nuovi brand che devono pertanto essere attrattivi e differenziarsi. I consumatori sono inoltre sempre più consapevoli dei benefici del consumo di frutta e dimostrano conoscenze sui nutrienti (es. fibre, vitamine, polifenoli) e sul loro impatto sulla salute (Ceci et al. 2021 Metabolites 11:378; Catalán et al. 2022 Nutrients 14:1047).
Le cultivar di mele a polpa rossa con un maggiore contenuto di antociani hanno recentemente attirato l’interesse degli acquirenti di mele grazie non solo all’aspetto attraente, ma anche ai loro benefici per la salute. Per i produttori, le selezioni a polpa rossa si potrebbero rivelare un’alternativa interessante, per i potenziali riscontri commerciali e per il contenimento degli interventi fitosanitari necessari.
Le mele a polpa rossa possono essere suddivise in due gruppi. Il Tipo 1 comprende genotipi di colore scuro, fortemente pigmentati in cui il colore rosso della polpa si forma in una fase precoce della stagione e la pigmentazione interessa anche fiori e vegetazione. I genotipi appartenenti al Tipo 2 sono di colore meno intenso e la colorazione rossa subentra tardi e non interessa le altre parti della pianta. In questo studio è stata analizzata una nuova selezione di mela a polpa rossa di Tipo 1 al fine di monitorarne i cambiamenti qualitativi che avvengono in conservazione e testare alcune condizioni di conservazione.
I frutti sono stati raccolti in tre diverse epoche da due frutteti coltivati secondo il Disciplinare di produzione integrata. I frutti sono stati conservati a bassa temperatura (1,5 °C) e atmosfera controllata (AC) (O2: 1,2-1,4%, CO2: 1,0%) con due modalità: non trattato (C) e trattato con 1-mcp (1-MCP)
(SmartFresh, Agrofresh, Italia). Alla raccolta e dopo 6 mesi di conservazione le mele sono state pesate per monitorare il calo peso e analizzate, con l’uso del laboratorio automatico Pimprenelle, per la misura di contenuto zuccherino, compattezza della polpa, acidità titolabile e succosità. Sugli stessi frutti è stato misurato il colore della buccia con l’uso del colorimetro CR Chroma Konica Minolta Sensing. Alcuni dei frutti raccolti sono stati monitorati anche per il tasso di rilascio di etilene. A fine conservazione è stata inoltre effettuata l’osservazione visiva esterna e interna delle mele per rilevare marciumi ed imbrunimento interno. Le analisi e lo stoccaggio sono stati svolti al laboratorio della Fondazione Mach (Tabella 1).
Le mele hanno dimostrato un elevato potenziale di conservazione e i parametri di qualità dopo sei mesi in condizioni di AC sono risultati ottimi. Le mele coltivate in fondovalle (Nave San Rocco) sono risultate più dolci e meno acide di quelle di collina (Cunevo). Per consistenza e succosità della polpa non sono state rilevate differenze evidenti. In tutte le condizioni testate le mele trattate con 1-mcp sono risultate più compatte, più acide e più succose, mentre non si sono evidenziate differenze per il contenuto zuccherino (Figura 1).
Nel presente studio, il rilascio di etilene nei frutti è risultato sempre inferiore a 0,2 mg/kg/h a temperatura ambiente ed è diminuito gradualmente durante la maturazione (Figura 2).
La perdita di peso della mela in conservazione è risultata variabile tra il 2,5 e il 4,0%, con risultati migliori sulle raccolte precoci (-7), mentre 1-mcp non si è differenziato dal controllo (Figura 2).
Tabella 1
Epoca di raccolta, indice di amido e qualità organolettica interna dei frutti genotipo “Tipo 1” nei due frutteti alla raccolta 2023
Figura 1
Qualità intrinseca delle mele dopo 6 mesi di conservazione in AC e 7 giorni di shelflife a 20 °C. Sono rappresentate mele non trattate (C) e trattate (1-MCP). Lettere diverse su frutti sani rappresentano differenze significative a p < 0,05
Figura 2
Etilene (mg/kg/h) prodotto dai frutti dopo la raccolta e perdita di peso dopo 6 mesi di conservazione in atmosfera controllata e temperatura di 1,5 °C. Sono rappresentate mele non trattate (C) e trattate (1-MCP).
Lettere diverse su frutti sani rappresentano differenze significative a p < 0,05.
La percentuale di pigmentazione rossa della buccia è risultata adeguata, coprendo quasi tutta l’epidermide in entrambi i frutteti senza differenze tra le condizioni di conservazione testate. L’intensità del colore è risultata maggiore in collina (Cunevo) e sulle raccolte tardive. La pigmentazione interna è risultata buona in entrambi i frutteti e in tutte le epoche di raccolta; la colorazione interessa spesso sia il cuore che il mesocarpo (Foto 1).
Dal controllo visivo a fine conservazione si è rilevata un’alta sensibilità ai marciumi e all’imbrunimento per tutte le epoche di raccolta, con solo lievi differenze tra i frutteti. Le mele con un indice di amido più elevato sembrano essere più sensibili. È interessante
notare i potenziali benefici dell’1-mcp nel ridurre i marciumi e l’imbrunimento grazie al rallentamento che induce nella maturazione (Tabella 2).
In conclusione, le mele a polpa rossa possiedono un eccezionale appeal visivo, proprietà organolettiche e un profilo di metaboliti ricco di composti benefici per la salute. In questa sperimentazione, la conservazione a bassa temperatura associata ad atmosfera controllata e 1-mcp ha consentito una buona tenuta della polpa e un importante contenimento delle tipiche problematiche delle varietà a polpa rossa, quali imbrunimenti e marciumi. Relativamente all’epoca di raccolta, si è notata una tendenza ad una migliore conservazione per le raccolte
precoci e peggiore per le tardive, seppur con dati incostanti. Ulteriori sperimentazioni saranno utili per massimizzare la conservabilità del prodotto di questa varietà di genotipo 1 e delle altre selezioni a polpa rossa presenti sul mercato.
Questo lavoro è stato finanziato

dal Programma Operativo Ricerca e Sviluppo dell’Organizzazione di Produttori (Reg UE 1305/2013) Consorzio Melinda Sca a Cles (TN), Italia IT143230011 - CUP C56B23000000004. Questo studio è stato realizzato anche con l’utilizzo di strutture della Provincia autonoma di Trento.

Tabella 2
Differenze tra trattato (1-MCP) e non trattato (C) nella presenza di marciumi e imbrunimento interno dopo sei mesi di conservazione in AC a 1,5 °C
Foto 1
Sovracolorazione rossa dell’epicarpo (a sinistra) e pigmentazione rossa interna con leggero imbrunimento marginale (a destra) su mele di Cunevo raccolte con indice di amido tardivo (3,0) dopo sei mesi di conservazione in AC

L’annata ciliegio e piccoli frutti 2024
TOMMASO PANTEZZI
L’annata 2024 per il ciliegio è stata caratterizzata da un’allegagione variabile in molti impianti della provincia, per alcuni eventi di gelate in alcuni areali più tardivi. In generale la quantità prodotta è stata comunque nella media, e anche la pezzatura è stata sufficiente. La qualità dei frutti invece non è stata molto elevata in termini di durezza e contenuto zuccherino, probabilmente a causa dell’andamento meteorologico durante la maturazione del frutto. Anche nel 2024 l’inverno mite e le temperature di inizio primavera sopra la media hanno indotto una precoce ripresa vegetativa, con un successivo rallentamento dello sviluppo durante i mesi di maggio e giugno, che sono stati più freschi e piovosi, rallentando la maturazione fino ad allineare la raccolta alle ultime annate. Fra le avversità di rilievo, va ricordata l’elevata pressione
di Drosophila suzukii, derivante dalla popolazione svernante consistente e favorita dall’inverno mite. Nel proseguire delle generazioni estive, l’insetto ha compromesso la raccolta negli impianti fuori rete di varietà tardive e, in qualche caso, si sono manifestati attacchi importanti in impianti sotto rete. Anche per la fragola, in particolare, e per i piccoli frutti coltivati senza rete antinsetto si sono registrate situazioni di gravi attacchi. Rilevante è stata anche la presenza di monilia a causa delle condizioni meteo di maggio e giugno, tanto che ha richiesto una deroga al numero massimo di interventi contro questo fungo; tuttavia, in alcuni casi si sono registrati danni anche applicando una difesa fitosanitaria puntuale. Per quanto riguarda fragola e piccoli frutti, dopo una normale ripresa vegetativa si è assistito ad un tempora-
neo rallentamento nei mesi di maggio e giugno, a causa delle temperature più miti e delle frequenti precipitazioni. Queste ultime hanno causato la comparsa di botrite sui frutti e, in particolare per mirtillo, sono stati segnalati dei casi di resistenza alla miscela di boscalid e pyraclostrobin. In autunno in alcune zone di fondovalle si è assistito, talvolta, a una ripartenza anomala di nuovi germogli su piante di mirtillo, probabilmente legata alle irregolarità climatiche della stagione e, in altre situazioni, alla presenza importante di cecidomia su piante giovani.
L’andamento della fragola è variato a seconda del periodo e della tipologia, distinguendo tra varietà unifere e rifiorenti. La fragola rifiorente ha subito l’effetto delle temperature elevate di luglio che hanno concentrato la maturazione e ritardato la nuova fioritura, compromettendo in parte la produzione estiva. In seguito, la produzione autunnale è stata abbondante e di buona qualità. La fragola unifera con doppio ciclo ha avuto, invece, una produzione di qualità e buona pezzatura in primavera, favorita delle temperature miti di quel periodo, mentre la produzione autunnale, al contrario della fragola rifiorente, è stata influenzata dal caldo estivo di luglio, proprio in corrispondenza dell’epoca di trapianto e delle fasi di accrescimento della pianta. Oltre ai problemi di malattie
fungine, la presenza di antonomo è stata importante e durante l’estate anche le infestazioni di tripidi hanno creato qualche problema su questa specie. Il lampone unifero ha sofferto parzialmente del periodo piovoso, con presenza di frutti colpiti da botrite, mentre successivamente le temperature elevate non hanno favorito la qualità del frutto e in qualche caso hanno favorito delle infestazioni di ragnetto rosso.
Per quanto riguarda la mora, in generale la produzione è stata condizionata dall’andamento piovoso. In alcuni appezzamenti si sono osservati consistenti attacchi di eriofide e contenute infestazioni di ragno rosso in piena estate. Anche il contenimento della peronospora è stato in molti casi difficoltoso per l’elevata umidità causata dai continui eventi meteorici. In diversi impianti di ribes si è osservato un calo produttivo rispetto alla media delle ultime annate, e sono proseguiti i fenomeni di disseccamento delle gemme. Si osservano sempre più impianti caratterizzati da deperimenti dovuti a verticillosi e talvolta da eutypa; inoltre, nelle zone più umide come il fondovalle, si è verificata anche qualche forte infezione di antracnosi.
Infine, in primavera-inizio estate si sono verificati, in particolare su mirtillo, ribes e mora attacchi di afidi tali da richiedere un intervento per il loro contenimento.


Ceraseto pedonabile: esperienza
con diverse combinazioni di portinnesto e forma di allevamento
TOMMASO PANTEZZI
ANGELA GOTTADELLO
GIANLUCA GIULIANI
In Trentino la coltivazione del ciliegio si estende per circa 250 ettari. Si tratta di impianti intensivi che richiedono investimenti costosi e molta manodopera, per la necessità di installare coperture antipioggia e antinsetto, nonché per la necessità di utilizzo di piattaforme per potatura e raccolta, vista l’altezza delle piante, e per le operazioni di apertura e chiusura delle protezioni. Per ridurre i costi e valutare se le rese produttive ed economiche non cambiavano rispetto allo standard di coltivazione, è stata proposta una tipologia di impianto semipedonabile a copertura monofilare, in cui si sono messi a confronto tre sistemi di allevamento, combinandoli con diversi portinnesti. Le piante sono state tenute a un’altezza massima di 3,2 metri e
di 2,9 metri fra le file. La varietà Kordia, la più diffusa in provincia, è stata innestata sui portinnesti Gisela 5 (G5), Weigi1 (W1) e Weigi 2 (W2) e allevata a UFO (Upright Fruiting Offshoot) alla distanza di 1,5 metri; parallelamente è stato confrontato il sistema spindle (TSA) e superspindle (SSA) su Gisela 3 (G3) alla distanza rispettivamente di 1 e 0,5 m fra le piante sulla fila. I risultati cumulati dopo 9 anni di coltivazione sono stati presentati al recente convegno internazionale del ciliegio svoltosi negli Stati Uniti a giugno 2025 (10° International Cherry Symposium, ISHS). I risultati hanno evidenziato in maniera significativa una ridotta vigoria delle piante allevate su G3 e per questo portinnesto in quelle alla maggiore densità; la produzione cumulata ad

Spindle/G3
1,0 m x 2,9 m
3.100 piante/9.000 m2
ettaro è risultata maggiore per UFO/ G5 rispetto agli altri 2 portinnesti W1 e W2. Per le piante allevate su G3, l’allevamento a spindle (TSA) ha avuto maggior produzione ad ettaro nonostante il numero di piante fosse la metà rispetto all’allevamento a SSA. Il peso medio del frutto migliore si è ottenuto sulla forma di allevamento a UFO, rispetto alle altre, e questo è evidenziato anche dalla campionatura media della produzione conferita separatamente nel corso degli anni; infatti, la percentuale di 28+ dei frutti è risultata variare fra il 51 e il 57% per UFO rispetto al 39% e al 43 % per TSA e SSA rispettivamente. Il colore dei frutti ha evidenziato delle differenze solo attraverso le misure strumentali con il colorimetro, mentre commercialmente tutte le combinazioni hanno avuto oltre il 90% di primo colore.
Anche la resa economica della produzione cumulata dal 2018 al 2024, calcolata attribuendo ad ogni com-

Superspindle/G3
0,5 m x 2,9 m 6.200 piante/9.000 m2
binazione di FA e portinnesto la produzione per ettaro e la campionatura annuale moltiplicata per un prezzo medio degli anni di conferimento, ha dato origine a delle differenze fra tesi a confronto: il risultato è stato variabile da un minimo di 266.000 euro per SSA/G3 a 363.000 euro per UFO/G5. Per la qualità dei frutti si sono osservate delle differenze significative minime per la durezza, per i gradi °Brix e per l’acidità della combinazione SSA/G3. Al di là dei risultati produttivi, dopo diversi anni di coltivazione sono emerse, per tutte le combinazioni, alcune difficoltà operative nel mantenere l’altezza e il volume delle piante all’interno delle dimensioni contenute dai sesti impostati. Inoltre, Kordia non sembra particolarmente adatta per le densità molto elevate, in quanto per questa varietà è più facile ottenere frutti di qualità su legno di più anni, difficilmente gestibile in piante molto fitte e in parete stretta che presuppone una potatura di rinnovo molto più frequente.

UFO/G5/W1/W2
1,5 m x 2,9 m
2.690 piante/9.000 m2
Figura 1
Aspetto delle forme di allevamento in fioritura per spindle, superspindle e UFO
Figura 2
Produzione cumulata per ettaro nel corso degli anni sulle diverse combinazioni di portinnesto e forma di allevamento
Conoscere gli effetti dell’irroratrice a cannone nei trattamenti su fragola coltivata fuori suolo in tunnel consente il miglioramento della tecnica di distribuzione in termini di riduzione delle perdite fuori bersaglio e aumento dell’efficienza di applicazione durante i trattamenti stessi.

Esperienze sulle modalità di distribuzione con irroratrici a cannone su fragola coltivata in tunnel
DANIEL BONDESAN
CLAUDIO RIZZI
GIANPIERO GANARIN
PAOLO MIORELLI
SANDRO CONCI
GINO ANGELI
Experiences with distribution methods using cannon sprayers on strawberries grown in tunnels
Over the years, the spray application technique has significantly improved, especially for high-value cultivations. However, there is still a dearth of knowledge regarding small fruit crops. In recent years, the Technology Transfer Center has focused on applied research to identify solutions, particularly for strawberries cultivated in high-tunnel systems. The main experimental activities aimed to investigate the potential for reducing pesticide spray drift when using a cannon sprayer by implementing partial or total closures of the tunnel towards pesticide sensitive areas. Furthermore, tracer deposits collected from the vegetation were compared to ensure adequate pesticide distribution across the canopy. Alternative application techniques, such as hand-held lances, fixed spraying systems, and standard and low-volume applications, for example, were also compared, to find more suitable application methods.
La tematica della distribuzione di prodotti fitosanitari su fragola e piccoli frutti è un argomento relativamente poco indagato, sia a livello nazionale
che globale, verosimilmente a causa della marginalità di queste coltivazioni rispetto ad altre colture cosiddette a più alto reddito. Sulla fragola in
particolare, molti studi del passato hanno indagato l’esposizione degli operatori ai trattamenti, individuando macchine irroratrici alternative alle lance ad azionamento manuale per ridurre i rischi di contaminazione. Negli ambienti di coltivazione di montagna, in cui la produzione della fragola viene valorizzata da un microclima favorevole, si è progressivamente diffusa la coltivazione in tunnel che consente di proteggere la produzione dagli agenti atmosferici e favorisce l’efficienza d’uso dei prodotti fitosanitari evitandone il dilavamento. Fra le attrezzature maggiormente impiegate su questo sistema di coltivazione vi è l’irroratrice ad aeroconvezione dotata di convogliatore a cannone (Foto 1), che permette di trattare in strutture di protezione anche di lunghezze considerevoli, limitando sensibilmente l’esposizione dell’operatore rispetto al trattamento manuale. Questa tipologia di macchina può essere di tipo pneumatico o più spesso di tipo misto, ossia costituita da un ventilatore centrifugo (tipico delle irroratrici pneumatiche) abbinato ad un circuito idraulico con pompa ad alta pressione ed ugelli a polverizzazione meccanica, adatti all’impiego anche di bassi volumi con la produzione di goccioline fini o molto fini.
Con l’obiettivo di caratterizzare maggiormente gli effetti dell’irroratrice a cannone nei trattamenti su fragola coltivata fuori suolo in tunnel, il Centro Trasferimento Tecnologico ha condotto alcuni studi per indagare sia la qualità dei depositi in pianta, sia le
possibilità di mitigazione dell’effetto deriva durante i trattamenti, anche a confronto con altre tecniche di applicazione. Fin dalle prime esperienze si è ravvisata la necessità di valutare l’impiego della carica elettrostatica indotta sulle goccioline, essendo emerso un certo interesse da parte degli utilizzatori e considerata la dotazione di dispositivi volti a produrre questo effetto in molte macchine a cannone presenti nelle aziende. Questa tecnologia consentirebbe di trasferire una carica elettrica, di un certo segno, alle goccioline di miscela fitosanitaria finemente nebulizzate. La nube di goccioline risulterebbe costituita da particelle particolarmente fini per effetto delle cariche che, essendo dello stesso segno, si respingono, frammentando la goccia su cui si dispongono. Per il principio di induzione elettrostatica che la nube carica produrrebbe sul bersaglio, le cariche di segno opposto a quelle delle goccioline, presenti sulla vegetazione, attrarrebbero la miscela polverizzata favorendone l’adesività su foglie e frutti, mentre le cariche di segno opposto andrebbero a scaricarsi a terra, allontanandosi dalla pianta. Come evidenziato da vari gruppi di ricerca, anche dalle esperienze condotte in Trentino, questo aspetto è risultato più evidente per la parte esterna della chioma ed in prossimità del punto di erogazione della miscela (Bondesan et al. 2015 IOBC/WPRS Bulletin 109:37-40). Esperienze più recenti a livello locale hanno confermato una tendenziale capacità della tecnologia elettrosta-

Foto 1
Macchina irroratrice dotata di convogliatore d’aria a cannone; in basso a sinistra si può notare la catena di messa a terra del dispositivo per la carica elettrostatica delle goccioline irrorate
Figura 1
Andamento delle dispersioni ritrovate a diverse distanze dal tunnel trattato ed effetto di mitigazione della deriva con l’impiego di barriere fisiche (telo plastico e rete anti-drosofila)
tica ad incrementare i depositi sulla chioma, senza però mostrare una conseguente riduzione delle perdite al di fuori delle strutture di protezione. Proprio la necessità di contenere efficacemente le perdite per deriva dello spray utilizzando irroratrici a cannone ha indotto a valutare l’utilizzo di chiusure parziali dei tunnel sulla testata rivolta verso la zona sensibile ai trattamenti, indagando inoltre quali effetti potesse consentire l’impiego di questa barriera fisica sui depositi in pianta (Bondesan et al. 2022 Asp. Appl. Biol. 147:125-132). Se da un lato la chiusura parziale del tunnel ha favorito un drastico calo delle dispersioni per deriva fuori dal tunnel, dall’altro è sembrato opportuno verificare ulteriormente le possibili interazioni tra la “barriera anti deriva” e i depositi, specie nella parte interna della vegetazione. Ulteriori indagini hanno quindi confermato la possibilità di ridurre in maniera più o meno marcata le dispersioni al di fuori delle strutture di protezione (Figura 1), impiegando reti antinsetto in alternativa ai più comuni teli plastici per la chiusura del lato in prossimità della zona
sensibile alla deriva, ma senza evidenziare una chiara correlazione con il processo di formazione dei depositi sulle diverse zone delle piante di fragola (Bondesan et al. 2024 Asp. Appl. Biol. 148:278-285). Già in precedenza, le esperienze su colture a frutto piccolo avevano consentito di apprezzare l’effetto delle reti antinsetto come barriera fisica in grado di interferire negativamente con i flussi di miscela, rivelando al contempo il potenziale effetto anti deriva a loro attribuibile (Bondesan et al. 2024 16th SPVR Conference: 191-196). Con riferimento alle restrizioni d’impiego a cui sono state sottoposte dal PAN le macchine dotate di convogliatore a cannone, ad oggi le sperimentazioni sopra descritte hanno consentito di mantenere l’impiego di questa tipologia di macchine in coltura protetta, adottando efficaci misure di mitigazione della deriva, a favore di una maggiore sostenibilità ambientale, ma anche un’adeguata tempestività d’intervento soprattutto nelle aziende di maggiori dimensioni. Altre esperienze condotte negli anni hanno consentito di evidenziare alcune potenziali alternative all’uso

della lancia a mano e dell’irroratrice a cannone, come gli impianti di distribuzione a punto fisso, andando ad evidenziarne sia i pregi, legati alla loro capacità di mitigare le dispersioni fuori dal filare, sia le sfide connesse con una non sempre soddisfacente omogeneità di localizzazione dei depositi all’interno della pianta e sui frutti. I relativi risultati sperimentali sono stati poi divulgati attraverso le tradizionali Giornate tecniche sui piccoli frutti organizzate dal CTT. Più
recentemente, alcune prove comparative hanno voluto verificare la possibilità di realizzare trattamenti efficienti utilizzando miscele concentrate ed impiegando ugelli anti deriva ad iniezione d’aria su irroratrici a cannone, definendo alcune ulteriori opportunità per migliorare la tecnica di distribuzione in termini di riduzione delle perdite fuori bersaglio ed aumento della produttività del lavoro durante i trattamenti (Bondesan et al 2025 3rd IOCAG sciforum-136454).
La conoscenza della bio-ecologia di Paysandisia archon può fornire indicazioni utili per ottimizzare gli interventi di contenimento da svolgere a livello territoriale e di conseguenza aumentarne l’efficacia riducendo l’impatto ambientale e paesaggistico causato da questo nuovo fitofago.

Paysandisia archon: una minaccia per le palme anche in Trentino
LORENZO TONINA
EMANUEL ENDRIZZI
DANIELE SANTUARI
MARIO BALDESSARI
GESSICA TOLOTTI
GIORGIO MARESI
Paysandisia archon: now also a threat to palm trees in Trentino
Paysandisia archon was accidentally introduced into Europe through the palm trade from South America in 2000 and has since gradually spread across several regions. In Trentino, this insect is present in an urban-mountain landscape, including Lake Garda, Valle dei Laghi, and Val d’Adige, reaching its northern limit in the Piana Rotaliana at 46°13’N. Surveys revealed that larvae are present year-round, suggesting a life cycle that exceeds one year. The most widespread and affected host is Trachycarpus fortunei, followed by Chamaerops humilis, Phoenix canariensis Washingtonia spp., and Butia capitata. The abundance of palms and rising temperatures indicate further expansion of this pest, which can only be effectively contained through targeted interventions. A control strategy has therefore been developed and promoted locally via various media.
Paysandisia archon (Burmeister, 1879) è un lepidottero sudamericano introdotto accidentalmente in Europa nel 2001 con il commercio di palme. Le sue larve scavano delle gallerie negli stipiti, ossia i fusti colonnari delle pal-
me, causando gravi danni fisiologici che arrivano a provocare la morte delle piante. I primi segnali dell’infestazione sono i tipici i fori consecutivi e ordinati sulle foglie e i piccioli delle foglie nuove più corti rispetto
alle foglie vecchie. Successivamente, le foglie giovani (centrali nella corona) crescono piccole e senza picciolo, appaiono ingiallite o grigiastre e con portamento cadente, e sono visibili la rosura e i tessuti distrutti nella zona di rinnovazione, per poi arrivare a completo disseccamento della pianta. Nel 2002 l’insetto è stato segnalato anche in Italia e negli anni successivi si è gradualmente diffuso in molte regioni italiane, soprattutto in zone costiere o urbane. In Trentino, oltre allo storico areale mite dell’Alto Garda, nel 2024 l’insetto si è ormai diffuso in tutta la Valle dei Laghi, raggiungendo altitudini maggiori come a Vigo Cavedine e Ranzo (660-750 m s.l.m.). È stato ritrovato anche in tutta la Vallagarina e in Val d’Adige, fino alla collina est di Trento, mentre sporadicamente in Piana Rotaliana (Lavis e Mezzolombardo). Piante sintomatiche sono state rinvenute anche nella zona di Lodrone (Lago d’Idro) e a Civezzano. Infatti, in Trentino l’insetto trova la sua distribuzione più settentrionale mai segnalata (46°13’N) in un ambiente urbano di montagna. Non sono state invece trovate piante sintomatiche in Valsugana, nemmeno in prossimità dei laghi di Caldonazzo e di Levico, probabilmente per la morfologia del territorio e per le caratteristiche orografiche che non hanno facilitato lo spostamento del lepidottero dalla Valle dell’Adige alla Valsugana. La Fondazione Mach, oltre all’attività di monitoraggio territoriale permanente, fondamentale per seguire la diffusione dell’infestazione, svolge
indagini sulla bio-ecologia dell’insetto e sulle possibilità di contenimento delle popolazioni e dei relativi danni alle piante.
In collaborazione con le giardinerie e i Comuni delle aree maggiormente coinvolte, sono stati osservati una cinquantina di fusti di palme a partire da febbraio 2024, per studiare la fenologia dell’insetto nel nostro ambiente. Dal monitoraggio è emersa la coesistenza di larve piccole (1 cm di lunghezza) e larve ormai mature (8-9 cm). Questo fa supporre che nell’areale gardesano l’insetto svolga il suo ciclo su più di un anno, suggerendo quindi la possibilità di ampliare il periodo per gli interventi di contenimento. In media sono state trovate una ventina di larve per pianta, ma in alcuni casi si è arrivati anche ad osservarne 70-90. Non tutte le larve appaiono vitali, ma una quota risulta morta per fattori naturali (ad opera di nematodi e funghi); questa attività di contenimento naturale aveva raggiunto il suo massimo nel periodo primaverile, più umido. A maggio si sono iniziati a vedere i primi bozzoli con le crisalidi da cui si sviluppano i nuovi adulti nel mese di giugno. Il loro volo è avvenuto durante tutta l’estate, con conseguente ovideposizione che si è protratta fino all’autunno inoltrato. La palma del Giappone (Trachycarpus fortunei) è la specie più diffusa e più colpita negli areali indagati, seguita dalla palma nana (Chamaerops humilis). Nell’Alto Garda è raro trovare palme senza sintomi e in molti casi gli stadi di infestazione sono avanzati,

Foto 2
Larva matura di P. archon
Tipico danno fogliare dovuto all’antecedente attività delle giovani larve sulle foglie non ancora dispiegate

con piante deperienti o morte. Sono stati osservati anche sintomi fogliari su esemplari di Phoenix canariensis, Washingtonia sp. e Butia capitata, specie caratterizzate da esemplari alti, con fogliame espanso, per cui la valutazione della sintomatologia da terra è stata resa possibile dall’utilizzo del drone. A questo proposito si sta approfondendo anche l’utilizzo delle immagini multispettrali per svolgere una rilevazione precoce dell’infestazione (osservazione dei primissimi sintomi o della modifica degli indici fisiologici). Il primo strumento di contenimento dell’espansione della problematica è l’eliminazione delle palme infestate e non più recuperabili, seguendo le procedure adeguate (conferimento ai centri di raccolta e corretto sminuzzamento del materiale) in quanto le larve possono completare lo sviluppo
anche nei fusti tagliati. Sulle piante non compromesse si può svolgere un’azione di controllo utilizzando i nematodi, organismi in grado di attaccare le larve all’interno dei fusti, da effettuarsi alla ripresa vegetativa in aprile/maggio e in autunno. Essendo i nematodi organismi viventi è fondamentale effettuare il trattamento con le condizioni meteo ottimali, in assenza di sole, con elevata umidità o in presenza di pioggia leggera. Questi interventi, se applicati ai primi segnali di infestazione, hanno buona efficacia, ma vanno ripetuti annualmente. Dai controlli svolti da FEM dopo un’applicazione primaverile di nematodi in pieno campo su piante con uno stadio avanzato di infestazione, seppur eseguita con le migliori condizioni microclimatiche, è emerso che, a fronte di un forte incremento di mor-
Palma fortemente compromessa


talità delle larve, si è avuta solo una lieve riduzione della sintomatologia. La presenza diffusa di piante ospiti sul territorio e l’innalzamento delle temperature fanno ipotizzare un’ulteriore espansione, con conseguenti danni paesaggistici ed economici, che potrà essere limitata solo da condizioni ambientali sfavorevoli e dagli interventi che verranno adottati. A questo proposito è stata individuata e promossa sul territorio una strategia che prevede il trattamento con nematodi delle piante che mostrano sintomi iniziali e l’abbattimento con la corretta eliminazione del materiale per le piante ormai compromesse. È però necessario intervenire su ampia scala considerata la valenza paesaggistico-turistica delle palme nell’areale gardesano attraverso un “gioco di squadra” tra amministrazioni, proprietari delle palme, enti di ricerca e operatori.
Va evidenziato che anche la palma del Giappone, a sua volta, è una specie invasiva e che si stanno osservando sempre più frequentemente piantine cresciute spontaneamente in luoghi naturali quali sottoboschi e aree marginali. L’evoluzione di questa dinamica andrà tenuta sotto controllo per evitare che possa diventare un problema per la rinnovazione naturale, come sta già succedendo nel Canton Ticino in Svizzera.
Al fine di illustrare la problematica ad amministratori e operatori del settore e di sensibilizzare la cittadinanza è stata intrapresa una campagna informativa attraverso l’apposita sezione sul sito della FEM dedicato alle emergenze fitosanitarie (//fitoemergenze. fmach.it/) la pubblicazione di articoli su quotidiani e riviste locali, oltre ad alcuni servizi televisivi e divulgazione nell’ambito di incontri e convegni.
Figura 1
Diffusione delle palme e dell’infestazione in provincia di Trento
MICHELE MORTEN
L’annata olivicola 2024
Nel 2024 negli oliveti trentini si è avuta un’eccellente produzione: in primavera non si sono verificate gelate e le piante hanno manifestato un’ottima presenza di rami misti con una buona carica di gemme a fiore; a fine maggio la fioritura ha vissuto un periodo meteorologico molto favorevole, garantendo un’elevata allegagione. A giugno, le piogge ben distribuite fino alla prima metà di luglio hanno garantito un corretto sviluppo delle drupe. Il caldo siccitoso che ha caratterizzato la seconda metà di luglio e il mese di agosto non ha interferito negativamente sulla produzione, perché la maggior parte degli oliveti è irrigata, garantendo una corretta idratazione delle drupe. Successivamente, le piogge di inizio settembre e le temperature più miti hanno permesso uno sviluppo ottimale della produzione. Il minor numero di ore di luce durante la fase di inoliazione, avvenuta in settembre, ha però influito negativamente sulla biosintesi degli acidi grassi, con un minore accumulo di sostanze grasse nelle drupe.
Per quanto riguarda gli insetti dannosi, anche nel 2024 la cimice asiatica (Halyomorpha halys) è stata ritrovata negli oliveti e, dove non correttamente gestita, ha provocato la cascola verde delle drupe; il danno, tuttavia, è stato poco significativo essendo stata un’annata molto produttiva. Su questo argomento, sono state elaborate dalla FEM, con diverse istituzioni e Università, le linee guida per la gestione di questo insetto, nate dall’esigenza di fornire indicazioni chiare agli olivicoltori del Nord Italia per il contenimento di Halyomorpha halys. Le linee guida promuovono i principi di sostenibilità e di lotta biologica, studiati dall’IOBC (International Organization for Biological and Integrated Control). L’obiet-
tivo è stato quello di trasmettere agli olivicoltori gli strumenti per affrontare questa avversità in modo adeguato, coniugando la salvaguardia degli aspetti ambientali dell’oliveto con l’ottenimento di una produzione economicamente sostenibile.
Bactrocera oleae, altro insetto chiave per questa coltura, ha svernato anche nel 2024 come adulto, grazie all’inverno caratterizzato da temperature miti. Il picco primaverile è stato registrato nella terza decade di marzo, raggiungendo 118 adulti in una settimana. Anche l’infestazione primaverile rilevata sulle drupe rimaste in pianta dall’autunno precedente (2023) ha raggiunto, in alcuni casi, il 70%. La generazione estiva non ha destato grossi problemi, confermando che di solito nelle annate di elevata produzione di olive non si registrano mai danni significativi sulla produzione. Si conferma anche nel 2024 una limitata presenza o assenza di Euzophera spp., rispetto agli anni precedenti. È stata rilevata anche nell’estate/autunno 2024 un’attività trofica della Palpita unionalis (margaronia) principalmente sugli apici di polloni e succhioni, solo in rari casi ha interessato le drupe.
Nel 2024 sono state conferite nei frantoi dell’Alto Garda trentino 2.845 t di olive, che hanno prodotto 311,4 t di olio, con una resa del 10,95% (0,146% sul dato nazionale).
L’assenza di problemi parassitari e la raccolta molto veloce, concentrata in poche settimane, hanno garantito una buona qualità dell’olio extra vergine prodotto, anche se non particolarmente ricco di polifenoli.
In sintesi, ricorderemo questa annata olivicola per la produzione di molte olive, ma con una quantità di olio relativamente meno abbondante.
Valutazione di prodotti biologici per il contrasto della rogna dell’olivo
Durante le annate 2023 e 2024 è stata messa in campo una prova sperimentale con l’obiettivo di trovare strategie per arginare il sempre crescente problema della batteriosi dell’olivo. Pseudomonas savastanoi pv savastanoi, chiamata comunemente rogna dell’olivo, è una patologia di origine batterica in forte espansione nel nord Italia, soprattutto nell’areale olivicolo del lago di Garda in quanto la varietà più coltivata è Casaliva, molto suscettibile al patogeno. Nella difesa fitosanitaria vengono utilizzati da sempre prodotti cuprici, poiché il rame ha un’attività batteriostatica e fungicida. Per le recenti restrizioni europee nell’impiego del rame in ambito agricolo (4 kg/ha/ anno) si è reso necessario impostare una prova di campo con l’obiettivo di trovare delle sostanze alternative/ coadiuvanti al rame, che contrastino l’espansione di questa malattia.
La sperimentazione si è svolta in un’azienda agricola condotta con metodo biologico situata nel comune di Arco, in località Padaro, in un oliveto molto infettato da questo batterio in seguito a vari eventi grandinigeni degli anni passati e al luogo particolarmente umido dov’è collocato. L’oliveto è co-
stituito da piante di età variabile (520 anni), con sesto d’impianto di circa 6x6 m.
Il campo è stato diviso in 4 blocchi (file), in base al trattamento da applicare, e sono state scelte 4 piante per fila in modo da avere 4 ripetizioni per tesi. Per ogni pianta sono stati controllati 60 germogli/rametti disposti in maniera uniforme sulla pianta (15 per punto cardinale). I prodotti usati sono descritti di seguito.
Tesi 1: miscela a base di rame (rame ossicloruro, 35% di Cu, 150 g/hl) e zolfo (zolfo liquido, 825 g/l di S, 400 ml/ hl) (anno 2023-2024);
Tesi 2: concime a base di rame chelato e zinco (rame 2%, zinco 4%, 300 ml/hl) (anno 2023-2024);
Tesi 3: prodotto a base di Bacillus subtilis (14,1 g/l, 600 ml/hl) (anno 2023); prodotto a base di chitosano (chitosano cloridrato 5%, 200 ml/hl) + acqua di vegetazione concentrata (flavonoidi, 1 l/hl) (anno 2024);
Tesi 4: estratto di legno (distillato di legno, 200 ml/hl).
Durante il 2023 e 2024 sono state eseguite circa 8 applicazioni per ciascuna tesi (Tabella 1) e sono stati fatti 5 rilievi per valutare l’evoluzione dei tumori per singolo rametto (25/9, 4/12

Foto 1
Tubercoli di rogna
Tabella 1
Epoca dei diversi trattamenti nelle 4 tesi oggetto di sperimentazione
Tesi
1 Aziendale (rame + zolfo)
2 Concime a base di rame chelato e zinco
Epoca trattamenti
2023 2024
5/5, 26/5, 5/7, 27/9, 14/11 14/3, 18/5, 19/11
3 Prodotto a base di Bacillus subtilis no Chitosano + acqua di vegetazione concentrata no 14/3, 18/5, 19/11
4 Distillato di legno
nel 2023; 12/3, 27/6, 22/10, nel 2024).
Per quanto concerne il numero medio di tumori per tesi nei nuovi accrescimenti, è stata rilevata una differenza significativa fra le tesi, con una minore incidenza di cancri/tumori sulle piante trattate con il concime a base di rame chelato e zinco, inferiore al distillato di legno e prodotto a base di Bacillus subtilis/chitosano, leggermente diversi, mentre la tesi più colpita è quella con il trattamento aziendale.
Per quanto riguarda l’evoluzione della malattia, si nota un peggioramento della presenza di tumori con il passare del tempo, in particolare con un incremento maggiore fra il penultimo e l’ultimo rilievo, dal 27 giugno al 22 ottobre 2024 (probabilmente dovuto all’estate con condizioni meteorologiche molto favorevoli). In base al test di Tukey sull’epoca di rilievo, risultano le seguenti significatività riportate in Figura 1, dove emerge che fra il rilievo del 12/3 e quello del 27/6 non c’è un aumento dei cancri.
Considerando congiuntamente trattamento e data del rilievo, si può osser-
5/5, 26/5, 5/7, 27/9, 14/11
vare che l’intervento con concime a base di rame chelato e zinco controlla in maniera migliore l’insorgere dei tumori sui nuovi accrescimenti, analogamente si comportano il distillato di legno e il prodotto a base di Bacillus subtilis, mentre il trattamento aziendale sembra controllare meno bene lo sviluppo dei tumori (Figura 1).
Dopo due anni di prova (2023-2024), è emersa una differenza significativa fra le diverse tesi, con una minore incidenza di tumori sugli accrescimenti delle piante trattate con concime a base di rame chelato e zinco. Risultati meno prestanti si sono osservati nelle tesi trattate con distillato di legno e con chitosano, mentre la tesi più colpita è stata quella con il trattamento aziendale.
In conclusione, si può affermare che la rogna dell’olivo è un batterio molto complicato da gestire su Casaliva/ Frantoio; anche se è impossibile evitare del tutto le ferite sulla pianta, è fondamentale limitarle al minimo, prestando la massima attenzione durante la potatura e le altre lavorazioni in campo.
Figura 1
Numero di tumori/cancri per tesi nel tempo
25/09/2023 04/12/2023 12/03/2024 27/06/2024 22/10/2024
Data del rilievo
Tesi 1 Tesi 2 Tesi 3 Tesi 4

Prime evidenze dei funghi associati all’antracnosi del noce in Trentino
La coltivazione del noce (Juglans regia L.) ha una lunga tradizione in Trentino, in particolare nelle Giudicarie Esteriori e nella zona del Bleggio, dove rappresenta un elemento identitario del paesaggio e della cultura locale. Nel 2024, il Centro Ricerca e Innovazione FEM ha coinvolto il Laboratorio di Diagnostica Fitopatologica nell’ambito del progetto CANOSSA (finanziato dal programma UNESCO “Man and the Biosphere”), per collaborare alla caratterizzazione del complesso di specie fungine responsabili dell’antracnosi del noce in Trentino. Poiché le diverse specie fungine possono mostrare comportamenti differenziati in relazione all’interazione con l’ospite, alle condizioni ambientali (temperatura e umidità) e alla sensibilità agli agro-
farmaci, la corretta identificazione degli agenti causali rappresenta il punto di partenza per definire strategie prima diagnostiche e poi di difesa, efficaci e sostenibili.
L’attività ha coinvolto diversi noceti nel comune di Bleggio Superiore, condotti con differenti modalità di gestione (biologica, integrata e non trattata), rappresentativi di varietà locali e moderne. In questi siti sono stati effettuati campionamenti mensili da marzo fino alla raccolta, che hanno interessato numerosi tessuti (foglie, frutti, gemme, legno, lettiera e frutti mummificati), con l’obiettivo di caratterizzare i patogeni presenti, individuare i principali siti di svernamento e le fasi più sensibili all’infezione. I primi sintomi riconducibili ad agenti di antracnosi sono stati osservati a
VALERIA GUALANDRI
ENRICO GRAZZI*
ROLANDO DEL FABBRO
THOMAS FATTORE
MICHELA TROGGIO*
ERICA DI PIERRO*
* Centro Ricerca e Innovazione, Fondazione Edmund Mach

partire dal mese di giugno e si presentavano come tacche necrotiche circolari, di forma irregolare e di colore bruno scuro, tendenzialmente depresse (Foto 1). Le analisi, condotte mediante tecniche di microscopia, caratterizzazione morfologica (Foto 2) e metodi molecolari (sequenziamento genico e analisi filogenetiche), hanno permesso di individuare diverse specie fungine e di riconoscere Colletotrichum spp. come il principale agente associato ai sintomi di antracnosi del noce in Trentino.
Le sequenze di DNA ottenute hanno consentito di identificare prevalentemente le specie C. godetiae, C. fioriniae e C. nymphaeae. Questi risultati, seppur preliminari, evidenziano un’elevata variabilità genetica e la coesistenza di più specie nei diversi siti produttivi.
Il genere Colletotrichum è ormai noto anche in Trentino per la sua capacità
di infettare altre colture economicamente rilevanti, come il melo (Glomerella Lef Spot). Colletotrichum è stato isolato in tutti i campionamenti, principalmente da gemme, foglie e frutti in diversi stadi di accrescimento e maturazione.
Le prime prove di patogenicità condotte su foglie di noce per valutare l’aggressività dei ceppi isolati hanno confermato, al momento, la capacità infettiva di numerosi isolati di C. godetiae
Questi risultati rappresentano le prime evidenze di un progetto di ricerca tuttora in corso e costituiscono un passo fondamentale verso la comprensione della biologia e della distribuzione di Colletotrichum spp. su noce in Trentino. Le conoscenze acquisite forniranno le basi per l’elaborazione di strategie integrate e sostenibili per la gestione dell’antracnosi del noce nel nostro territorio.


L’annata viticola 2024
The 2024 viticulture year
The 2024 was marked by above-average temperatures and abundant rainfall, which favored the development of downy mildew and powdery mildew, causing serious damage in untreated control plots. The high disease pressure required very intensive plant protection management, especially for organic vineyards, but in general, damage from fungal diseases was limited. Phenological development showed early advancement followed by a slight delay at flowering. Grape yield declined, especially for white varieties, due to reduced fertility and fewer berries per cluster. There was a significant spread of esca disease in susceptible varieties. The problems associated with controlling scale insects, mealybugs and phytophagous mites remained contained, with a significant decrease in the incidence of grapevine phytoplasma diseases in the monitored vineyards.
Nel 2024, durante la stagione vegetativa della vite, i fattori dal punto di vista meteorologico che hanno maggiormente influenzato la gestione in viticoltura sono stati la piovosità record di maggio e di giugno, (rispettivamente 339 millimetri e 244 millimetri nella stazione di Trento) e la temperatura media giornaliera del
mese di luglio (di 1,5° più alta rispetto alla media climatica). Da segnalare anche le gelate tardive che si sono verificate tra il 18 e il 25 aprile, che hanno interessato solo delle microaree più basse del fondovalle dove è ristagnata l’aria più fredda. Per quanto concerne la fenologia della vite, ad inizio stagione si sono regi-
strati degli anticipi rispetto alla media storica delle fasi di gemma mossa (5 giorni) e delle tre foglie distese (11 giorni), mentre l’epoca di fioritura, a causa di un periodo freddo e umido, è avvenuta con un ritardo medio di 1 giorno.
I dati agronomici e produttivi raccolti sul territorio hanno mostrato un germogliamento leggermente sopra la media (82,8%), ma una fertilità (1,5 grappoli per germoglio) sotto la media storica con Pinot grigio che ha registrato un -11% di fertilità. Il numero acini per grappolo è stato in media tra le principali varietà coltivate del 18% in meno rispetto alle annate precedenti, attribuito alle condizioni meteorologiche sfavorevoli che hanno avuto effetti negativi sull’allegagione. La produzione totale (fonte Consorzio Vini del Trentino) è stata poco più di 1 milione di quintali di uva in Provincia di Trento, abbastanza in linea con i dieci anni precedenti, ma in calo rispetto ai due anni precedenti. Le uve a bacca bianca (in particolare Pinot grigio con -14%) hanno subito cali maggiori rispetto alle uve a bacca rossa. Dal punto di vista fitosanitario la stagione 2024 rappresenta quella che, in assoluto, ha favorito lo sviluppo della peronospora in maniera più intensa e quindi potenzialmente più pericolosa per la vegetazione e la produzione delle viti. Nelle parcelle non trattate i danni sui grappoli, quindi la perdita di produzione, a fine luglio sono stati tra i più alti registrati nella serie sto-
rica; la pressione della malattia, oltre ad essere stata molto alta nelle zone di fondovalle, è stata elevata anche nelle zone di collina (storicamente meno sensibili). Malgrado le abbondanti e continue piogge, a maggio si sono verificate delle infezioni primarie di bassa e media gravità, influenzate probabilmente dalle temperature che per molti periodi sono risultate più basse della media. Le infezioni principali e generalmente molto gravi si sono verificate a giugno e fino a metà luglio; da rimarcare la forte infezione di peronospora larvata avvenuta nella terza decade di giugno. L’oidio, sebbene si sia manifestato molto precocemente ed anche in zone storicamente poco sensibili, si è sviluppato in maniera significativa durante il mese, molto caldo, di luglio. Sulle parcelle non trattate si è assistito ad una rapida crescita del fungo sui grappoli che ha portato, a fine luglio, a danni alla produzione tra i più alti registrati nella serie storica. Per l’oidio, parallelamente per quanto è stato osservato per peronospora, ma in condizioni invertite, i testimoni hanno evidenziato una pressione molto alta nelle zone di collina e alta nelle zone di fondovalle. Nonostante l’elevata pressione delle due principali malattie fungine, la difesa preventiva attuata in maniera corretta e tempestiva ha dato in generale risultati molto buoni: i monitoraggi territoriali hanno rilevato, sia per la conduzione integrata che per quella biologica, la presenza di dan-


no da peronospora sulla produzione che si attesta mediamente attorno al 2%, pur con frequenze alte di grappoli colpiti. La difesa fitosanitaria è stata molto impegnativa, con condizioni di intervento a volte difficili per la scarsa percorribilità dei vigneti; i continui dilavamenti e i turni molto serrati, soprattutto nel biologico, hanno reso necessario numerosi trattamenti.
Tra le malattie fungine più importanti i sintomi del complesso del mal dell’esca si sono manifestati in maniera progressiva e sono stati in generale molto evidenti; osservazioni attuate nell’epoca dell’invaiatura in circa 200 siti composti dalle varietà più diffuse, ha rilevato un’incidenza media di viti con sintomi del 2,9%, la maggioranza dei quali (78%) di tipo cronico. Sulle varietà più sensibili la diffusione di questa malattia raggiunge livelli significativi.
Per quanto riguarda i monitoraggi eseguiti su incarico del Servizio Fitosanitario provinciale, quello relativo a Scaphoideus titanus (insetto vettore della Flavescenza dorata) eseguito con le trappole cromotropiche, ha evidenziato un aumento delle catture medie degli adulti per postazione evidenziando delle criticità di contenimento in alcuni siti. I controlli nei vigneti per rilevare e contrassegnare le viti con sintomi di fitoplasmosi (Flavescenza dorata e Legno nero) sono stati eseguiti principalmente nel mese di settembre e hanno riguardato 1.092 appezzamenti, per un totale di
circa 350 ettari di superficie vitata. I risultati hanno rilevato che l’incidenza media (0,41%) era in calo significativo rispetto all’annata precedente e che la diminuzione della presenza delle fitoplasmosi si è verificata in tutte le principali aree viticole provinciali. Per le virosi della vite, se per GPGV non si riscontrano particolari problematiche di presenza nei vigneti (0,57% di incidenza tra le varietà più sensibili), la diffusione di sintomi riconducibili al virus dell’accartocciamento – soprattutto in alcune zone della provincia – causano ai viticoltori difficoltà a distinguerli dai sintomi da fitoplasmosi. Tra le cocciniglie la specie più rilevante dal punto di vista della gestione fitosanitaria in Trentino è Planococcus ficus: sebbene sia presente in diversi areali viticoli le popolazioni in generale hanno densità basse; nel 2024 non sono stati necessari interventi a livello di superfici significative. L’area viticola interessata dalla confusione sessuale per questo parassita è stata aumentata nel 2024. Nella rete territoriale in cui vengono eseguiti controlli periodici, nel 2024 a fine maggio è stata valutato che nell’87% dei siti i sintomi causati dai danni da acari tetranichidi erano assenti o sporadici. Un’indagine eseguita su 16 vigneti di Pinot grigio ha rilevato una media di due fitoseidi per foglia e ha confermato una predominanza di Euseius finlandicus (acaro generalista, consumatore di polline, meno specifico per acari fitofagi).

La biodiversità del suolo è fondamentale per la sostenibilità perché migliora la salute del suolo stesso, aumenta la fertilità delle colture e rende gli ecosistemi più resilienti e stabili.
RAFFAELLA MORELLI
EMANUELA COLLER
ROBERTO ZANZOTTI
Quali fattori determinano la biodiversità del suolo nei vigneti trentini?
What are the determining factors for soil biodiversity in Trentino vineyards?
Soil biota play a crucial role in the biological processes of soil. The Technology Transfer Center, in collaboration with the Trentino Wine Consortium, has studied the effects of soil and viticulture on biota across four soil types of different origin. The composition and biodiversity of fungi, bacteria, and microarthropods were analyzed, along with their interactions with abiotic factors. The results indicate that the impact of these factors varies depending on the soil. Edaphic characteristics influence bacteria and fungi, while microarthropods are less sensitive. Biodiversity responds differently to agricultural practices depending on the soil type. Understanding these relationships helps prevent the negative effects of environmental changes.
La biodiversità del suolo rappresenta l’insieme e la varietà degli organismi viventi presenti nel suolo stesso che interagiscono tra loro, con le piante e con l’ambiente circostante. Il suolo contiene la più grande quantità
di biodiversità e di biomassa vivente dell’intero pianeta. Il biota del suolo è costituito, oltre che dalle radici delle piante, dalla pedofauna e dalla microflora. Molte migliaia di specie animali trascorrono tutta o buona

parte della loro vita nel suolo o nella lettiera. Si tratta di organismi di dimensioni variabili da pochi micron fino ad alcuni centimetri, che vengono generalmente classificati in base alle dimensioni corporee in microfauna, mesofauna e macrofauna. La microflora è la componente più abbondante del suolo ed è costituita da un numero elevatissimo di specie microbiche, che includono batteri, attinomiceti, funghi e microalghe. Il biota del suolo svolge ruoli fondamentali per il funzionamento degli ecosistemi:
• è responsabile della decomposizione della materia organica e della liberazione dei nutrienti, altrimenti immobilizzati nella materia morta;
• contribuisce alla crescita e alla nutrizione delle piante;
• contribuisce al sequestro del carbonio nel suolo, arricchendolo di sostanza organica e sottraendo CO2 dall’atmosfera, mitigando in tal modo il cambiamento climatico;
• riduce la tossicità degli inquinanti e limita la loro diffusione nell’ambiente;
• limita la diffusione dei parassiti e dei patogeni;
• migliora le proprietà chimiche e fisiche del suolo e la sua fertilità. L’Unità Agricoltura biologica e qualità del suolo, in collaborazione con il Consorzio Vini del Trentino, ha con-
dotto uno studio nei vigneti trentini che mirava a comprendere l’effetto delle caratteristiche del suolo (tessitura, caratteristiche chimiche – sostanza organica, azoto totale, pH e calcare totale) e dell’attività viticola (frazione disponibile degli elementi associati alle pratiche viticole – Cu e Zn) sul biota del suolo in quattro tipi di terreno con diversa origine pedologica: conoidi calcarei dolomitici (DCC), alluvionali franco-limosi (SLA), glaciali misti (MG) e glaciali misti profondi (DMG). A tale scopo sono state studiate la composizione e la biodiversità delle comunità di funghi, di batteri e di microartropodi e le loro interazioni con i fattori abiotici.
Per ogni tipo di suolo sono stati individuati tre vigneti, lungo l’intera Valle dell’Adige (Figura 1). Sono stati, pertanto, campionati nella stagione primaverile 12 campioni di terreno nello strato 0-20 cm, ognuno costituito da 6 carote di terreno prelevate negli interfilari e unite per ottenere un campione omogeneo e rappresentativo di ogni vigneto (Figura 2). Il contenuto di sostanza organica (Figura 4a), buono in tutti i tipi di suolo, è risultato più alto nei suoli DCC, paragonabile soltanto ai suoli MG, mentre i DMG e gli SLA hanno mostrato i valori più bassi. La concentrazione della frazione disponibile di rame (Figura 4b) misurata
Figura 2
Schema di campionamento utilizzato in ogni vigneto. Le linee nere rappresentano i filari; la linea gialla tratteggiata l’area del vigneto interessata dal campionamento; i quadrati rossi le aree di campionamento dei microartropodi; i punti neri i punti di campionamento del terreno

Figura 3
Rappresentazione grafica della dissimilarità tra tipi di suolo delle comunità di funghi, batteri e microartropodi e in funzione dei fattori edafici (Analisi NMDSnonmetric multidimensional scaling)
nei suoli MG è risultata la più alta tra tutti i tipi di suolo. L’analisi di dissimilarità tra le comunità (Figura 3) ha evidenziato che funghi e batteri sono maggiormente influenzati dal tipo di suolo e dalle caratteristiche chimico-fisiche rispetto ai microartropodi, che sembrano rispondere meno alla diversità pedologica. Infatti, il poligono della comunità fungina dei suoli SLA è separato in maniera evidente da quello degli altri tipi
Funghi
Batteri
Artropodi
di suolo, così come il poligono della comunità batterica dei suoli SLA non è sovrapposto ai suoli MG. I poligoni delle comunità di microartropodi dei diversi tipi di suolo risultano, invece, sovrapposti, pertanto le comunità di questo gruppo di organismi non hanno mostrato diversificazione in funzione della pedologia, delle caratteristiche edafiche e dell’attività viticola.
Analizzando le relazioni tra le comunità edafiche e le caratteristiche abiotiche (Figura 5), i suoli DMG hanno mostrato il maggior numero di relazioni, mentre i suoli MG il minor numero. La comunità microbica (funghi e batteri) è risultata maggiormente influenzata dai fattori abiotici, mostrando numerose relazioni con essi, mentre gli artropodi sono il gruppo che ha esibito poche o nessuna relazione con tali fattori.
Mettendo in relazione la biodiversità con la concentrazione di rame, è stato evidenziato che la biodiversità non sempre si riduce quando aumenta la concentrazione di questo metallo utilizzato in viticoltura. Le relazioni
Alluvionali franco-limosi (SLA)
Tessitura Caratteristiche chimiche Attività viticola
Funghi Batteri Artropodi
Glaciali misti (MG)
Tessitura Caratteristiche chimiche Attività viticola
Funghi Batteri Artropodi
negative evidenziate sono risultate quattro su dodici per quanto riguarda la ricchezza in gruppi tassonomici e tre su dodici per quanto riguarda la ripartizione del numero degli individui nei diversi gruppi tassonomici. Soltanto per i suoli DCC è stata osservata una relazione negativa con l’indice di biodiversità S per tutte e tre le comunità indagate. Nei suoli MG, dove i valori della concentrazione di Cu erano i più elevati, la biodiversità di nessun gruppo di organismi ha subito un effetto dovuto alla presenza di questo elemento. Pertanto, questo studio ha mostrato che gli organismi del suolo reagiscono in maniera diversa ai fattori abiotici in funzione del tipo di suolo e che è l’effetto combinato dei fattori pedologici e delle pratiche agronomiche ad influenzare la composizione e la biodiversità del biota. Comprendere le interazioni tra biota e fattori abiotici aiuta a prevedere come cambiamenti naturali o artificiali possano modificare la vita nel suolo e i suoi processi biologici.
Conoidi dolomitici calcarei (DCC)
Tessitura Caratteristiche chimiche Attività viticola
Funghi Batteri Artropodi
Glaciali misti profondi (DMG)
Tessitura Caratteristiche chimiche Attività viticola
Funghi Batteri Artropodi
Figura 4
Contenuto di sostanza organica (a) e della frazione disponibile di Cu (b) nei vigneti oggetto di studio. I grafici rappresentano la media e l’errore standard (n=3) dei valori relativi ad ogni tipo di suolo. Lettere diverse indicano differenze significative tra tipi di suolo (p≤0,05)
Figura 5
Schema delle relazioni esistenti tra le comunità di funghi, batteri e microartropodi e i fattori abiotici per tipo di suolo

Sperimentazioni in campo sull’irrigazione della vite
FABIO ZOTTELE
CECILIA MATTEDI
FRANCESCO CENTURIONI
Tabella 1
Precipitazioni registrate al sito della sperimentazione (Mezzocorona Novali)
In Trentino la vite, pur essendo una coltura adattabile, si confronta sempre più spesso con periodi di piogge alternati a siccità che ne mettono in gioco la produttività e la qualità. Una gestione equilibrata delle irrigazioni, in linea con l’andamento meteorologico stagionale, è quindi essenziale per preservare la qualità dell’uva evitando carenze o sprechi d’acqua irrigua. Con questo obiettivo, nel 2024 a Mezzolombardo è stata condotta una sperimentazione su Teroldego per analiz-
zare il sistema suolo-pianta-atmosfera in vigneti irrigati e non irrigati. Sono stati monitorati l’andamento atmosferico, l’umidità del suolo con tensiometri, lo stato idrico delle viti con microtensiometri (FloraPulse, Davis) e il flusso e la salinità della linfa grezza con biosensori PlantVoice; le irrigazioni sono state gestite dal Consorzio irriguo.
Analizzando l’annata 2024 emerge come le piogge eccezionali di giugno e luglio (Tabella 1) abbiano favorito
una crescita vegetativa eccessiva, con foglie e tralci sviluppati a scapito dei frutti, generando uno squilibrio vegeto-produttivo confermato dall’indice di Ravaz (Tabella 2). L’analisi del potenziale idrico del tronco ha inoltre mostrato che, pur in condizioni ambientali uguali, ogni vite risponde diversamente, probabilmente per differenze nella struttura radicale o nella morfologia (Figura 1). In agosto e settembre, dopo un periodo secco (Tabella 1), è stata avviata l’irrigazione: le piante non irrigate si sono adattate bene al terreno meno umido mo-
strando livelli di stress idrico medio (Figura 2), condizione che spesso migliora la qualità enologica dei mosti. Il suolo irrigato ha invece superato la capacità di campo, con spreco di acqua per percolazione. Le abbondanti piogge di fine settembre (Tabella 1) hanno infine favorito la botrite, riducendo parte del raccolto, ma il confronto tra i mosti delle due tesi non ha evidenziato differenze statisticamente significative (Tabella 3).
La sperimentazione ha confermato che una gestione irrigua efficace richiede una visione integrata del siste-
Tabella 2
Indice di Ravaz calcolato per ogni pianta della sperimentazione
Tabella 3
Caratteristiche enologiche medie delle due tesi
Figura 1
Andamento del potenziale idrico del tronco delle quattro piante nel mese di giugno, associate ai valori di precipitazione
Figura 2
Andamento del potenziale idrico del tronco su due piante (Pianta 1, irrigata, Pianta 2, non irrigata) e confrontati con precipitazioni (barre azzurre) e irrigazioni (barre verdi). Livelli di stress medio sono identificati nell’intervallo -0,3 Mpa e -0,5 Mpa
Precipitazioni Irrigazione Pianta 1 Pianta 2
ma suolo-pianta atmosfera, supportata da sensori in campo in grado di indirizzare gli interventi solo quando realmente necessari. Per concludere, parlare di irrigazione di precisione non significa solamente irrigare “a goccia”: la vera sfida è abbandonare la logica dell’irrigazione a calenda-
rio per adottare pratiche basate sul reale fabbisogno idrico delle piante. Questo percorso richiede non solo strumenti e sensori, ma soprattutto il trasferimento delle conoscenze ai viticoltori da parte di tecnici adeguatamente formati e competenti che li affiancano in campo.

Monitoraggio territoriale delle principali avversità della vite
Nel 2022 è stata impostata e seguita dai tecnici dell’Unità Viticoltura una rete di monitoraggio denominata “punti fissi” costituita da 84 siti, dislocati in 32 Comuni, in modo da coprire tutti i principali distretti viticoli provinciali. I siti sono costituiti da vigneti coltivati con il metodo della produzione integrata, rappresentativi della zona e appartenenti alle varietà più diffuse: 77% a bacca bianca (Chardonnay, Pinot grigio) e 23% a bacca rossa (Merlot, Teroldego). In questi appezzamenti è stato applicato un protocollo comune di controlli, sia come tipologia, sia come tempistiche di rilevamento: ogni anno è stata valutata, attraverso il controllo della vegetazione e dei grappoli, la presenza delle principali avversità biotiche tipiche dei nostri ambienti (perono-
spora, oidio, black rot, marciume acido, botrite, antracnosi, acari, cocciniglie, tignole, cicaline, minatori fogliari, nottue) e abiotiche (danni da freddo, grandine, stress idrico, disseccamento del rachide) in quattro diversi momenti della stagione vegetativa della vite (alla fine dei mesi di maggio, giugno, luglio e agosto). La raccolta dei dati è stata eseguita in maniera standardizzata attraverso l’utilizzo dell’applicazione per smartphone FieldOffice vite, realizzata da FEM e in dotazione ai tecnici che lavorano sul territorio. Questo sistema permette una precisa elaborazione dei dati: è possibile calcolare per le diverse avversità, ad esempio, la percentuale di siti con presenza, frequenza e grado di attacco degli organi colpiti e la densità della popolazione (nu-
ALBERTO GELMETTI
MICHELE MARGONI
MAURO ZUANAZZI
Foto 1
Grappolo di Pinot nero con botrite
Figura 1
Figura 2
Diffusione nei vigneti dei sintomi di acari tetranichidi a fine maggio
Tabella 1
Percentuale di siti con presenza delle cocciniglie sui vari organi della vite
mero medio di insetti per foglia o per grappolo). Le informazioni raccolte nei “punti fissi” consentono di avere una fotografia della situazione fitosanitaria delle diverse macroaree viticole della provincia, seguirne l’evoluzione durante la stagione, confrontare le diverse annate, poter valutare eventuali criticità di contenimento e stimare eventuali danni alla produzione viticola. Questa attività di monitoraggio territoriale rientra tra le attività previste dal Piano di Azione Nazionale per l’uso sostenibile dei prodotti fitosanitari (Decreto 22 gennaio 2014). I risultati di questi moni-
toraggi vengono pubblicati durante la stagione nei report mensili inviati ai viticoltori tramite gli avvisi tecnici della FEM e vengono utilizzati nei bilanci fitosanitari dell’annata e negli incontri tecnici. Alcuni esempi di elaborazione dei dati raccolti da questa attività di monitoraggio triennale, dal 2022 al 2024, riguardano la presenza delle principali malattie fungine sui grappoli a fine luglio (Figura 1), la diffusione dei sintomi da acari tetranichidi su foglie a fine maggio (Figura 2) e la percentuale di siti con presenza delle cocciniglie rilevate sui vari organi della pianta (Tabella 1).

Rame e zolfo: sinergia per il controllo della peronospora in viticoltura biologica
La viticoltura moderna, in particolare quella biologica, si trova ad affrontare sfide significative e in continua evoluzione. La difesa della vite da malattie e parassiti non è più una semplice applicazione di prodotti, ma un approccio integrato che richiede conoscenze approfondite e innovazione costante. La peronospora della vite rappresenta una delle patologie più insidiose, specialmente in annate caratterizzate da elevata piovosità primaverile. Nel 2024, le parcelle non trattate, monitorate in diverse zone viticole provinciali, registravano un’incidenza media di peronospora sui grappoli del 90% con danno medio del 66%.
In viticoltura biologica, il rame rappresenta il principio attivo di riferimento contro questo patogeno. Tuttavia, il
suo utilizzo è regolamentato da un limite di 28 kg/ha in 7 anni. Tale restrizione impone una gestione oculata e strategica che prevede il monitoraggio costante del vigneto, l’adozione di sistemi di supporto decisionale (DSS), la razionale gestione della chioma e, non ultimo, la ricerca di soluzioni che possano incrementare l’efficacia e la persistenza del rame, consentendo di ridurne i dosaggi.
Tradizionalmente, il rame è impiegato come fungicida preventivo contro la peronospora, mentre lo zolfo è noto per la sua efficacia antioidica. Studi recenti (Bleyer et al. 2024 OENO One 58(1)) e prove dimostrative condotte negli ultimi anni hanno messo in risalto una sinergia positiva tra i due elementi nel controllo della peronospo-
Lo studio dell’effetto dello zolfo in combinazione con il rame ha evidenziato una sinergia positiva tra i due elementi nel controllo della peronospora. Approfondire tali meccanismi potrà contribuire a ottimizzare la gestione del patogeno, garantendo al contempo una produzione sostenibile e di qualità.
ROBERTO ZANZOTTI
ROBERTO LUCIN
MARCO CHIUSOLE
ROMANO MAINES
FLAVIA FORNO
DANIELE PRODORUTTI
Foto 1
Macchie di peronospora su foglia
Tabella 1
Dosaggi di rame metallo e zolfo elementare impiegati, diffusione e intensità di peronospora su foglia e grappolo (media ± errore standard). Lettere diverse indicano differenze statisticamente significative (Tukey test, p < 0,05).
ra. Nel 2024, l’efficacia della miscela di rame e zolfo è stata valutata in una prova sperimentale su Pinot grigio a San Michele all’Adige.
La prova, a blocchi randomizzati, ha permesso di approfondire questa interazione e confrontare l’efficacia di tre diverse formulazioni di zolfo in miscela con rame (tesi Cu+A, Cu+B e Cu+C). Le valutazioni sulle foglie (Tabella 1) hanno evidenziato una diffusione inferiore della peronospora nelle tesi Cu+A e Cu+B, in confronto al solo rame. In termini di intensità, il danno più contenuto è stato registrato dalla miscela Cu+A, la quale si è differenziata statisticamente dalla tesi trattata unicamente con rame. La valutazione finale sui grappoli (Tabella 1) ha confermato che l’intensità di peronospora è stata statisticamente
più bassa nel caso delle miscele rame-zolfo e in particolare nella tesi Cu+A. Quest’ultima, inoltre, ha fatto registrare la diffusione più bassa di tutte le tesi testate, ad eccezione della tesi Cu+C.
In sintesi, le prove hanno dimostrato che la miscela di rame e zolfo aumenta significativamente l’efficacia contro la peronospora. L’effetto sinergico dello zolfo, sebbene il suo meccanismo d’azione non sia ancora pienamente compreso, sembra variare inoltre a seconda della formulazione utilizzata. Le future ricerche dovranno mirare a chiarire i meccanismi di questa sinergia e a ottimizzare ulteriormente le formulazioni per massimizzare il controllo della peronospora, garantendo al contempo una produzione sostenibile e di alta qualità.

Ruolo delle proteasi e del riscaldamento del mosto sull’aromaticità dei vini bianchi
La stabilità proteica è un imperativo qualitativo per vini bianchi e rosati, dove la formazione di torbido in bottiglia rappresenta un difetto inaccettabile per il consumatore. Storicamente, la soluzione più ampiamente applicata è l’utilizzo di bentonite, un alluminosilicato che, seppur altamente efficace, è oneroso in termini di costi di smaltimento dei fanghi e volume di vino perso, e in termini qualitativi, in quanto comporta lo smagrimento sensoriale del vino.
La ricerca più recente propone un’alternativa efficace grazie alla combinazione del riscaldamento e raffreddamento flash del mosto (~1 min) in presenza di aspergillopepsine I (API), enzimi proteolitici attivi al pH del mosto. La combinazione di caldo e proteasi ha permesso di raggiungere la completa stabilità proteica in vini di Traminer aromatico e Sauvignon blanc, varietà note per “chiamare” elevate quantità di bentonite per la stabilizzazione dei loro vini. Questo risultato è principalmente la conseguenza del riscaldamento del mosto, che degrada la struttura globulare delle proteine instabili che porta alla loro flocculazione e precipitazione. Tuttavia, dall’analisi delle singole frazioni proteiche responsabili dell’instabilità, si è osservato come la presenza di AP-I riduce fino al 99% del totale di chitinasi e oltre il 64% delle proteine Thaumatin-like, entrambe chiavi per la stabilità proteica a lungo termine, data la capacità di re-folding di quest’ultime.
La scelta di utilizzare varietà aromatiche e semi-aromatiche è funzionale allo studio delle conseguenze che il riscaldamento del mosto può apportare sul profilo aromatico e sulla qualità del vino. Il riscaldamento – con o senza AP-I – ha incrementato la concentrazione di composti volatili aro-
maticamente attivi derivanti dal lievito e appartenenti alla famiglia degli esteri, fino a quasi raddoppiare per taluni composti rispetto ai vini prodotti con protocolli tradizionali. Queste molecole contribuiscono in genere alla percezione degli aromi fruttati dei vini e sono la conseguenza della presenza e gestione di fattori nutrizionali per il lievito durante la fermentazione. Coerentemente con questo e con l’attività proteolitica delle AP-I, la presenza degli enzimi durante il riscaldamento del mosto ha aumentato la concentrazione di alcuni amminoacidi assimilabili dal lievito, senza che si osservi un effetto degradativo del calore. Tuttavia, come atteso, i trattamenti termici hanno degradato una frazione dei terpeni, composti aromatici di origine uvica che sono associati alla percezione della componente floreale dei vini. Nonostante le chiare modifiche nel profilo volatile (riduzione dei terpeni, aumento degli esteri), l’analisi sensoriale realizzata da enologi esperti nella produzione di entrambe le varietà ha portato ad un interessante riscontro poiché non sono emerse particolari differente fra i principali descrittori organolettici utilizzati per la valutazione aromatica dei vini fra i trattamenti. In conclusione, l’uso del riscaldamento del mosto in presenza di aspergillopepsine-I ha permesso di risolvere in modo efficace il problema della stabilità proteica dei vini, impattando sul loro profilo compositivo, tuttavia, senza una chiara risultanza sul profilo aromatico rilevata dai tecnici del settore.
Lo studio è stato effettuato nell’ambito del Dottorato di ricerca dell’autrice Adelaide Gallo. I risultati sono stati oggetto di diverse pubblicazioni scientifiche, anche a livello internazionale (Gallo et al. 2024 Food Res. Int. 186:114332).
ADELAIDE GALLO*
NICOLA CAPPELLO
MAURO PAOLINI
LORIS TONIDANDEL
TIZIANA NARDIN
ROBERTO LARCHER
TOMAS ROMAN
* Dottoranda Centro Agricoltura Alimenti Ambiente (C3A), Università degli Studi di Trento
NICOLA CAPPELLO
ADELAIDE GALLO*
ROBERTO LARCHER
MAURO PAOLINI
TIZIANA NARDIN
RAFFAELE GUZZON
SILVIA SCHIAVON
TOMAS ROMAN
* Dottoranda Centro Agricoltura Alimenti
Ambiente (C3A), Università degli Studi di Trento
L’impiego di Hanseniaspora vineae in enologia: strategie di inoculo e metabolismo aromatico
L’interesse dell’industria enologica verso i lieviti non-Saccharomyces (NS) è in costante crescita, sfruttando le loro peculiarità metaboliche. Fra i diversi criteri, alcune specie di NS sono state selezionate per la capacità di incrementare la complessità aromatica dei vini, tra cui recentemente Hanseniaspora vineae. Questo lievito apiculato si contraddistingue come uno degli NS più promettenti, in virtù della capacità di sintesi de novo di benzenoidi e di derivati aromatici della via dei fenilpropanoidi, in maniera complementare rispetto a Saccharomyces cerevisiae. Il contributo tecnico più significativo di H. vineae è la sua capacità di biosintesi di acetato di β-feniletile, un estere acetico derivante dal metabolismo della fenilalanina, che conferisce al vino intense note floreali, di rosa e miele.
Tuttavia, una volta accertate le peculiarità metaboliche e selezionato il ceppo adeguato, è necessario identificare le migliori strategie di inoculo e di gestione nutrizionale per poter sfruttare appieno il loro potenziale e garantire il successo in ambito industriale. Gli studi realizzati con il ceppo Hv205 confermano in primis una straordinaria stabilità di questo carattere, incrementando la concentrazione nei vini fra le 10 e 30 volte rispetto a S. cerevisiae, e superando ampiamente la soglia di percezione organolettica. Questo carattere è stato osservato sia in strategie di inoculo sequenziale, sia in coinoculo di H. vineae con S. cerevisiae. Tuttavia, l’enorme capacità di colonizzazione del mosto di H. vineae spesso ostacola S. cerevisiae
nella corretta conduzione e chiusura della fermentazione nei protocolli sequenziali, qualora il loro fabbisogno nutrizionale non sia adeguatamente soddisfatto. Per limitare questi rischi, sono state approfonditi le condizioni più interessanti di utilizzo di H. vineae in coinoculo con S. cerevisiae. I rapporti di inoculo fra il 67% e il 90% di cellule vive di H. vineae rispetto al totale con S. cerevisiae sembra essere il giusto compromesso per il mantenimento delle peculiarità metaboliche, la corretta gestione del processo fermentativo e la qualità percepita dei vini risultanti. È stata inoltre osservata una correlazione lineare tra il rapporto di inoculo di H. vineae e S. cerevisiae con le concentrazioni di 2-feniletanolo, acetato di β-feniletile, esanoato di etil e acetato di isoamile, individuati per l’analisi quali marker aromatici dell’attività del lievito. Per approcci in gestione sequenziale dell’inoculo delle due specie, le cinetiche fermentative ottenute risultano paragonabili a quelle dei controlli, quando il ritardo nell’inoculo di S. cerevisiae non supera le 48 ore, senza indurre fermentazioni lente o incomplete, e garantendo l’espressione aromatica caratteristica di H. vineae. Lo studio è stato effettuato nell’ambito del Dottorato di ricerca dell’autrice Adelaide Gallo. I risultati sono stati oggetto di diverse pubblicazioni scientifiche, anche a livello internazionale (Gallo et al. 2023 J. Food Compos. Anal. 123:105514; Gallo et al. 2024 Fermentation 10 (4):191; Gallo et al. 2023 44th OIV World Congress 2023:699-701).

Interazioni tra lieviti e acido fumarico per nuovi approcci all’acidificazione di mosti e vini
Interactions between yeasts and fumaric acid for new approaches to the acidification of musts and wines
Fumaric acid is an effective antibacterial agent that can be added to wine to prevent malolactic fermentation, but what effect does it have on yeasts? In this study, we evaluate the impact of the molecule on S. cerevisiae, the primary yeast of interest in oenology. The results indicated that the addition of fumaric acid to musts temporarily lowers the pH. This effect is beneficial for preventing microbiological spoilage, without significantly altering the activity of the yeasts typically used in alcoholic fermentation during winemaking.
L’acidità del vino, un equilibrio delicato
L’acidità è fondamentale per il gusto del vino e ne garantisce la longevità. Gli acidi tartarico, malico e citrico si accumulano nel grappolo d’uva e sono trasferiti al vino in quantità e proporzioni diverse a seconda di una moltitudine di variabili. Tra le più
influenti il vitigno, le condizioni climatiche e le pratiche agronomiche. Anche le tecniche di vinificazione influenzano il profilo acido del vino e un ruolo fondamentale è svolto dai gruppi microbici. Ad oggi l’acidificazione del mosto – o del vino – è svolta mediante aggiunta di acido tartarico, lattico, malico o citrico. Questa
RAFFAELE GUZZON
GIOVANNA FACCHINELLI
MARIO MALACARNE
TIZIANA NARDIN
TOMAS ROMAN
ROBERTO LARCHER
Figura 1
Andamento della produzione di CO2 e del pH del vino durante la fermentazione di diversi mosti condotta con S. cerevisiae
ATCC 13007 in cinque mosti aggiunti di acido fumarico (1 g/l) (dati medi ± SD)
(h)
Controllo
limitazione è legata alla tradizionale volontà di evitare l’introduzione di componenti esogeni dall’uva nel vino, per preservarne il valore e l’autenticità percepita dai consumatori. Pertanto, la proposta di autorizzare l’utilizzo dell’acido fumarico come acidificante del vino rappresenta una notevole innovazione. L’acido fumarico (acido trans-2-butendioico, C4H4O4), ha numerosi usi nel settore alimentare: essendo un acido relativamente forte è in grado di ridurre il pH dei cibi, svolgendo un’azione acidificante e conservante. L’uso dell’acido fumarico in campo enologico è consentito per inibire la fermentazione malolattica, con dosi raccomandate tra 300 e 600 mg/l. Già dai primi lavori sull’uso dell’acido fumarico nei vini, svolti negli anni ’70, fu chiaro che la presenza di questo acido nel vino dipendeva dall’assenza di lieviti vitali, poiché S. cerevisiae può assorbirlo con eventuale accumulo
di acido malico e/o acido succinico. Dunque, un suo ampio uso come acidificante merita approfondimenti sulle interazioni con i lieviti enologici. Partendo da queste considerazioni presso il Dipartimento Trasformazione Alimentare della Fondazione Mach è stata condotta un’indagine sull’impatto dell’aggiunta di acido fumarico sulla vitalità e performance fermentativa di S. cerevisiae
Il piano sperimentale
Il piano sperimentale ha visto l’aggiunta di acido fumarico (1 g/l) a diversi mosti d’uva sottoponendoli poi a fermentazione alcolica con ceppi di S. cerevisiae, in comparazione ai medesimi esperimenti condotti in assenza dell’acido. Le fermentazioni sono state condotte in bottiglie di vetro da 1 litro dotate di tappo e valvola di non ritorno per consentire l’uscita della CO2 senza contaminazione esterna dei mosti. I ceppi di lievito
Figura 2
Andamento della produzione di CO2 e della velocità di fermentazione durante I test condotti con diversi LSA in presenza di acido malico (1 g/l) (dati medi ± SD)
Media lieviti commerciali (andamento fermentazione)
Media lieviti commerciali + fumarico (andamento fermentazione)
con acido fumarico
24 h 72 h 336 h
sono stati inoculati a una concentrazione nominale di 1×106 cell/ml, e la fermentazione è stata eseguita a 25 °C con agitazione manuale quotidiana. Durante i test l’andamento della fermentazione alcolica è stato monitorato mediante misura del calo peso ed è stato anche misurato il pH per verificare eventuali variazioni. Al termine dei test sono stati determinati i principali parametri enologici dei vini mediante metodiche OIV o tecniche strumentali equivalenti.
Come si sono comportati i ceppi di S. cerevisiae in presenza di acido fumarico?
Il primo esperimento ha avuto l’obiettivo di valutare l’impatto dell’aggiunta di acido fumarico sull’attività fermentativa e sulla vitalità di S. cerevisiae, utilizzando un ceppo standard di lievito e diversi mosti per saggiare la variabilità dovuta a cambiamenti della matrice di fermentazione. Non sono state registrate differenze significative nell’andamento delle fermentazioni (ANOVA a una via, p < 0,05) nelle 336 ore di durata degli esperimenti (Figura 1). In entrambe le tesi la velocità massima di fermentazione è stata raggiunta 143 ore dopo l’inoculo del lievito, mentre è stato osservato un abbassamento del pH durante le prime 96 ore di fermentazione (Figura 1) dopodiché è stato osservato un aumento progressivo del pH, raggiungendo un valore paragonabile a quello iniziale. Durante le prime 53 ore di fermentazione, la differenza tra il pH medio dei test trattati con acido fumarico e il controllo senza aggiunta è stata statisticamente significativa (ANOVA a una via, p < 0,05). La Tabella 1 elenca le concentrazioni di cellule di lievito vive/morte misurate in tre diversi
punti della fermentazione alcolica. L’analisi statistica dei dati non ha rivelato differenze dovute alla presenza di acido fumarico nei primi due punti di osservazione, mentre si osserva un incremento delle cellule morte nelle tesi trattate al termine della fermentazione alcolica. La seconda serie di test ha considerato diversi ceppi commerciali di S. cerevisiae sotto forma di Lievito Secco Attivo (LSA) per l’inoculo della fermentazione alcolica in presenza di acido fumarico per confermare i risultati ottenuti con il ceppo standard (Figura 2). Le fermentazioni alcoliche sono iniziate 24 ore dopo l’inoculo dei ceppi di LSA, con il raggiungimento della V max in circa 142 ore e la conclusione in circa 300 ore in entrambi gli esperimenti. In linea con le osservazioni precedenti, l’aggiunta di acido fumarico non ha causato cambiamenti significativi nell’attività del lievito (ANOVA a una via, p < 0,05). Anche in questo caso non abbiamo riscontrato differenze statisticamente significative tra i valori delle cellule vive o morte nelle due tesi. Interessante è stato poi svolgere analisi chimiche di base sui vini ottenuti. In tutti i casi l’incremento di acido malico e succinico non è stato statisticamente significativo, rispetto al testimone. Questo è dovuto probabilmente sia alle modeste dosi di acido fumarico impiegate, comunque in linea con i protocolli enologici, sia alla capacità del lievito di integrare questa molecola in diverse vie metaboliche. Pertanto, si conferma l’azione prevalentemente antimicrobica dell’acido fumarico, mentre la capacità acidificante è transitoria, utile per ottimizzare il controllo microbiologico all’inizio della vinificazione e senza significativi impatti sull’attività dei lieviti.
Tabella 1
Vitalità delle cellule di lievito durante i test di fermentazione in presenza di 1 g/l di acido fumarico; dati rilevati mediante citometria di flusso (dati medi ± SD)
Influenza del processo di dealcolazione del vino sul contenuto di residui di fitofarmaci
MARIO MALACARNE
ALICE BARBERO
LORIS TONIDANDEL
1
Analisi compositiva del vino bianco e dei relativi campioni dealcolati, forniti dall’Azienda A
Negli ultimi anni, l’evoluzione delle preferenze dei consumatori nelle scelte alimentari ha favorito lo sviluppo di prodotti vitivinicoli innovativi a basso o nullo contenuto alcolico, pensati per nuovi contesti e stili di consumo. In questo ambito, il Regolamento (UE) 2021/2117 ha autorizzato la produzione di vino dealcolato o parzialmente dealcolato tramite evaporazione sottovuoto, distillazione o tecniche a membrana. Queste ultime si distinguono per l’elevata selettività verso l’etanolo e le basse temperature operative, consentendo un risparmio energetico e una buona conservazione delle proprietà sensoriali del vino (Mangindaana et al. 2018 Trends Food Sci. Technol. 71:36-95).
Scopo di questo lavoro è stato quello di valutare se la dealcolazione tramite membrane modifichi il profilo dei residui di fitofarmaci nei vini convenzionali (Malacarne et al. 2024 EPRW BoA PO-24). A tale fine, sono stati analizzati due vini bianchi e i rispettivi campioni dealcolati, forniti da due aziende italiane che impiegano tecniche a membrana. In un caso, la dealcolazione è stata effettuata a due temperature: 20 °C e 25 °C. Tutti i campioni (convenzionali e dealcolati) sono stati caratterizzati attraverso analisi compositive secondo i metodi OIV (OIV-MA-INT-00-2024). I residui di fitofarmaci sono stati analizzati con il metodo multiresiduale QuEChERS (EN 15662:2018 European standard), con ricerca di circa 400 principi attivi mediante LC-MS/MS e GC-MS/MS.
Il metodo è accreditato ISO 17025 e validato secondo le linee guida SANTE 11312/2021 (SANTE/11312/2021 v2) su matrici rappresentative di vino e vino dealcolato.
Le analisi (Tabella 1 e 2) confermano l’efficacia del processo di dealcolazione e mostrano una lieve ma significativa riduzione di zuccheri, acidità totale e volatile, ed estratto secco. Queste diminuzioni risultano più marcate a 25 °C rispetto a 20 °C. La Figura 1 e la Figura 2 mostrano il contenuto di principi attivi nei vini convenzionali delle aziende A e B e nei rispettivi campioni dealcolati. È interessante notare come il processo di dealcolazione abbia ridotto la concentrazione di alcuni principi attivi fino al 20% (es. metalaxyl nell’Azienda A; boscalid, dimetomorph, fluopicolide, isofetamide nell’Azienda B a 20 °C) e, in certi casi, oltre il 50% (es. phthalimide nell’Azienda B). Temperature più alte (25 °C) amplificano questi effetti. Tuttavia, la riduzione non è uniforme: ad esempio, la phthalimide diminuisce solo del 3% nell’Azienda A, ma del 55% nell’Azienda B. La diversa selettività dei materiali di membrana può spiegare tale variabilità. Va inoltre chiarito che l’apparente calo di fitofarmaci dovuto all’aggiunta di mosto (Figura 1) è in realtà un effetto di diluizione, dato che il contenuto di residui nel mosto era trascurabile. Alcuni principi attivi, come il fluopyram, non mostrano riduzioni significative, probabilmente a causa della loro bassa polarità. Infine, la pastorizzazione
finale del vino dealcolato può contribuire alla diminuzione dei residui più termolabili (es. metalaxyl).
In sintesi, le tecniche a membrana possono ridurre significativamente alcuni residui di agrofarmaci, mentre altri rimangono pressoché invariati. Dalla sperimentazione sembrano es-
sere i principi attivi più polari che risentono maggiormente del processo, però tale ipotesi andrebbe rafforzata attraverso sperimentazioni dedicate. Temperature più alte e trattamenti termici successivi, come la pastorizzazione, possono ulteriormente accentuare queste riduzioni.
Tabella 2
Analisi compositiva del vino bianco e dei relativi campioni dealcolati a 20 °C e 25 °C, forniti dall’Azienda B
Figura 1
Contenuto dei principi attivi nel vino bianco e nei relativi campioni dealcolati, forniti dall’Azienda A
Vino bianco
Vino bianco dealcolato + mosto (pre-pastorizzazione)
Vino bianco dealcolato
Vino bianco dealcolato + mosto (post-pastorizzazione)
Figura 2
Contenuto dei principi attivi nel vino bianco e nei relativi campioni dealcolati, forniti dall’Azienda B

Il vino in PET: opportunità, criticità e nuove sfide
MAURO PAOLINI
ROBERTO LARCHER
La crisi energetica che ha investito l’Europa, innescata dalle difficoltà di approvvigionamento di gas naturale e sabbie silicee – in passato fornite prevalentemente da aree oggi coinvolte nel conflitto russo-ucraino – ha dato nuovo impulso alla ricerca di materiali alternativi al vetro per la produzione di contenitori alimentari e per bevande. Tra i settori maggiormente interessati da questa evoluzione c’è sicuramente quello enologico. Da anni, infatti, si sperimenta l’utilizzo di soluzioni più economiche e leggere, soprattutto per vini destinati a un consumo giovane e rapido. Le opportunità offerte da materiali alternativi riguardano non solo l’ideazione di nuovi formati e prodotti, ma anche ambiti specifici come eventi, catering, trasporto aereo o mercati in cui riciclabilità e leggerezza rappre-
sentano un vantaggio competitivo, o un requisito normativo. La bottiglia in PET (polietilene tereftalato), infatti, è più leggera anche del 70-80% rispetto alla tradizionale bottiglia in vetro e comporta costi di trasporto nettamente inferiori, a parità di volume. In questo contesto, la bottiglia in plastica, in particolare quella realizzata in PET con barriere che ne limitano la permeabilità all’ossigeno, si sta dimostrando una valida alternativa per alcune categorie di vino. Già ampiamente utilizzato per acqua minerale, soft drink e succhi di frutta, il PET è un materiale trasparente, colorabile, leggero, resistente agli urti e adatto sia al riempimento a freddo che a caldo. Per l’uso enologico, esistono bottiglie in PET specificamente progettate, spesso dotate di barriere supplementari
– come coating superficiali o strati di EVOH o nylon – in grado di contenere la permeabilità all’ossigeno, preservando la stabilità dell’anidride solforosa e limitando la perdita di anidride carbonica, con effetti positivi su freschezza ed eventuale effervescenza. Ben più complessa, sia sotto il profilo tecnologico che in relazione alla sensibilità del consumatore tradizionale, è invece l’applicazione di questi contenitori per vini di pregio o da invecchiamento.
In termini generali, la letteratura scientifica evidenzia come il PET monostrato sia adatto esclusivamente a shelf life brevi (3-6 mesi), e quindi indicato solo per vini giovani da consumo immediato. Viceversa, il PET multistrato o dotato di coating specifici (EVOH, SiOx, carbon coating, ecc.) può garantire shelf life sensibilmente più lunghe, fino a 12-18 mesi, a seconda del tipo di vino e delle condizioni di conservazione (buio, temperatura controllata). Indipendentemente dalla tipologia di vino, è comunque essenziale valutare con attenzione la natura dei materiali in commercio e le modalità di confezionamento della bottiglia, in relazione sia alla possibile migrazione di sostanze indesiderate sia alla permeabilità ai gas. Rispetto ad altre bevande, infatti, la componente alcolica del vino ne accresce la capacità solvente, aumentando il rischio di rilascio di composti come monomeri del materiale plastico, acetaldeide o antimonio (quest’ultimo usato come catalizzatore nella produzione del PET).
L’impiego di materiali non adeguatamente ingegnerizzati, unitamente a condizioni sfavorevoli come alte temperature, esposizione alla luce, lunghi periodi di conservazione o elevata gradazione alcolica, rappresenta sempre un potenziale fattore di rischio. Gli studi condotti presso il Laboratorio chimico della Fondazione Mach mostrano come alcune tipologie di vino, in particolare i rossi dotati di una struttura compositiva più complessa, possano rispondere molto positivamente alla conservazione in bottiglie in PET multistrato. Il confronto con l’equivalente conservato in vetro du-
rante un invecchiamento forzato non ha evidenziato differenze significative in termini di livelli di solforosa, colore, profili polifenolici o valutazioni sensoriali. Le eventuali cessioni di sostanze dal contenitore, pur presenti, si sono mantenute entro livelli estremamente contenuti, spesso al limite della rilevabilità strumentale. Sono previste prossimamente indagini specifiche anche sui vini bianchi, che, a causa della loro struttura più delicata e meno protetta, richiederanno valutazioni più approfondite, in particolare per quanto riguarda la conservazione degli aromi che caratterizzano alcune varietà. In conclusione, laddove il consumatore o eventuali normative locali, per rispondere a esigenze di sostenibilità energetica, economica o ambientale, richiedano l’impiego di materiali alternativi al vetro per il confezionamento del vino in bottiglia, appare tecnicamente ragionevole l’adozione di polietilene tereftalato multistrato con barriere antiossigeno, almeno per i vini rossi destinati a un consumo rapido. Tuttavia, nelle valutazioni strategiche delle aziende andranno necessariamente considerati ulteriori aspetti che potranno in futuro modificare, in senso negativo, le scelte d’acquisto del consumatore e l’opinione pubblica, in particolare in relazione ai temi del rischio di assunzione di microplastiche negli alimenti, dell’efficacia del riciclo di questi materiali e della loro possibile dispersione incontrollata nell’ambiente.


MARIO MALACARNE
Nuove disposizioni per l’etichettatura del vino: ingredienti e tabella nutrizionale
Figura 1
Alcuni esempi di tabella nutrizionale: a) vino bianco secco; b) vino rosso secco; c) vino spumante brut; d) vino passito.
La voce “carboidrati” è data dalla somma di zuccheri (glucosio e fruttosio) e glicerina, espressi in g/100 ml

Vino bianco
La crescente attenzione da parte dei consumatori per le informazioni sul contenuto degli alimenti ha spinto il Parlamento Europeo ad ampliare le indicazioni obbligatorie anche per i prodotti vitivinicoli. Il Regolamento (UE) 2021/2117 ha infatti previsto che, a partire dal 8 dicembre 2023, le etichette dei vini debbano riportare l’elenco degli ingredienti e la dichiarazione nutrizionale.
Per una corretta compilazione della lista ingredienti è fondamentale distinguere tra additivi e coadiuvanti tecnologici. Gli additivi diventano parte integrante dell’alimento e vanno quindi sempre indicati in etichetta; i coadiuvanti, invece, svolgono una fun-

D ichiarazione nutrizionale
Valori nutrizionali me di pe r 100 ml
d i cu i:
d i cu i: zu cch eri 0,3 g
zu cch eri 0,3 g
p ro t ein e 0 g s ale 0 g

Co n t ien e qu an t it à t ras cu rab ili
d i g rass i, acid i g rass i s at u ri, p ro t ein e e s ale
c) Vino s pumante brut Val ore Val ore energ eti co
Glu
D ichiarazione nutrizionale
nutrizionali
en erg ia 308 kJ / 74 kcal oppure
g rass i 0 g
d i cu i: en erg ia 308 kJ / 74 kcal acid i g rass i s at u ri 0 g carb o id rat i 1,5 g carb o id rat i 1,5 g d i cu i:
zione tecnologica nella lavorazione o trasformazione dell’alimento, ma non sono costituenti del prodotto finale e pertanto non devono comparire nell’elenco. Gli ingredienti ammessi nei prodotti vitivinicoli sono elencati nel Regolamento (UE) 2019/934, Allegato 1, parte A, Tabella 2, contrassegnati con il segno “x” nella colonna “Additivo”. Per la tabella nutrizionale, il riferimento normativo è il Regolamento (UE) 1169/2011, valido per tutti gli alimenti, che riporta le indicazioni obbligatorie e i criteri per il calcolo e l’espressione dei diversi valori. La dichiarazione nutrizionale obbligatoria reca le indicazioni seguenti: a) il valore energetico; e
b) Vino ros s o s e cco Val ore Val ore energ eti co
Tit o lo alco lo met rico vo lu mico (% vo l)
A cid it à t o t ale (in acido t art arico ) (g / l)
Glicerin a (g / l) 8,9 2,1 8,9 Glu co s io e Fru tt o s io (g / l)
D ichiarazione nutrizionale
Valori nutrizionali me di pe r 100 ml
en erg ia 327 kJ / 79 kcal oppure
g rass i 0 g
,6
d i cu i: en erg ia 327 kJ / 79 kcal
acid i g rass i s at u ri 0 g carb o id rat i 1 0 g carb o id rat i 1,0 g d i cu i:
d i cu i: zu cch eri 0,1 g
zu cch eri 0,1 g p ro t ein e 0 g s ale 0 g

A cid it à t o t ale (in acido t art arico ) (g / l)
Co n t ien e qu an t it à t ras cu rab ili d i g rass i, acid i g rass i s at u ri, p ro t ein e e s ale k cal/ 100 ml k J / 100 ml
Carboidrati (ad esclusione dei
b) la quantità di grassi, acidi grassi saturi, carboidrati, zuccheri, proteine e sale.
Va sottolineato che i valori nutrizionali dichiarati non devono essere determinati per ciascun lotto di produzione, ma rappresentano valori medi calcolati, a seconda dei casi, sulla base:
a) dell’analisi dell’alimento effettuata dal fabbricante;
b) del calcolo effettuato a partire dai valori medi noti o effettivi relativi agli ingredienti utilizzati; oppure c) del calcolo effettuato a partire da dati generalmente stabiliti e accettati. I coefficienti di conversione per il calcolo dell’energia sono riportati nell’Allegato XIV dello stesso Regolamento (Tabella 1).
Nel caso del vino, la Risoluzione OIV-ECO 676-2024 precisa che “i vini non contengono grassi e sale in quantità misurabili e possono contenere solo tracce di proteine. Perciò, nella dichiarazione nutrizionale la quantità di questi nutrienti può essere indicata utilizzando il valore “0”, o sostituendola con una dicitura del tipo ‘Contiene quantità trascurabili di...’ apposta in prossimità
della dichiarazione nutrizionale”.
Alla luce di quanto esposto, e tenendo conto delle sostanze presenti nel vino in concentrazioni significative, per predisporre la tabella nutrizionale è sufficiente determinare analiticamente, per ciascuna etichetta prodotta, i valori medi dei seguenti parametri:
• titolo alcolometrico volumico;
• acidità totale;
• zuccheri (glucosio e fruttosio, o glucosio e fruttosio dopo inversione negli spumanti);
• glicerina (carboidrato diverso dagli zuccheri).
Una volta espressi in grammi per 100 ml (g/100 ml), questi dati consentono di calcolare il valore energetico e di completare la dichiarazione nutrizionale secondo quanto previsto dalla normativa citata, come mostrato per alcune tipologie di vino negli esempi di Figura 1.
Presso il Laboratorio di Chimica Vitienologica e Agroalimentare del Centro Trasferimento Tecnologico è possibile richiedere il supporto analitico necessario per la redazione della dichiarazione nutrizionale per tutte le tipologie di vino.

Tabella 1
Coefficienti di conversione per il calcolo dell’energia degli alimenti (Regolamento (UE) 1169/2011, Allegato XIV)

Succo d’arancia e di limone: gli
isotopi
del carbonio nella determinazione della loro autenticità
SILVIA PIANEZZE
MATTEO PERINI
DOMENICO MASUERO*
LUANA BONTEMPO*
* Centro Ricerca e Innovazione, Fondazione Edmund Mach
Secondo il Report ISMEA 2024 (www. ismeamercati.it), gli agrumi costituiscono il 6% del valore della spesa delle famiglie italiane per quanto riguarda la componente ortofrutticola. Nella medesima componente devono anche essere inclusi i succhi e le conserve che derivano dalla lavorazione di queste materie prime e che rappresentano complessivamente l’8% della componente ortofrutticola della spesa. È pertanto di facile intuizione che arance e limoni siano prodotti apprezzati e ricercati dal consumatore.
Le proprietà e la pregiatezza degli agrumi italiani hanno portato alla definizione di prodotti DOP e IGP per entrambe le categorie, tra cui vengono annoverati l’Arancia Rossa e il Li-
mone di Sicilia IGP, l’Arancia di Ribera DOP e l’Arancia del Gargano IGP, ma anche il Limone Costa d’Amalfi DOP e il Limone dell’Etna DOP. Il consumatore è generalmente disposto a pagare un extra non solo per prodotti legati ad una particolare certificazione di qualità, ma anche per eccellenze naturali, organiche e senza additivi (Simão et al. 2022 SPC 34:505-517). Tra gli additivi che possono essere utilizzati per migliorare le proprietà o allungare i tempi di conservazione dei succhi di frutta troviamo l’acido citrico, la cui aggiunta è consentita senza restrizioni relative alla sua quantità od origine (Reg. EU 1129/2011). Arance e limoni contengono già naturalmente questo particolare composto, che può però essere aggiunto ai suc-

chi come conservante e correttore di acidità (E330). L’acido citrico che viene utilizzato come additivo viene principalmente prodotto per via biosintetica dalla fermentazione di materie prime a basso costo (come lo zucchero di canna) da parte del fungo Aspergillus niger (www.thebusinessresearchcompany.com).
Sulla base di queste affermazioni, è lecito chiedersi se un succo contenente questo tipo di additivo possa essere pubblicizzato come “100% naturale”. In ogni caso, il consumatore dovrebbe essere informato sull’origine degli ingredienti presenti nei prodotti che acquista quotidianamente, per poter compiere scelte quanto più consapevoli possibile. Ne consegue che sia indispensabile innanzitutto una legislazione chiara su quali prodotti possano essere
considerati davvero “100% naturali”, e di conseguenza una tecnica che permetta di individuare l’aggiunta di acido citrico di biosintesi nei prodotti commerciali.
L’analisi isotopica è stata utilizzata, nel corso degli ultimi decenni, come metodo per la rivelazione di aggiunte di ingredienti esogeni in molte matrici alimentari. Si è rivelata particolarmente utile per determinare l’aggiunta di zuccheri esogeni in matrici come vino, mosto, aceto e succo (Roncone et al. 2025 Beverages 11(3):89) e per rivelare l’aggiunta di composti derivanti da biosintesi in integratori alimentari come riso rosso fermentato (Perini et al. 2017 Talanta 174:228-233) e teanina (Perini et al. 2021 J. Food Drug Anal. 29(2):311-318). Allo stesso modo, l’analisi isotopica è in grado di determinare se l’acido citrico aggiunto ai
Figura 1
Acido citrico nei campioni autentici di succo di arancia e limone

succhi di frutta sia di origine vegetale o se sia stato prodotto tramite Aspergillus niger
In uno studio condotto nel 2024 presso i laboratori di analisi isotopica della Fondazione Mach, sono stati presi in considerazione 62 campioni di autentico succo italiano, divisi tra succo d’arancia (N = 34) e succo di limone (N = 28), al fine di determinare dei range di valori isotopici rappresentativi dei due tipi di prodotti. I campioni sono stati raccolti in diverse annate nelle regioni italiane più rinomate per la produzione di agrumi, quali Sicilia, Puglia, Campania e Calabria. Il rapporto isotopico del carbonio (δ13C‰, Figura 1) dell’acido citrico presente naturalmente nei campioni è stato misurato tramite cromatografia liquida accoppiata alla spettrometria di massa isotopica (LC-co-IRMS). Una
volta stabiliti i limiti per i prodotti autentici, sono stati analizzati 23 campioni di succo disponibili sul mercato, in modo da valutare se l’acido citrico contenuto in essi fosse di origine naturale o fungina.
Lo studio ha rivelato che nel 38% dei campioni di succo di limone e nell’ 80% dei campioni di succo d’arancia sono stati riscontrati valori fuori dai range stabiliti per questo particolare tipo di prodotti. È da sottolineare che, considerato il numero esiguo di campioni commerciali considerati, questi non possono essere considerati rappresentativi del mercato. Il risultato dello studio costituisce tuttavia un punto di partenza per uno studio più approfondito del tema e fornisce un metodo analitico per la rivelazione di acido citrico di biosintesi nei succhi di arancia e limone.

Additivi, cottura e digestione: come nascono le nitrosammine nella carne
Nitrosamine formation in different meat treatments: the role of additives, cooking and digestion
This study investigated the formation of 15 nitrosamines in different meat products subjected to various treatments (raw, cooked, and gastric digestion). Veal, pork treated with ascorbate, pork treated with nitrites, and pork treated with both ascorbate and nitrites were analyzed using LC-HRMS with dual ionization modes. Results highlighted the complex and multifactorial nature of nitrosamine generation, strongly influenced by additive types, cooking, and gastric digestion. Ascorbate exhibited a dose-dependent dual role, acting either as an antioxidant or a pro-oxidant. Spinach, chosen as a dietary model rich in nitrates, added further reactive complexity. However, it did not enhance the synergistic effects observed with pure nitrites and instead reduced the total content to below 17 µg/kg. Overall, the findings emphasize the need to critically reassess nitrite use and to carefully evaluate alternative preservation strategies.
Le nitrosammine (NAs) costituiscono un gruppo di composti di grande rilevanza tossicologica, oggetto di attenzione da parte di enti regolatori e comunità scientifica per il loro potenziale cancerogeno. Nei prodotti a base di carne la loro presenza rappresenta un problema complesso, che intreccia aspetti tecnologici, nutrizionali e di sicurezza alimentare (IARC
TIZIANA NARDIN
ROBERTO LARCHER
FRANCESCA MARTINELLI
JAKOB FRANCESCHINI*
* Tesista Università di Ferrara
Figura 1
Box plot dei contenuti totali di nitrosammine rilevate nelle carni trattate con diversi conservanti
2
Box plot dei contenuti totali di nitrosammine rilevate nelle carni diversamente preparate
Monographs 2018 Vol. 114). I nitriti e i nitrati vengono infatti impiegati da decenni come additivi conservanti, per garantire stabilità microbiologica contro microrganismi patogeni, preservare le caratteristiche organolettiche e conferire il tipico colore rosato delle carni trasformate. Tuttavia, la stessa presenza di queste molecole precursori, in combinazione con ammine secondarie naturalmente presenti nei tessuti animali, può portare alla formazione di nitrosammine soprattutto in condizioni favorevoli come alte temperature o pH acido. Da ciò deriva l’attualità scientifica e tecnologica di studi che esplorino in modo sistematico l’entità del fenomeno, i fattori che lo influenzano e i
possibili approcci di mitigazione. In questo lavoro sono state considerate quattro tipologie di carne scelte per la loro rappresentatività nei confronti del consumatore: vitello (spezzatino), maiale trattato con ascorbato (15 mg/kg, lucanica fresca), maiale trattato con nitriti e nitrati (15+15 mg/ kg, salsiccia), e maiale trattato con una combinazione di ascorbato e nitriti (15+300 mg/kg, salsiccia). Queste categorie riflettono scenari reali di mercato e permettono di confrontare situazioni con e senza additivi, inclusa la valutazione di interazioni fra composti con funzione potenzialmente opposta (inibente per l’ascorbato, nitrosante per i nitriti). Per ciascuna tipologia sono stati previsti quattro sta-
ti di lavorazione: carne cruda, carne cotta, carne cruda sottoposta a digestione gastrica simulata e carne cotta seguita da digestione gastrica. Tale disegno sperimentale ha permesso di mettere a confronto direttamente le condizioni che il consumatore può realisticamente incontrare.
Le analisi sono state eseguite mediante cromatografia liquida accoppiata a spettrometria di massa ad alta risoluzione (LC-HRMS), impiegando sia la ionizzazione elettrospray riscaldata (HESI) sia la ionizzazione chimica a pressione atmosferica (APCI). Questa doppia strategia ha consentito di ampliare la copertura analitica, tenuto conto della variabilità chimico-fisica delle diverse NAs. In totale sono state incluse 15 nitrosammine, rappresentative sia delle più note pericolose a livello tossicologico (come NDMA e NDEA, Gruppo 2A IARC (IARC Monograph 2007 Volume 89) sia di altre meno studiate, ma comunque rilevanti per la comprensione globale del fenomeno comprendendo sia NA volatili che non volatili.
I risultati ottenuti hanno messo in evidenza una notevole complessità. Nel vitello le concentrazioni di NAs sono risultate minime, in alcuni casi sotto il limite di quantificazione e comunque mai sopra i 3 µg/kg (Figura 1). Solo dopo cottura o digestione si sono rilevate tracce di alcuni composti, a conferma che l’assenza di nitriti riduce drasticamente la possibilità di formazione. Nella lucanica fresca l’aggiunta di ascorbato senza nitriti ha confermato un ruolo prevalentemente protettivo: le NAs sono risultate poco presenti, sebbene la digestione gastrica abbia rivelato la comparsa di alcuni segnali non osservabili nello stato crudo, probabilmente legati all’azione catalitica di metalli di transizione che in ambiente acido possono trasformare l’ascorbato da antiossidante a pro-ossidante.
Nella salsiccia trattata con nitriti le differenze sono state invece nette. In condizioni crude le concentrazioni erano già rilevabili, ma la cottura non ha determinato incrementi sostanziali. È stato durante la digestione gastri-
ca che si è osservato il maggiore aumento, con un profilo più ricco di NAs e concentrazioni superiori (13 µg/kg totali). Questo conferma che il pH gastrico e la disponibilità di nitriti liberi sono i fattori principali di rischio. Quando ascorbato e nitriti sono stati combinati, i risultati hanno mostrato una dinamica bifasica: in alcuni casi l’ascorbato ha effettivamente ridotto la formazione, ma in presenza di livelli elevati di nitriti il suo ruolo si è ribaltato, con incremento di specifiche NAs, fino a 70 µg/kg, coerente con una funzione pro-ossidante dose-dipendente. Un ulteriore elemento innovativo dello studio è stato l’utilizzo degli spinaci come modello vegetale ad alto contenuto di nitrati. I risultati hanno evidenziato che l’aggiunta di spinaci non determina effetti sinergici superiori rispetto all’impiego diretto di nitriti, ma introduce una maggiore complessità reattiva, con la comparsa di nitrosammine specifiche durante la digestione. Nel complesso, tuttavia, i livelli rimangono sempre inferiori a 17 µg/kg totali. Questo suggerisce che la dieta, attraverso alimenti ricchi di nitrati, possa modulare la formazione di NAs in maniera non lineare, mantenendo comunque valori molto contenuti grazie al probabile contributo di polifenoli e/o altri antiossidanti. Dal punto di vista tecnologico, i risultati sottolineano la necessità di bilanciare attentamente i benefici dell’impiego di nitriti come additivi, indiscutibilmente utili per la sicurezza microbiologica, con i rischi derivanti dal loro ruolo di precursori delle NAs. Allo stesso tempo, mostrano che soluzioni alternative come l’impiego di ascorbato o di fonti naturali di nitrati non sono intrinsecamente prive di rischi, ma devono essere considerate nel contesto delle condizioni chimico-fisiche che ne modulano l’effetto. Lo studio fornisce quindi un contributo significativo alla comprensione delle dinamiche di formazione delle nitrosammine (Nardin et al. 2025 Molecules 30:4107), offrendo basi sperimentali utili per orientare future strategie di mitigazione e per supportare una valutazione regolatoria più consapevole.
SILVIA PIANEZZE
MATTEO PERINI
LUANA BONTEMPO*
* Centro Ricerca e Innovazione, Fondazione Edmund Mach
L’analisi isotopica per la tracciabilità della carne
Isotopic analysis for meat traceability
The need to guarantee the geographical origin of food samples has become imperative in recent years due to the increasing amount of food fraud. Stable isotope ratio analysis permits the characterization and origin verification of animal products by distinguishing between samples from different geographical origins and production systems. The stable isotope analysis combines the isotope ratio mass spectrometry (IRMS) with a thermal conversion elemental analyzer (TC/EA) for measuring δ2H and δ18O, or with an elemental analyzer (EA) for determining δ13C, δ15N, and δ34S. The results indicate that this technique has the potential to identify clusters of samples due to specific environmental conditions in the areas where the animals were reared.
Da decenni lo studio degli isotopi stabili ha contribuito notevolmente all’incremento della fiducia del consumatore nella sicurezza e nella qualità dei prodotti di origine animale. Grazie alle preziose informazioni che l’analisi isotopica può fornire, essa ha avuto un ruolo fondamentale nell’identificazione di fonti di contaminazione, falle nel sistema di qualità e dichiarazioni volontariamente o accidentalmente errate associate ai prodotti animali (Kendall et al. 2019 TIFS 94:79-90).
Nel corso degli ultimi decenni, questa tecnica è stata applicata con successo nella tracciabilità della carne suina, bovina, ovina e avicola (Camin et al. 2016 Compr. Rev. Food Sci. Food Saf. 5:868-877).
Gli isotopi che vengono presi in considerazione quando si parla di tracciabilità della carne sono solitamente quelli di carbonio (δ13C), azoto (δ15N) e zolfo (δ34S), nel caso in cui si vogliano avere informazioni relative alla dieta dell’animale, mentre gli isotopi di ossigeno (δ18O) e deuterio (δ2H) entrano in gioco nel caso in cui si voglia approfondire l’origine geografica della carne. Entrambe le informazioni, tanto la dieta a cui sono stati sottoposti gli animali, quanto la loro origine geografica, sono spesso associate a certificazioni come la DOP (Denominazione di Origine Protetta) e la IGP (Indicazione Geografica Protetta) (Flinzberger et al. 2024 J. Land Use Sci. 19(1):59-77).
Uno studio pubblicato nel 2023 all’in-
terno del progetto TRACE (Bontempo et al. 2023 Molecules 28(6):2856), condotto presso la Fondazione Mach in collaborazione con altri laboratori europei, ha permesso di analizzare i valori isotopici di 227 campioni di carne bovina campionati in 13 siti dislocati in 8 stati (Irlanda, Regno Unito, Francia, Spagna, Germania, Austria, Italia e Grecia). I campioni sono stati divisi in tre gruppi corrispondenti ad aree caratterizzate da parametri geografici simili e sistemi di allevamento confrontabili, al fine di caratterizzare al meglio i campioni. I gruppi di campioni sono così descritti e rappresentati in Figura 1:
• Gruppo A: animali provenienti da zone costiere a basse latitudini, alimentati con una dieta basata principalmente su piante a ciclo fotosintetico C4 (come ad esempio il mais);
• Gruppo B: animali provenienti da zone costiere situate a più alte latitudini rispetto al gruppo A, alimentati con una dieta basata principalmente su piante a ciclo fotosintetico C3 (come ad esempio il fieno o, in generale, le specie di piante comunemente presenti nei pascoli europei);
• Gruppo C: animali provenienti da zone dell’entroterra alimentati con una dieta mista.
In questo studio, gli isotopi di carbonio e idrogeno hanno contribuito in modo significativo a distinguere i
gruppi di campioni. Le differenze riscontrate sono il risultato della combinazione tra il regime alimentare a cui gli animali sono stati sottoposti e le condizioni climatiche caratteristiche delle zone in cui essi sono stati allevati. L’analisi isotopica, in questo contesto, si è confermata capace di distinguere tra campioni provenienti da regioni costiere e dell’entroterra, da aree caratterizzate da diverse latitudini o sottoposte a diversi tipi di allevamento, fornendo importanti informazioni per la caratterizzazione della carne bovina.
Un’ulteriore collaborazione del 2023 (Smeti et al. 2023 Molecules 28(4):1847) ha fornito la possibilità di valutare l’efficacia degli isotopi stabili nella tracciabilità della carne ovina proveniente dalla Tunisia. Lo scopo dello studio è stato quello di distinguere tra il rinomato agnello Djebel (D, Figura 2) e la carne ovina prodotta in due diversi siti tunisini, Bou-Rebiaa (BR, Figura 2) e Ouesslatia (O, Figura 2). La differenza tra i prodotti non consiste solo nelle diverse caratteristiche geografiche dei siti dove gli animali sono stati allevati, ma anche nella dieta a cui gli stessi sono stati sottoposti. Infatti, l’agnello Djebel viene fatto pascolare nelle foreste della Tunisia, dove abbondano varietà di alberi e disponibilità di piante e frutti, come le ghiande. Questa particolare dieta si traduce in una carne di alta qualità e dal sapore unico, che viene apprezzata e ricercata dal consumatore. Lo studio ha permesso
di discriminare i tre diversi gruppi sia sulla base della loro origine geografica (grazie agli isotopi di ossigeno e deuterio), sia della loro specifica dieta (sulla base degli isotopi di carbonio e azoto).
In questo modo, il pregiato prodotto Djebel può essere protetto da eventuali frodi, tutelando tanto i produttori quanto i consumatori.
Oltre ai prodotti di origine ovina e bovina, anche la carne suina è stata presa in considerazione in una collaborazione del 2024 con l’Università degli Studi di Messina (Litrenta et al. 2025 J. Food Compos. Anal. 137).
In questo studio è stata riconosciuta la necessità di trovare un metodo analitico che garantisse la tutela del “Nero dei Nebrodi”, rinomata carne della Sicilia. Nello specifico, lo scopo è stato quello di individuare specifiche caratteristiche di questo prodotto che contribuissero alla sua tracciabilità per proteggere il consumatore da frodi e per tenere a freno dispute commerciali. I campioni allevati all’interno del Parco Nazionale dei Nebrodi sono stati pertanto messi a confronto con i campioni siciliani allevati al di fuori della suddetta zona e, in particolare, nella Valle del Mela Areale. In questo studio, i rapporti isotopici di carbonio, azoto, ossigeno e idrogeno sono stati efficaci nella discriminazione dei due gruppi in oggetto, permettendo di individuare quali campioni provenissero dalla zona dei Nebrodi e quali invece ne fossero esclusi.
Figura 1
Analisi delle Componenti Principali (PCA) della composizione isotopica dei campioni




Secondo il report dell’Istituto dei Servizi per il Mercato Agricolo Alimentare (ISMEA) riferito all’anno 2023, il settore della produzione animale in Italia genera introiti per oltre 30 miliardi di euro. La grande importanza economica di questo settore richiede
lo sviluppo di nuove tecniche per la tutela di produttori e consumatori. In questo contesto, l’analisi isotopica si rivela ancora una volta uno strumento efficace per lo studio della tracciabilità e rintracciabilità dei prodotti di origine animale.

La razza Rendena: patrimonio genetico e adattamento all’ambiente
La vacca Rendena è conosciuta per la sua longevità, fertilità, resistenza alle malattie e adattabilità alle situazioni di alpeggio più estreme. Classificata come razza “vulnerabile all’estinzione”, nel 2024 conta 6.086 capi iscritti al libro genealogico, di questi 4.092 sono femmine con più di 24 mesi (fonte dati AIA 2024).
Il progetto RENDENAGEN (collaborazione fra Università Cattolica di Piacenza, di Padova e di Pavia e la FEM), nato per approfondire le caratteristiche genetiche della razza Rendena ha dato alcuni importanti risultati, frutto di una recente pubblicazione (Somenzi et al. 2024 GSE 56:32).
L’analisi delle sequenze di DNA evidenzia le particolarità genetiche della Rendena rispetto ad altre razze e riflette la selezione praticata dagli allevatori nel corso dei secoli. Selezione mirata sì alla produzione di latte e carne, ma anche all’adattamento all’ambiente alpino e alla resistenza alle malattie. Preservare queste caratteristiche genomiche è essenziale non solo per mantenere la diversità genetica e la capacità di adattamento ai cambiamenti climatici, ma anche per garantire la resilienza e la sostenibilità del sistema zootecnico alpino e delle comunità che su di esso insistono nell’area della Val Rendena.
Lo starter Fermalga, un aiuto per potenziare la difesa naturale del formaggio “Trentino di Malga”
Il formaggio nostrano, prodotto in tutte le malghe trentine, è una “perla di tradizione” viva e molto ricercata dal consumatore. Per migliorarne la sicurezza microbiologica senza compromettere la tipicità, è stato sviluppato lo starter Fermalga (FMG), costituito da ceppi autoctoni selezionati. Questo studio confronta formaggi prodotti con FMG (F-FMG) e senza starter (CTRL), usando lo stesso latte di malga e monitorando l’evoluzione microbica durante 3 mesi di stagionatura. Le produzioni con lo starter Fermalga
(FMG) hanno mostrato un’acidificazione più rapida e controllata, migliorando lo spurgo del siero e la sicurezza microbiologica. FMG favorisce una maggiore presenza e persistenza di batteri lattici utili e limita lo sviluppo di specie indesiderate come coliformi ed enterococchi, migliorando qualità e stabilità del formaggio rispetto ai campioni senza starter. I risultati indicano quindi che l’uso di FMG favorisce una selezione microbica positiva, mantenendo l’identità del prodotto e migliorandone la sicurezza.
* Centro Ricerca e Innovazione, Fondazione Edmund Mach

Quanto la gestione in stalla può limitare la presenza di Escherichia coli STEC nel latte?
INGRID RONER
MASSIMILIANO MAZZUCCHI
ERIKA PARTEL
NICOLA SANDRI
GABRIELE IUSSIG
How much can barn management limit the presence of Escherichia coli STEC in milk?
To preserve Trentino’s traditional raw milk productions, an investigation was conducted to assess the presence of Shiga-toxin-producing E. coli (STEC) on dairy farms. Conducted by FEM and Con.Ca.S.T., the project involved 15 farms and 2 dairies over a span of 12 months. It assessed hygiene practices, milk quality, and the presence of STEC in feces, milking filters, and curds. While STEC was rarely found in feces, the filters showed high contamination rates. Milk quality, in terms of total coliform count, improved over the course of the project. Although there was no direct link to farm practices, improved hygiene and milking routines led to better milk quality and reduced STEC in raw milk curds. The study highlights the importance of effective management in maintaining dairy safety.
Gli Escherichia coli sono batteri appartenenti alla famiglia delle Enterobacteriaceae, il cui habitat naturale è rappresentato dall’apparato intestinale. Sebbene la maggior parte degli E. coli siano innocui, alcuni ceppi come gli E. coli produttori di Shiga-Tossina (STEC), sono agenti zoonosici in grado di produrre tossine pericolose per la salute umana (Farrokh et al. 2013 Int. J. Food Microbiol. 162(2):190-212). La diffusione del patogeno sembra
essere in aumento anche tra le produzioni a latte crudo che in Trentino, così come in altre zone montane, rappresentano un elemento identitario importantissimo nel contesto lattiero-caseario. Per cercare di tutelare queste produzioni, in provincia di Trento diversi enti stanno collaborando per mettere a punto un sistema di controllo “multi-ostacolo”, come suggerito da FAO e OMS, da applicare lungo tutta la filiera.
Nel 2023, la Fondazione Edmund Mach e il Consorzio dei Caseifici Sociali Trentini (Con.Ca.S.T.) hanno avviato un progetto annuale in 15 aziende e 2 caseifici. Gli obiettivi principali erano di investigare:
• la diffusione del patogeno nelle stalle trentine;
• l’eventuale correlazione tra la sua presenza e i parametri gestionali e di igiene;
• valutare l’efficacia delle azioni correttive messe in atto in caso di non conformità.
Nel corso del progetto sono stati campionati e analizzati mensilmente feci (prelevate con calzari) e filtri di mungitura con il fine di determinare la presenza/assenza del patogeno. In concomitanza è stato prelevato anche il latte di massa su cui si è valutata la conta batterica totale (CBT), la conta dei coliformi totali (CCT) e degli E. coli glucuronidasi positivi (CEC). Inoltre, in ogni azienda sono state condotte indagini e raccolte informazioni sugli aspetti strutturali e gestionali della mandria, dei locali e della routine di mungitura. Infine, sono stati elaborati i
dati riguardanti la presenza degli STEC nelle cagliate a latte crudo prodotte nei caseifici Trentingrana Con.Ca.S.T.
Cosa è stato osservato a livello aziendale
Ambienti non sovraffollati e una corretta pulizia di corsie, cuccette e abbeveratoi sono elementi in grado di ridurre la presenza del patogeno e la possibile contaminazione delle produzioni (Adam et al. 2010, Int. J. Food Microbiol. 141:43-52). Nel corso dell’indagine è stato osservato un progressivo miglioramento del grado d’igiene degli ambienti e un dimezzamento delle aziende che presentavano sovraffollamento. Inoltre, dalle valutazioni dell’Hygiene score condotte sulle mandrie è emerso che nelle aziende gli animali presentavano mediamente dei buoni valori di pulizia. Gli arti sono apparsi la parte anatomica più sporca e anche quella più soggetta a variazioni nel corso del tempo. La mammella, al contrario, è risultata la parte anatomica con punteggi medi che tendono a migliorare nel corso del tempo.
Per quanto riguarda la routine di mungitura durante il progetto sono stati valutati: rispetto dell’ordine e completezza delle fasi, corretto utilizzo dei prodotti e adeguata pulizia dei capezzoli. Nella Figura 1 è possibile apprezzare il netto miglioramento osservato nelle aziende tra il controllo iniziale e il ricontrollo a seguito della messa in pratica delle azioni correttive da parte degli allevatori. Anche l’indagine condotta sul sistema di la-
Figura 1
Percentuali di non conformità rilevate durante la routine di mungitura a maggio e novembre 2023 con riferimento ai tre aspetti più critici
Figura 2
Percentuali di non conformità rilevate in occasione dei controlli di maggio e novembre 2023, suddivise per parametro investigato
3
Percentuali di positività a E. coli STEC su filtri di mungitura e feci
vaggio degli impianti di mungitura ha mostrato progressi, con la risoluzione della maggior parte delle non conformità rilevate (Figura 2).
Osservando poi i risultati emersi dalle analisi condotte sul latte di massa si può affermare che: i valori di CBT sono sempre risultati conformi ai limiti di legge, la CEC è risultata sempre molto buona mentre un netto miglioramento è stato osservato tra il primo e il secondo semestre di progetto in termini di CCT. Nei primi sei mesi, diversi campioni superavano le 200 UFC/ml, mentre da metà progetto in poi l’86,7% dei campioni risultava inferiore alle 100 UFC/ml.
STEC nelle feci, nei filtri e nelle cagliate
I risultati riguardanti la ricerca degli STEC in feci e filtri di mungitura sono rappresentati in Figura 3. Pochi sono i mesi in cui i campioni di feci sono risultati positivi, tra l’altro con percentuali modeste ad eccezione di ottobre 2023 (46,7%) e marzo
2024 (26,7%). Al contrario, i filtri di mungitura da agosto 2023 ad aprile 2024 mostrano percentuali di positività sempre molto elevate: dal 40 al 64,3%. Ad oggi non è stato possibile individuare alcun fattore gestionale o d’igiene anomalo in grado di giustificare il repentino peggioramento avvenuto dopo i primi tre mesi di campionamento, in cui tutti i filtri erano risultati negativi. Sebbene inaspettata, la discordanza tra queste due matrici trova comunque conferma in recenti studi che hanno messo a confronto i medesimi punti di controllo (Jaakkonen et al. 2019 Appl. Environ. Microbiol. 85:e0291018; Sonnier et al. 2018 J. Dairy Sci. 101(3):1943-1956).
Per quanto riguarda l’analisi delle cagliate invece si registra un miglioramento complessivo in entrambi i caseifici oggetto di studio, sebbene nelle due realtà analizzate la situazione di partenza fosse molto differente (Tabella 1). Confrontando le percentuali minime, medie e massime nel
A
Caseificio B Cagliate
periodo pre-progetto (gennaio-aprile 2023) con quelle osservate nel periodo finale (gennaio-aprile 2024) ne emerge un netto miglioramento. Tale risultato è da attribuire esclusivamente alla gestione aziendale in quanto, nel corso del progetto né la modalità di trasformazione casearia, né le metodiche analitiche utilizzate sono state oggetto di variazione. In conclusione, rispetto agli obiettivi specifici del progetto sì può affermare che la presenza di STEC negli ambienti di stalla non è più da considerarsi una mera ipotesi, ma una certezza. Tuttavia, feci e filtri di mungitura non risultano essere un buon punto di controllo visti i risultati discordanti osservati tra le due matrici. Tale andamento non ha permesso di individuare a livel-
lo aziendale una correlazione diretta e puntuale fra i parametri gestionali e d’igiene analizzati e la presenza degli STEC su filtri e feci. Nonostante ciò, si può affermare che l’implementazione di azioni correttive in risposta alle criticità riguardanti le pratiche di allevamento, mungitura e conservazione del latte è in grado di ridurre il rischio di positività STEC nelle cagliate a latte crudo prodotte nei caseifici. Il progetto è stato finanziato da Con. Ca.S.T e parte delle analisi sono state condotte nell’ambito del progetto PNRR ONFOODS. I risultati del progetto sono stati pubblicati su due riviste del settore zootecnico (Roner et al. 2024 Stalle da latte (5): 44-48; Roner et al. 2024 L’allevatore Trentino 45 (4): 14-20).

Tabella 1
Confronto dei risultati in percentuale dei positivi conclamati nei tre periodi presi in esame, nei due caseifici aderenti al progetto

Il siero di latte
come risorsa: le
reazioni di Maillard
ROBERTO LARCHER
TIZIANA NARDIN
SARA BOLCHINI*
* Libera Università di Bolzano
Il crescente interesse mediatico per l’alimentazione e la produzione domestica dei cibi ha reso sempre più familiari, anche tra i non addetti ai lavori, le cosiddette reazioni di Maillard Queste reazioni, ben note nella chimica degli alimenti, sono responsabili della formazione del caratteristico colore dorato e dei profumi intensi che rendono appetitosi molti cibi cotti: pane, biscotti, arrosti, patatine, verdure grigliate, frutta caramellata, solo per citarne alcuni.
È però corretto ricordare che in alcune specifiche procedure di trasformazione non controllata le reazioni di Maillard possono rivelarsi non sempre benefiche. Se da un lato migliorano il profilo sensoriale degli alimenti, dall’altro possono dare origine, in certe condizioni, a composti indesiderati
o persino dannosi per la salute. È il caso, ad esempio, dell’acrilammide, sostanza potenzialmente tossica che si forma in seguito a riscaldamenti prolungati o eccessivi, soprattutto nei cibi fritti o cotti al forno. Queste reazioni non sono di tipo enzimatico, ma chimico: coinvolgono zuccheri riducenti (come il lattosio) e amminoacidi liberi (frequentemente la lisina), che reagiscono tra loro con maggiore intensità a temperature superiori ai 140 °C. Il risultato è una complessa cascata di trasformazioni, che porta alla formazione di un’ampia gamma di composti di neoformazione. Ne è un esempio il latte a lunga conservazione o in polvere, in cui le reazioni di Maillard provocano alterazioni di colore e gusto, oltre a una riduzione della solubilità e del valore nutrizio-
nale delle proteine, a causa della loro reticolazione. Anche il siero di latte, se sottoposto a riscaldamento, può dar luogo a processi analoghi.
Ogni anno, in Italia, oltre 2.500 caseifici producono circa 7 milioni di tonnellate di siero grezzo. Questo sottoprodotto della caseificazione o della produzione di yogurt (che rappresenta circa il 95% in volume del latte di partenza) è composto principalmente da acqua (circa 93%), lattosio (7-8%), proteine (5-12%), sali minerali (calcio, potassio, sodio, magnesio), amminoacidi liberi e tracce di grasso. La sua composizione varia a seconda del tipo di latte e del processo tecnologico adottato.
Attualmente, circa un terzo del siero prodotto in Italia è destinato all’alimentazione umana, attraverso la produzione di ricotta o la trasformazione in polvere di siero, impiegata in numerosi prodotti alimentari (dalla carne processata ai gelati). Altri impieghi riguardano i settori farmaceutico e cosmetico. I restanti due terzi, invece, vengono utilizzati come mangime per animali, con un ritorno economico però decisamente inferiore.
Un recente studio condotto dalla Fondazione Mach, in collaborazione con l’Università di Bolzano (gruppo del Prof. Matteo Scampicchio), ha indagato le potenzialità di valorizzazione del siero di latte attraverso l’attivazione controllata delle reazioni di Maillard, con l’obiettivo di ottenere nuove molecole dotate di proprietà antiossidanti e antiradicaliche. Questi composti, dopo opportuna separazione e purificazione, potrebbero essere impiegati come ingredienti funzionali per migliorare la conservabilità degli alimenti, prolungandone la shelf life e fungendo da conservanti naturali in linea con le moderne esigenze clean-label. In particolare, uno studio preliminare effettuato su miscele sintetiche di zuccheri riducenti (glucosio, fruttosio, ecc.) e vari amminoacidi ha permesso di chiarire
l’influenza di parametri quali temperatura, pH e tempo di riscaldamento sull’ottimizzazione della sintesi di queste molecole. L’attività antiossidante dei prodotti ottenuti è stata confermata mediante saggi condotti con un iniziatore radicalico. Applicando questi risultati al siero di latte, si è osservato che condizioni ottimali – pH vicino a 7, temperatura intorno ai 140 °C e un tempo di riscaldamento di circa 90 minuti – consentono la massima resa nella trasformazione del lattosio e di specifici amminoacidi (come arginina e istidina) nei prodotti desiderati.
Le analisi effettuate mediante cromatografia liquida accoppiata a spettrometria di massa ad alta risoluzione hanno permesso di identificare, tra i prodotti di Maillard, 28 molecole a basso peso molecolare (< 250 Da), tra cui la 2-pirrolo-carbossialdeide e un isomero del maltolo (prevalentemente nel siero vaccino), e ben 72 molecole ad alto peso molecolare (≥ 250 Da), con profili distinti a seconda della tipologia di siero analizzata. Tutti i composti individuati hanno mostrato una significativa capacità antiossidante, ma la loro abbondanza è risultata strettamente legata alla composizione iniziale del siero impiegato. Il siero di latte, spesso considerato un semplice sottoprodotto della caseificazione, si rivela quindi una risorsa preziosa per la produzione di molecole bioattive con proprietà antiossidanti. Questi composti potrebbero rappresentare un’alternativa naturale ai conservanti sintetici, rispondendo alle attuali esigenze di sostenibilità e trasparenza dell’industria alimentare. Il processo appare inoltre tecnicamente scalabile a livello industriale, aprendo la strada a nuove opportunità di valorizzazione di questa importante matrice.
Il presente lavoro è stato pubblicato su riviste internazionali (Bolchini et al. 2024 Molecules 29(20):4820; Bolchini et al. 2025 Foods 14(3):450).

L’identificazione di metodologie efficaci per lo studio dell’impatto ambientale dell’acquacoltura rappresenta un passo importante per disporre di strumenti utili alla valutazione dell’efficacia delle misure di mitigazione attuate dagli impianti.
LORENZO ROSSI
CRISTINA CAPPELLETTI
FRANCESCA CIUTTI
ANDREA CHEMELLO
FILIPPO FACCENDA
Progetto filiera ASTRO: attività 2024
ASTRO project: 2024 activities
The ASTRO project Work Package 1 (WP1) aimed to develop sustainable breeding protocols for Carpione (Salmo carpio). In 2024, activities focused on testing a special breeder diet (egg antioxidants and immunity) and establishing a reproduction protocol (selection, sperm activation, disinfection). Monitoring results revealed low fecundity and high weaning mortality. 2025 plans include improved male management and the use of live prey (Artemia) for weaning. External and internal collaborations will focus on histological and genetic analysis.
In summer 2024, biological and chemical analysis planned under WP2 were carried out in watercourses both upstream and downstream of trout farms effluents. IBE results did not detect substantial alteration caused by trout farm activity, while ICMi results highlighted the impact a little better, even if limited.
Nel corso del 2024 il progetto Filiera ASTRO è entrato nel pieno dell’attività. Sono di seguito descritti gli obiettivi realizzativi in cui è coinvolto il Centro Trasferimento Tecnologico.
OR1 - Innovazione di prodotto e della filiera: il carpione del Garda L’obiettivo realizzativo 1 del progetto
ASTRO prevede lo sviluppo di protocolli di allevamento standardizzati per il Carpione del Garda (Salmo carpio), una specie autoctona del Lago di Garda e attualmente in pericolo di estinzione. Il lavoro, portato avanti dalla Fondazione Edmund Mach (FEM), mira a rendere l’allevamento di questa specie economicamente sostenibile.
Nel corso del 2024, le attività si sono concentrate su diversi aspetti cruciali per migliorare la riproduzione e l’allevamento del carpione. In particolare: Alimentazione e dieta. È stata messa a punto una dieta specifica per i riproduttori, arricchita con ingredienti funzionali. Lo scopo della dieta è quello di favorire l’accumulo di antiossidanti nelle uova, che saranno poi successivamente utili durante la fase di alimentazione endogena delle larve e rafforzare il sistema immunitario dei riproduttori durante il periodo di stress rappresentato dalla lunga stagione riproduttiva Protocollo di riproduzione. È stato sviluppato un protocollo di riproduzione, grazie anche alla vicina collaborazione di allevatori esperti nella produzione di uova di salmonidi. Questo include la selezione dei riproduttori in base alla qualità visiva delle uova e dello sperma, l’uso di soluzioni attivanti per migliorare la mobilità dello sperma e l’impiego di disinfettanti a base di iodio per migliorare lo status sanitario delle uova e prevenire patologie nelle prime fasi di vita.
Monitoraggio delle fasi iniziali. Le uova e le larve sono state gestite direttamente nell’incubatoio FEM per monitorare da vicino le fasi di sviluppo e individuare criticità (Foto 1). I risultati preliminari hanno evidenziato una bassa fecondità e un’elevata mortalità all’inizio dello svezzamento. Per il 2025, si prevede di migliorare la gestione dei maschi al fine di migliorare la fecondità delle uova e di utilizzare prede vive, come l’artemia salina, per lo svezzamento delle larve.
Parallelamente all’attività sperimentale, sono state avviate importanti collaborazioni per approfondire la conoscenza di alcuni aspetti legati alla biologia della specie. In collaborazione con l’Università Politecnica delle Marche, è stato definito un protocollo per l’analisi istologica dei tessuti e l’analisi del profilo ormonale nelle femmine in diversi stadi del ciclo riproduttivo (immature, mature e post riproduzione) al fine di valutare le evoluzioni degli organi e ormoni target. Pertanto, sono stati effettuati i primi
campionamenti per mettere a punto le metodiche analitiche. Insieme all’Unità Genomica della conservazione del Centro Ricerca e Innovazione FEM, è stato definito il protocollo sperimentale per l’analisi genetica del carpione. L’obiettivo è quello di distinguere tra soggetti selvatici e quelli selezionati per l’allevamento, contribuendo così alla conservazione della biodiversità genetica della specie.
OR2 - Intervento di sostenibilità ambientale per le acque
L’obiettivo realizzativo 2 del progetto ASTRO è incentrato sul miglioramento della sostenibilità degli allevamenti, sulla valutazione dell’impatto legato all’acquacoltura in presenza o meno di interventi di mitigazione e sull’applicazione e lo sviluppo delle metodologie di indagine biologica più idonee.
Nel corso del 2024 è stata avviata appieno la fase sperimentale del progetto, come di seguito descritto. Monitoraggio esteso delle troticolture. Durante l’estate, nel periodo della magra idrologica, su diversi corsi d’acqua della provincia di Trento caratterizzati dalla presenza di troticolture, sono state effettuate le indagini a monte e a valle degli impianti ittici. In particolare, oltre alle analisi chimico-fisiche e microbiologiche dell’acqua, sono state effettuate le analisi biologiche della comunità dei macroinvertebrati con metodo I.B.E. e la prima delle tre campagne di campionamento previste per le dia-

Foto 1
Esempio di uova embrionate di carpione del Garda durante la fase di pulizia pre-schiusa
Tabella 1
Analisi biologiche dei corsi d’acqua (I.B.E. e ICMi) a monte e a valle delle troticolture indagate
tomee, seguite dall’analisi dei campioni in laboratorio.
Monitoraggio su un sottoinsieme di troticolture che attueranno miglioramenti impiantistici finalizzati alla riduzione degli impatti (es. filtri). Nel corso dell’estate, su questo sottogruppo di corsi d’acqua, oltre alle analisi previste nel monitoraggio esteso, è stata effettuata la prima delle tre campagne previste della fase pre-intervento. A monte e a valle degli impianti sono state condotte anche analisi quantitative della comunità dei macroinvertebrati e analisi quantitative sul periphyton (es. clorofilla).
Lo studio è svolto in collaborazione con l’Unità Idrobiologia del CRI, che sui campioni dei macroinvertebrati e delle diatomee sta testando metodi innovativi di analisi del DNA ambientale e di comunità - eDNA.
I risultati dell’analisi biologica effettuata su tutti gli impianti con metodo I.B.E. (comunità macroinvertebrati) e con metodo ICMi (comunità diatomee) sono riportati in Tabella 1. Mentre i risultati della metodica I.B.E. non hanno evidenziato particolari alterazioni della qualità dei corsi d’acqua in seguito all’attività delle troticolture, quelli ottenuti con la metodica ICMi sembrano rispondere di più all’impatto, anche se in modo contenuto. Quest’ultimo indice, inoltre, evidenzia sempre rispetto all’I.B.E. una qualità lievemente inferiore anche nelle stazioni a monte degli impianti.
La ricerca è finanziata sul Piano Nazionale degli investimenti Complementari al PNRR sui contratti di filiera nel settore della pesca e dell’acquacoltura del MASAF - CUP J38H23001450007.
L’allevamento di insetti per l’alimentazione zootecnica rappresenta un esempio di economia circolare in cui ogni parte del ciclo può diventare risorsa, contribuendo a costruire una filiera sostenibile e priva di scarti.

Il progetto WIN4FEED
The WIN4FEED project
The WIN4FEED project developed a local zero-waste chain that utilizes food waste from black soldier fly farming to create innovative feeds for trout and poultry. FEM conducted an analysis of larvae, adults, and exuviae, which are rich in chitin and possess prebiotic and immunostimulant properties. Feeding trials with trout using isoenergetic and isoproteic diets demonstrated comparable growth across treatments. Additionally, chitin enhanced the composition of gut microbiota, increased the number of mucus-secreting cells, and modulated immune responses, all without affecting performance. Nutrient-rich insect by-products can be repurposed as functional feed ingredients, thereby promoting a circular, sustainable, and wastefree aquafeed system that valorizes all aspects of insect production.
L’allevamento di insetti è considerato una delle soluzioni più promettenti per rendere più sostenibile la produzione di mangimi animali. Le larve di mosca soldato nera (Hermetia illucens) hanno un profilo nutrizionale interessante: proteine bilanciate, grassi ricchi in acido laurico e micronutrienti. Inoltre, l’allevamento degli insetti consente di valorizzare sottoprodotti
agroalimentari, trasformandoli in risorse, riducendo scarti ed emissioni e favorendo l’economia circolare.
Il progetto WIN4FEED (Waste and INsect for FEED), finanziato dal PSR 2014-2022, mirava a sviluppare una filiera locale senza rifiuti, utilizzando scarti alimentari a km zero per allevare la mosca soldato, con cui poi produrre mangimi innovativi per polli e
* Centro Ricerca e Innovazione, Fondazione Edmund Mach
Figura 1
Flusso dei prodotti e sottoprodotti all’interno della filiera sperimentale
trote. Per minimizzare la produzione di prodotti di scarto oltre alle farine dalle larve, sono stati valorizzati anche i sottoprodotti dell’insetticoltura – esuvie e adulti – ricchi di chitina, un polisaccaride con proprietà prebiotiche e immunostimolanti. Infine, il letto di crescita degli insetti è stato riutilizzato come ammendante per l’agricoltura, rappresentando così un modello di produzione “zero rifiuti” (Figura 1).
I partner del progetto, tutti trentini, erano la start up Baolfly, la Fondazione Edmund Mach e l’azienda Uova di montagna. FEM, come referente scientifico, ha avuto un ruolo centrale nelle attività, analizzando il valore nutrizionale di larve, adulti ed esuvie, e studiando gli effetti della chitina su crescita, microbiota, salute intestinale e risposta immunitaria della trota iridea (Oncorhynchus mykiss). Innanzitutto, è stato determinato il valore nutrizionale delle larve di mosca soldato, fresche e sottoposte a tre diversi processi di lavorazione: essiccazione a caldo, liofilizzazione e shock termico con successiva essiccazione. La liofilizzazione è risultata la tecnica migliore, con solo il 5% di umidità residua (contro il 2433% dell’essiccazione), conservando nutrienti e colore, e rendendo il prodotto stabile a lungo termine. Per quanto riguarda i macronutrienti, gli adulti hanno una quota proteica superiore alle larve (60% vs 38%), ma meno grassi (18% vs 40%). Tra gli acidi grassi predominano i saturi, soprattutto aci-



do laurico, palmitico e miristico; presenti anche acidi grassi monoinsaturi (oleico) e polinsaturi (linoleico). Per quanto riguarda gli aminoacidi, i profili sono equilibrati e simili tra larve e adulti. Le larve spiccano per fenilalanina e tirosina, aminoacidi che nei pesci aiutano a ridurre lo stress e migliorano la crescita. Gli adulti hanno invece più arginina, importante per la sintesi proteica e la resistenza alle malattie. Infine, la chitina: molto più abbondante negli adulti (circa il 6%) rispetto alle larve (3-4%) e soprattutto nelle esuvie (oltre il 13%). Queste analisi indicano che sia larve che adulti hanno un buon potenziale come ingredienti per mangimi. La chitina, più abbondante negli adulti e nelle esuvie, deve però essere gestita con attenzione perché può influenzare la digeribilità dei mangimi. Per testare il valore dei sottoprodotti ricchi di chitina, FEM ha condotto una prova di undici settimane confrontando quattro diete formulate per essere isoenergetiche e isoproteiche:
• C- (controllo negativo): dieta standard senza chitina;
• C+ (controllo positivo): dieta con farina di insetti commerciale (0,25% di chitina);
• E: dieta con esuvie (0,13% di chitina);
• A: dieta con insetti adulti (0,05% di chitina).
Ogni dieta è stata somministrata a tre vasche-repliche con 50 pesci ciascuna. Tutti i gruppi sperimentali hanno mostrato buoni tassi di crescita, passando da un peso medio iniziale





di 102 g a circa 282 g finali, senza differenze significative tra le diete. Gli indici di performance zootecnica SGR (tasso specifico di crescita) e FCR (fattore di conversione alimentare) sono anch’essi risultati simili. Anche il fattore di condizione è rimasto compreso tra 1 e 1,3, indice di buono stato di salute degli animali. Questi dati confermano che la chitina, alle concentrazioni da noi testate, non penalizza la crescita della trota.
La ricchezza microbiotica intestinale non cambia tra diete, mentre cambia la composizione. La dieta A, contenente chitina, ha aumentato la presenza di Bacteroidota e di generi produttori di acidi grassi a catena corta (SCFA), benefici per metabolismo e immunità dei pesci. Anche alcuni generi immunomodulanti (Parabacteroides, Alloprevotella) erano più abbondanti nei gruppi alimentati con chitina. Questo conferma che la presenza della chitina nelle diete può favorire una comunità microbica più equilibrata, con potenziali benefici sulla salute e l’assorbimento dei nutrienti.
Dalle analisi istologiche su intestino e fegato emerge che nessuna dieta ha causato danni o infiammazioni. In aggiunta, nei gruppi E e A, si è osservata a livello intestinale una maggiore presenza di cellule caliciformi, che producono muco a protezione dei villi. Nei gruppi A e C+ si riscontrano più vacuoli sopra-nucleari, indice di un maggiore assorbimento dei nutrienti. A livello epatico, nelle diete contenenti insetti (C+ e A) si è notato un accumulo lipidico leggermente superiore, dovuto principalmente ad una maggiore presenza di acidi gras-
si saturi e monoinsaturi, senza per questo pregiudicare la salute degli animali. Questi risultati suggeriscono che la chitina stimola la produzione di muco, evitando infiammazione e migliorando l’assorbimento di nutrienti. Le analisi molecolari si sono focalizzate sulla risposta immunitaria. La dieta C+ (con farina di insetti commerciale) ha aumentato l’espressione dei geni pro-infiammatori, confermando l’effetto immunostimolante, mentre le diete E e A hanno avuto un impatto più modesto, probabilmente determinato da un dosaggio più basso di chitina. Questo ci porta a confermare che la chitina sia uno stimolante naturale del sistema immunitario dei pesci, ma l’effetto è correlato alla sua concentrazione.
Concludendo, Il progetto WIN4FEED ha dimostrato che:
• le larve di mosca soldato sono una fonte proteica valida per sostituire parte della farina di pesce, o altre fonti proteiche nella dieta della trota;
• i sottoprodotti dell’insetticoltura (esuvie e adulti) possono essere riutilizzati come additivi funzionali nei mangimi grazie al loro contenuto in chitina;
• la chitina in dosi contenute non compromette crescita e benessere delle trote, anzi modula positivamente il microbiota, stimola la protezione intestinale e rafforza la risposta immunitaria.
Un sistema produttivo in cui niente va sprecato è quindi possibile: ogni parte del ciclo di allevamento degli insetti può diventare risorsa, contribuendo a costruire una filiera di mangimi sostenibile, circolare e senza scarti.
Lo studio della biodiversità delle diatomee, fondamentale per comprendere i meccanismi di alterazione degli ecosistemi, ha permesso di evidenziare l’elevato valore ecologico di ambienti estremi e poco studiati come i laghi d’alta quota.

Biodiversità delle diatomee in un lago d’alta quota
FRANCESCA CIUTTI
CRISTINA CAPPELLETTI
Foto 1
Diatomea al microscopio elettronico a scansione
I laghi d’alta quota sono caratterizzati da condizioni ambientali estreme (copertura di ghiaccio per gran parte dell’anno, basse concentrazioni di nutrienti, elevata radiazione solare, basse temperature) e ospitano comunità diatomiche altamente specifiche, ricche di taxa endemici, minacciati e in gran parte ancora non descritti. Sia gli impatti antropici diretti (ad esempio eutrofizzazione, introduzione di specie ittiche), sia quelli indiretti (quali cambiamenti climatici, acidificazione, microplastiche) possono compromettere questi ecosistemi ancora in gran parte incontaminati.
La ricerca sulla biodiversità è fondamentale per comprendere i meccanismi di alterazione degli ecosistemi. Lo studio è stato effettuato in collaborazione con il Dipartimento di
Scienze della Vita dell’Università di Trieste, l’Istituto Zooprofilattico Sperimentale del Piemonte e l’Università di Leon (Spagna) sul Lago Balma Soprano, un piccolo lago d’alta quota sito in Piemonte (quota: 2.214 m s.l.m.; superficie: 1,82 ha; profondità massima: 2,77 m; perimetro: 774 m). Il lago è compreso nella Zona Speciale di Conservazione (ZSC) e Zona di Protezione Speciale (ZPS) IT1110006, denominata “Orsiera Rocciavrè” all’interno del Parco Naturale Orsiera Rocciavrè.
L’analisi al microscopio dei campioni di diatomee epilitiche, raccolti in 7 stazioni del lago in due stagioni, ha permesso di osservare un’elevata diversità tassonomica, con un totale di 116 taxa, appartenenti a 9 ordini, 24 famiglie e 37 generi. La determina-



























zione fino al livello di specie è stata possibile per 89 taxa: come già osservato da altri autori, la presenza di specie poco conosciute o non ancora descritte è frequente in questa tipologia di ambienti.
Le misure morfometriche, l’inclusione delle specie in liste di protezione (Lista Rossa) e l’iconografia della maggior parte dei taxa sono stati pubblicati, fornendo un contributo alla conoscenza di questa componente biologica nei laghi alpini (Ciutti et al. 2025 Phytotaxa 710:1-21).
Fra le specie osservate (Figura 1), 71 sono incluse della Lista Rossa delle diatomee (Figura 2). In particolare, 5 sono considerate altamente minacciate (es: Brachysira calcicola Lange-Bertalot, 1994 e Neidium alpi-















num Hustedt, 1943), 10 minacciate di estinzione (es: Cavinula pseudoscutiformis (Hustedt) D.G. Mann & Stickle, 1990 ed Encyonema perpusillum (A. Cleve) D.G. Mann, 1990) e 9 in allerta precoce (es. Eunotia paludosa Grunow, 1862 e Gomphonema hebridense Gregory, 1854).
Dal punto di vista dell’autoecologia, la maggior parte delle specie è tipica di ambienti oligotrofici-distrofici, poveri in elettroliti e con pH leggermente acido o vicino alla neutralità. Lo studio ha conferma l’importante valenza ecologica di questi ambienti, tuttora poco conosciuti ed è proseguito con il confronto dei risultati ottenuti con analisi del DNA metabarcoding (primer rbcL), effettuata sugli stessi campioni.
Figura 1
Esempi di diverse specie di diatomee campionate nel lago Balma Soprano
Figura 2
Lago Balma Soprano: Lista Rossa delle diatomee
Altamente minacciata
Minacciata di estinzione
Allerta precoce
Non minacciata
Rischio non stimato
Dati insufficienti
L’ATTIVITÀ IN SINTESI
PIATTAFORMA SERVIZI: MESSAGGISTICA TECNICA
Figura 1
Andamento del numero di iscritti alla piattaforma servizi dal suo avvio (febbraio 2014) al 31 dicembre 2024
Figura 2
Totale degli avvisi tecnici inviati via mail per le varie colture nel 2024: 930
Figura 3
Totale mail inviate nel 2024: 622.607
Numero avvisi via mail
Numero avvisi via sms
Figura 4
Totale degli avvisi inviati via sms per le varie colture nel nel 2024: 385
Figura 5
Totale sms inviati nel 2024: 170.291
Il numero degli avvisi per coltura è la somma degli avvisi prodotti dai tecnici FEM-CTT dalle varie sedi periferiche dislocate sul territorio o degli avvisi inviati per settori territoriali omogenei.
La ricezione della messaggistica tecnica è legata all’adesione/iscrizione ai servizi di consulenza a fronte di una compartecipazione ai costi per le colture: melo, vite, ciliegio e piccoli frutti, actinidia, susino, albicocco e produzioni zootecniche. Per la messaggistica sulle colture olivo, noce e apicoltura è mantenuto l’accesso libero e gratuito.
SISTEMA ALLERTAMENTO GELATE
ALLERTA VIA SMS
Stazioni meteo con sistema antibrina coinvolte 46 di cui 10 sperimentali su ciliegio
Stazioni sperimentali con sistema di trasmissione LoRaWAN 14
Totale SMS di allerta gelate inviati nel periodo 15/3 - 10/5
Numero di allarmi inviati per stazione
SITO FITOEMERGENZE
Sito dedicato alle emergenze fitosanitarie (colpo di fuoco batterico, flavescenza dorata, scopazzi del melo e lepidottero delle palme) https://fitoemergenze.fmach.it/
SITO DEL CENTRO TRASFERIMENTO TECNOLOGICO
https://ctt.fmach.it/
I DATI DEI SERVIZI E DELLE ATTIVITÀ
DIAGNOSTICA FITOPATOLOGICA
Resp. Valeria Gualandri - valeria.gualandri@fmach.it - fito.diagnostica@fmach.it
Virus, funghi, batteri, fitoplasmi, nematodi, insetti (per programma interno, per clienti esterni e programma PAT) 4.647
DIAGNOSI FORESTE E VERDE URBANO
Resp. Mario Baldessari - mario.baldessari@fmach.it
Valutazioni fitosanitarie e di stabilità di piante arboree 53
ANALISI CHIMICHE/MICROBIOLOGICHE
Su un totale di circa 27.000 campioni di varie merceologie
Resp. Roberto Larcher - roberto.larcher@fmach.it - segreteria.laboratorio@fmach.it
Tracciabilità dell'origine con isotopi e microelementi
Analisi di controllo viti-enologiche
Consulenza enologica a piccole aziende private-analisi e refertazione
Analisi di controllo su alimenti
Profili aromatici in vino e distillati
Analisi di residui di fitofarmaci negli alimenti
Analisi di suoli e vegetali
Indagini microbiologiche sugli alimenti
CENTRO DI SAGGIO
Resp. Gastone Dallago - gastone.dallago@fmach.it - centrodisaggio.ctt@fmach.it
Sperimentazioni fitopatologiche su melo, vite, piccoli frutti, ciliegio, olivo, altre specie vegetali agrarie
Verifica attività prodotti fertilizzanti
Sperimentazioni di prodotti fertilizzanti, biostimolanti ed ammendanti su vite e fruttiferi
Analisi di struttura (Texture Analyzer), numero determinazioni per:
• Consistenza della bacca
• Durezza della buccia e/o della polpa • Spessore della buccia
SELEZIONE CLONALE-SANITARIA DELLA VITE
Resp. Alberto Gelmetti - alberto.gelmetti@fmach.itt
Mantenimento e selezione di biotipi/cloni ufficiali
Saggi di inoculo in campo (indexaggi vite)
520 biotipi / 108 cloni registrati 200 combinazioni
MICROVINIFICAZIONI
Resp. Tomas Roman - tomas.roman@fmach.it
Processi di microvinificazione completi o parziali per sperimentazione e servizi 623
ISPEZIONE AI CENTRI DI CONTROLLO FUNZIONALE DELLE IRRORATRICI
Resp. Mario Baldessari - mario.baldessari@fmach.it
Ispezioni sull’attività dei Centri già autorizzati dalla PAT Ispezioni sull’attività dei Centri fuori provincia 7 1
IDENTIFICAZIONE ACARI FITOSEIDI
Resp. Daniele Prodorutti - daniele.prodorutti@fmach.it
Identificazione acari fitoseidi su foglie di vite 64
ANALISI PRE- POST-RACCOLTA
Resp. Dario Angeli - dario.angeli@fmach.it
Analisi fisico chimiche per test di maturazione
Analisi fisico chimiche e controllo qualità su frutta in conservazione (celle) 1.300 1.300 900
Test dell’amido
AGROMETEOROLOGIA
Resp. Stefano Corradini - stefano.corradini@fmach.it - meteo@fmach.it
Raccolta, archiviazione e pubblicazione su web dei dati di 95 stazioni agro-meteorologiche raccolti in tempo reale con cadenza 15 min
Totale pagine visitate (dal 01-01-2024 al 31-12-2024)
Media giornaliera
Media mensile 442.116 1.211 36.843
I DATI DEI SERVIZI E DELLE ATTIVITÀ
MODELLI PREVISIONALI
Resp. Stefano Corradini - stefano.corradini@fmach.it - meteo@fmach.it
Stazioni meteo coinvolte
RIMpro (melo/ticchiolatura)
Totale accessi
Accessi medi per stazione Giorno con più accessi (10 aprile)
Stazioni più visitate
RIMpro (vite/peronospora)
Totale accessi
Accessi medi per stazione Giorno con più accessi (22 aprile)
Stazioni più visitate 44
23.188 527 933
Cles, S. Michele a/A, Aldeno, Romagnano
9.951 321 312
S. Michele a/A, Arco, Lavis, Roverè della Luna
FRUTTETI SPERIMENTALI
Resp. Franco Micheli - franco.micheli@fmach.it
Maso delle Part (Mezzolombardo) Parcelle sperimentali
Superficie (ha) Varietà Portinnesti
Azienda sperimentale Denno Parcelle sperimentali
Superficie (ha)
Varietà Portinnesti
ANALISI QUALITÀ BIOLOGICA DEI CORSI D’ACQUA
Resp. Filippo Faccenda - filippo.faccenda@fmach.it - centroittico.ctt@fmach.it
Diatomee (Indice ICMi)
Rapporti tecnici 170 32
ACQUACOLTURA
Resp. Filippo Faccenda - filippo.faccenda@fmach.it - centroittico.ctt@fmach.it
Consulenza ad aziende itticole, associazioni ed enti
Analisi di texture su filetti di trota (TPA) 3 48
CONSULENZA ZOOTECNICA
Resp. Gabriele Iussig - gabriele.iussig@fmach.it
Consulenza aziendale qualità latte, piano mastite, alpicoltura/maiscoltura/ praticoltura, alimentazione animale, economia e bilancio aziendale, costruzioni zootecniche, gestione reflui, ovicaprini
Piano mastite bovini
Aziende coinvolte
Campioni di latte per analisi microbiologica
Consulenza specialistica per piccoli ruminanti
Aziende coinvolte
Diagnosi ecografica di gravidanza
Interventi di fecondazione artificiale
Campioni di latte per analisi microbiologica
Redazione dei Piani di Utilizzazione Agronomica degli effluenti
CONSULENZA ENOLOGICA PICCOLE E MEDIE AZIENDE
Resp. Tomas Roman - tomas.roman@fmach.it
Pacchetto consulenza enologiche piccole e medie aziende trentine
Valutazioni sensoriali e/o analitiche
1.552 contatti in 368 aziende, di cui 630 per il Piano mastite e 427 per la Qualità latte
155 aziende, 12 malghe 9.742 17 542 55 174 1
93 3.682
LE AZIENDE CLIENTI 2024
Nel 2024 il CTT ha fornito prestazioni professionali e strumentali per 1.087 aziende (enti pubblici, e imprese private) in Italia e all’estero.
6
Distribuzione della provenienza delle aziende clienti in Italia e all’estero (totale 1.087)

7
Distribuzione della provenienza delle aziende clienti in

RICONOSCIMENTI
Struttura
Laboratorio chimico e microbiologico (Unità Chimica vitienologica e agroalimentare, Unità Trasformazione enologica e alimentare, Unità Frigoconservazione e certificazioni agroalimentari)
Laboratorio diagnosi fitopatologica (Unità Diagnostica fitopatologica)
Laboratorio chimico e microbiologico (Unità Chimica vitienologica e agroalimentare e Unità Trasformazione enologica e alimentare)
Laboratorio chimico (Unità Chimica vitienologica e agroalimentare)
Laboratorio chimico e microbiologico (Unità Chimica vitienologica e agroalimentare e Unità Trasformazione enologica e alimentare)
Laboratorio chimico e microbiologico (Unità Chimica vitienologica e agroalimentare e Unità Trasformazione enologica e alimentare)
Centro di Saggio (Unità Centro di Saggio)
Laboratorio diagnosi fitopatologica (Unità Diagnostica fitopatologica)
Laboratorio diagnosi fitopatologica (Unità Diagnostica fitopatologica)
Laboratorio diagnosi fitopatologica (Unità Diagnostica fitopatologica)
Centro ittico (Unità acquacoltura e idrobiologia)
Tipologia
Accreditamento ACCREDIA (Ente Italiano di Accreditamento) numero 0193, attualmente per 71 prove, corrispondenti a circa 300 parametri analitici
Autorizzazione Ministero delle politiche agricole alimentari e forestali al rilascio dei certificati di analisi nel settore vitivinicolo
Designazione dei Laboratori di prova per analisi di controllo in agricoltura biologica
Inserimento nell’albo del MiUR (Ministero dell’Istruzione, dell’Università e della Ricerca) dei laboratori esterni pubblici e privati altamente qualificati per attività di “Ricerca e sviluppo sperimentale nel campo della chimica, della biologia, delle scienze naturali e dell’ingegneria”
Iscrizione negli elenchi provinciali dei “Laboratori di analisi non annessi alle industrie alimentari ai fini dell’autocontrollo”
Riconoscimento del Ministero per le Politiche Agricole Alimentari e Forestali di conformità alle buone pratiche di campo
Laboratorio pubblico autorizzato dal Mipaaf per le finalità di cui al DM 02 luglio 1991, N 290
Riconoscimento per l’esecuzione delle diagnosi ufficiali degli organismi nocivi contemplati dalle normative di competenza dell’Ufficio fitosanitario provinciale
Riconoscimento come Laboratorio ufficiale che opera in nome e per conto delle autorità competenti regionali e nazionali
Autorizzazione alla sperimentazione animale di cui al D. Lgs 116/92
Riferimento
Norma UNI CEI EN ISO/IEC 17025
DM 2592 del 12 marzo 2014
DM 30 dicembre 2008
DPP 23 febbraio 2005, n. 1-31/Leg art. 1
DM 6 giugno 2000, Prot. n. 33038
DM 10 ottobre 1996 DM 13 dicembre 2011
Delibera GP n. 696 del 9 maggio 2014
Regolamento UE 2017/625
DM 120/2008-A del 3 settembre 2008
PUBBLICAZIONI 2024
//openpub.fmach.it/
Articoli pubblicati su riviste scientifiche con fattore d’impatto
Baldi P., Buti M., Gualandri V., Khomenko I., Farneti B., Biasioli F., Paffetti D., Malnoy M. (2024).
Transcriptomic and volatilomic profiles reveal Neofabraea vagabunda infection-induced changes in susceptible and resistant apples during storage. Postharvest Biology and Technology, 212: 112889.
Battiston R., Fontana P. (2024).
Orthoptera in the far side of the world: the southernmost new genus of Phaneropterinae, and the ecology of some Subantarctic Orthoptera. Bulletin of Insectology, 77(1): 101-108.
Bolchini S., Larcher R., Morozova K., Scampicchio M., Nardin T. (2024).
Screening of antioxidant Maillard reaction products using HPLC-HRMS and study of reaction conditions for their production as food preservatives. Molecules, 29(20): 4820.
Bonini A., Tamaño G., Fariña L., Boido E., Dellacassa E., Pianezze S., Perini M. (2024).
Improving honey identification: stable isotope ratios variability of mono and polyfloral honeys from the citrus growing area of Salto/Concordia and from Uruguayan coastal areas. Journal of Food Composition and Analysis, 129: 106132.
Calderan A., Falchi R., Braidotti R., Tonidandel L., Larcher R., Sivilotti P. (2024).
Using in vitro cultured berries to unravel the effects of heat- and ABA-induced stress on thiol precursor biosynthesis in Sauvignon blanc. Journal of Agricultural and Food Chemistry, 72(26): 14547-14556.
Cappellari A., Malagnini V., Fontana P., Zanotelli L., Tonidandel L., Angeli G., Ioriatti C., Marini L. (2024).
Impact of landscape composition on honey bee pollen contamination by pesticides: a multi-residue analysis. Chemosphere, 349: 140829.
Cardin M., Mounier J., Coton E., Cardazzo B., Perini M., Bertoldi D., Pianezze S., Segato S., Di Camillo B., Cappellato M., Coton M., Carraro L., Currò S., Lucchini R., Mohammadpour H., Novelli E. (2024). Discriminative power of DNA-based, volatilome, near infrared spectroscopy, elements and stable isotopes methods for the origin authentication of typical Italian mountain cheese using sPLS-DA modeling. Food Research International, 178: 113975.
Carullo G., Borghini F., Fusi F., Saponara S., Fontana A., Pozzetti L., Fedeli R., Panti A., Gorelli B., Aquino G., Basilicata M.G., Pepe G., Campiglia P., Biagiotti S., Gemma S., Butini S., Pianezze S., Loppi S., Cavaglioni A., Perini M., Campiani G. (2024).
Traceability and authentication in agri-food production: a multivariate approach to the characterization of the Italian food excellence elephant garlic (Allium ampeloprasum L.), a vasoactive nutraceutical. Food Chemistry, 444: 138684.
Castaldi S., Formicola N., Mastrocicco M., Rodriguez Morales C., Morelli R., Prodorutti D., Vannini A., Zanzotti R. (2024).
A multi-indicator approach to compare the sustainability of organic vs. integrated management of grape production. Ecological Indicators, 158: 111297.
Checola G., Sonego P., Zorer R., Mazzoni V., Ghidoni F., Gelmetti A., Franceschi P. (2024).
A novel dataset and deep learning object detection benchmark for grapevine pest surveillance. Frontiers in Plant Science, 15: 1485216.
Craparo V., Viola E., Vella A., Prestianni R., Pirrone A., Naselli V., Amato F., Oliva D., Notarbartolo G., Guzzon R., Settanni L., Moschetti G., Francesca N., Alfonzo A. (2024).
Oenological capabilities of yeasts isolated from high-sugar matrices (manna and honey) as potential starters and co-starters for winemaking. Beverages, 10(3): 48.
Cristofolini F., Cristofori A., Corradini S., Gottardini E. (2024).
The impact of temperature on increased airborne pollen and earlier onset of the pollen season in Trentino, Northern Italy. Regional Environmental Change, 24: 60.
Cucinotta L., Cannizzaro F., Paolini M., Roncone A., Camin F., Bontempo L., Larcher R., Sciarrone D., Mondello L. (2024).
From grape to wine: a thorough compound specific isotopic, enantiomeric and quali-quantitative investigation by means of gas chromatographic analysis. Journal of Chromatography A, 465149: 465149.
De Rosso M., Gardiman M., Carraro R., Panighel A., Fagherazzi F., Sansone L., Roman Villegas T., Vettori L., Flamini R. (2024).
Monoglucoside versus diglucoside anthocyanin evolution of red wine produced using a fungus-resistant grape cultivar (downy mildew and powdery mildew) under oxidative conditions. Journal of Agricultural and Food Chemistry, 72(13): 7383-7396.
Dekker S., Nardin T., Roman Villegas T., Larcher R. (2024).
Analysis of polysulfides in aged sparkling wines from different vintages. Journal of Food Biochemistry, 2024(1): 3795283.
Dekker S., Nardin T., Roman Villegas T., Tessadri M., Larcher R. (2024).
Evidence of the relationship between the Oxygen Radical Absorbance Capacity (ORAC) and the potential exposure of white wines to Atypical Aging (ATA). Journal of Agricultural and Food Chemistry, 72(16): 9330-9336.
Delaiti S., Nardin T., Pedò S., Larcher R., Gallo A., Cappello N., Roman T. (2024).
Impact of using yeast derivatives on the development of atypical aging in wines. Oeno One, 58(2): 1-13.
Delaiti S., Nardin T., Roman Villegas T., Cappello N., Larcher R., Pedò S. (2024).
Exploring the relationship between field available water capacity (AWC) and atypical aging (ATA) development in base wines. Journal of Food Science, 89(12): 9515-9528.
Delaiti S., Nardin T., Roman T., Pedò S., Larcher R. (2024).
Evaluating the atypical aging potential development in sparkling wines can be achieved by assessing the base wines at the end of the alcoholic fermentation. Journal of Agricultural and Food Chemistry, 72(9): 4918-4927.
Fellin L., Dal Zotto G., Lisi F., Chiesa S.G., Saddi A., Fusillo M., Anfora G., Biondi A., Mori N., Rossi Stacconi M.V. (2024).
Assessment of non-target toxicity of insecticides on Ganaspis brasiliensis (Ihering) in laboratory and field conditions. Pest Management Science, 80(10): 5421-5431.
Fernández-Fernández A.M., Dellacassa E., Curbelo R., Nardin T., Larcher R., Medrano-Fernandez A., del Castillo M.D. (2024).
Health-promoting potential of mandarin pomace extracts enriched with phenolic compounds. Nutrients, 16(14): 2370.
Fontana P. (2024).
A new species of the genus Embia Latreille, 1825 (Insecta, Embioptera) from the Madonie Regional Natural Park (Sicily, Italy). Zootaxa, 5418(3): 255-267.
Fontana P., Forbicioni L. (2024).
The unexpected complexity of the Embioptera (Insecta) fauna of the Tuscan Archipelago (Italy), with the disambiguation of two species of Haploembia Verhoeff, 1904 and the description of a new species of Embia Latreille, 1825. Zootaxa, 5507(4): 549-564.
Fontana P., Odé B., Willemse L., Massa B. (2024).
In favor of the principle of nomenclatural stability: the case of the Gomphocerini (Orthoptera: Acrididae). Zootaxa, 5406(3): 495-496.
Francesca N., Naselli V., Prestianni R., Pirrone A., Viola E., Guzzon R., Settanni L., Maggio A., Vaglica A., Bruno M., Gristina L., Oliva D., Ferranti G., Notarbartolo G., Alfonzo A., Moschetti G. (2024). Impact of two new non-conventional yeasts, Candida oleophila and Starmerella lactis-condensi, isolated from sugar-rich substrates, on Frappato wine aroma. Food Bioscience, 57: 103500.
Gallo A., Roman T., Paolini M., Cappello N., Castello D., Schiavon S., Guzzon R., Carrau F., Schneider R., Larcher R. (2024).
The co-inoculation ratio of Hanseniaspora vineae-to-Saccharomyces cerevisiae correlates with aroma metabolic features in wine. European Food Research and Technology, 250: 2907-2919.
Gallo A., Roman T., Paolini M., Cappello N., Guzzon R., Carrau F., Schneider R., Larcher R. (2024). Aroma features of Hanseniaspora vineae Hv205 wines in sequential and co-inoculation strategies. Fermentation, 10(4): 191.
Gallo A., Roman T., Paolini M., Tonidandel L., Leonardelli A., Celotti E., Nardin T., Natolino A., Cappello N., Larcher R. (2024).
Influence of flash heating and aspergillopepsin I supplementation on must and wine attributes of aromatic varieties. Food Research International, 186: 114332.
Geppert C., Da Cruz M., Alma A. Andretta L., Anfora G. Battaglia D., Burgio G., Caccavo V., Chiesa S.G., Cinquatti F., Cocco A., Costi E., D’Isita I., Duso C., Garonna A. P., Germinara G.S., Lo Bue P., Lucchi A., Maistrello L., Mannu R., Marchesini E., Masetti A., Mazzon L., Mori N., Ortis G, Peri E., Pescara G., Prazaru S.C., Ragone G., Rigamonti I.E., Rosi M.C., Rotundo G., Sacchetti P., Savoldelli S., Suma P., Tamburini G., Tropea Garzia G., Marini L. (2024).
Climate and landscape composition explain agronomic practices, pesticide use and grape yield in vineyards across Italy. Agricultural Systems, 215: 103853.
Gholampour Z., Zakiaghl M., Asquini E., Moser M., Gualandri V., Mehrvar M., Si Ammour A. (2024). Application of high-throughput sequencing for comprehensive virome profiling in grapevines shows yellows in Iran. Viruses, 16(2): 204.
Giannioti Z., Suman M., Roncone A., Rollo E., Tonidandel L., Barbero A., Catellani D., Larcher R., Bontempo L. (2024).
Isotopic, mycotoxin, and pesticide analysis for organic authentication along the production chain of wheat-derived products. Food Chemistry, 452: 139519.
Guariento E., Obwegs L., Anderle M., Bell A., Fontana P., Paniccia C., Plunger J., Rüdisser J., Stifter S., Giombini V., Egarter Vigl L., Tappeiner U., Hilpold A. (2024).
Meadow orchards as a good practice example for improving biodiversity in intensive apple orchards. Biological Conservation, 299: 110815.
Gupta S., Makridis P., Henry I., Velle-George M., Ribicic D., Bhatnagar A., Skalska-Tuomi K., Daneshvar E., Ciani E., Persson D., Netzer R. (2024).
Recent developments in recirculating aquaculture systems: a review. Aquaculture Research, 2024(1): 6096671.
Guzzon R., Paolini M., Malacarne M., Roman T., Naselli V., Francesca N., Larcher R. (2024).
Use of non-Saccharomyces yeasts in the pris de mousse of Lambrusco: microbial evolution through alcoholic fermentation and effect on wine volatile profile. Oeno One, 58(3): 7884.
Hannon K.M., Sabala J.D., Mantha M., Lorenz L.M., Roetting J.P. II, Perini M., Pianezze S., Kubachka K.M. (2024).
Using stable carbon isotope ratio analysis to detect adulteration in red yeast rice dietary supplements. Talanta, 266(Pt 2): 125076.
Li M., Boisson-Dernier A., Bertoldi D., Ardini F., Larcher R., Grotti M., Varotto C. (2024). Elucidation of arsenic detoxification mechanism in Marchantia polymorpha: the role of ACR3. Journal of Hazardous Materials, 470: 134088.
Marzocchi G., Maresi G., Luchi N., Pecori F., Gionni A., Longa C., Pezzi G., Ferretti F. (2024). 85 years counteracting an invasion: chestnut ecosystems and landscapes survival against ink disease. Biological Invasions, 26(7): 2049-2062.
Mattedi C., Rodeghiero M., Zorer R. (2024).
IoT technology as a support tool for the calculation of Crop Water Stress Index in a Vitis vinifera L. cv. Chardonnay vineyard in Northern Italy. Italian Journal of Agrometeorology (2): 65-80.
Morpurgo M., Marrone F., Ciutti F., Cappelletti C., Vorhauser S., Alber R., Dossena M., Salmaso N., Fontaneto D., Caputo L., Vecchioni L. (2024).
Distribution and genetic lineages of the Craspedacusta sowerbii species complex (Cnidaria, Olindiidae) in Italy. Biology, 13(4): 202.
Naselli V., Pirrone A., Viola E., Craparo V., Porrello A., Maggio A., Seminerio V., Rocca G., Notarbartolo G., Krieger-Weber S., Vagnoli P., Weidmann S., Guzzon R., Settanni L., Moschetti G., Francesca N., Alfonzo A. (2024).
Technological affinity index for interaction between lactic acid bacteria and Saccharomyces cerevisiae strains to modulate the fruity and floreal aroma of Catarratto wines. Food Chemistry, 460(3): 140647.
Obertegger U., Corradini S., Cerasino L., Weiss L.C. (2024).
Decadal changes in surface CO2 concentrations and CO2 fluxes in a mountain lake. Limnology and Oceanography, 69(5): 1143-1156.
Paolini M., Roncone A., Cucinotta L., Sciarrone D., Mondello L., Camin F., Moser S., Larcher R., Bontempo L. (2024).
Aromatic characterisation of Moscato Giallo by GC-MS/MS and validation of stable isotopic ratio analysis of the major volatile compounds. Biomolecules, 14(6): 710.
Perenzoni D., Dellafiora L., Perugino F., Vrhovsek U., Piombino P., Pittari E., Guzzon R., Moio L., Galaverna G., Mattivi F. (2024).
Exploring putative kokumi oligopeptides in classic sparkling wines with a UHPLC-ESI-MS/MS targeted protocol. Journal of Agricultural and Food Chemistry, 72(47): 26189-26208.
Perini M., Pianezze S., Bontempo L. (2024).
Stable Isotope Ratio Mass Spectrometry and Site-Specific Natural Isotope Fractionation-Nuclear Magnetic Resonance applications to discriminate between synthetic and natural analogs: a review. TrAC Trends in Analytical Chemistry, 180: 117966.
Perini M., Pianezze S., Paolini M., Larcher R. (2024).
High-density balsamic vinegar: application of stable isotope ratio analysis to determine watering down. Journal of Agricultural and Food Chemistry, 72(4): 1845-1848.
Pianezze S., Paolini M., D’Archivio A.A., Perini M. (2024).
Gas chromatography-stable isotope ratio mass spectrometry prior solid phase microextraction and gas chromatography-tandem mass spectrometry: development and optimization of analytical methods to analyse garlic (Allium sativum L.) volatile fraction. Heliyon, 10(9): e30248.
Pilkington L.I., Kerner W., Bertoldi D., Larcher R., Lee S.A., Goddard M.R., Albanese D., Franceschi P., Fedrizzi B. (2024).
Integration and holistic analysis of multiple multidimensional soil data sets. Talanta, 274: 125954.
Prodorutti D., Bugiani R., Philion V., Stensvand A., Coller E., Tosi C., Rizzi C., Angeli G., Pertot I. (2024). Irrigation targeted to provoke ejection of ascospores of Venturia inaequalis shortens the season for ascospore release and results in less apple scab. Plant Disease, 108(5): 1353-1362.
Prodorutti D., Gualandri V., Philion V., Stensvand A., Coller E., Pertot I. (2024). Pseudothecium development and ascospore discharge in Venturia asperata and V. inaequalis: relation to environmental triggers. Phytopathologia Mediterranea, 63(3): 431-442.
Rossi L., Zoli M., Capoccioni F., Pulcini D., Martini A., Bacenetti J. (2024).
Insights into different marine aquaculture infrastructures from a life cycle perspective. Aquacultural Engineering, 107: 102462.
Saraiva J.L., Faccenda F., Cabrera-Álvarez M.J., Povinelli M., Hubbard P.C., Cerqueira M., Farinha A.P., Secci G., Tignani M.V., Pulido Rodriguez L.F., Parisi G. (2024).
Welfare of rainbow trout at slaughter: Integrating behavioural, physiological, proteomic and quality indicators and testing a novel fast-chill stunning method. Aquaculture, 581: 740443.
Shahzad G., Kabir A., Maresi G., Baric D. (2024).
Deciphering the impact of temperature on the conversion capacity and the mycoviral load of conidia of hypovirulent isolates of Cryphonectria parasitica Journal of Plant Pathology, 106(4): 1521.
Schlösser R., Santini A., Pepori A.L., Baschieri T., Campani C., Ferrari D., Maresi G., Rizzo D., Stazione L., Biscioni G., Ghelardini L. (2024).
Cryptostroma corticale in Italy: new reports of sooty bark of Acer pseudoplatanus and first outbreak on Acer campestre Phytopathologia Mediterranea, 63(3): 399-406.
Somenzi E., Partel E., Barbato M., Chero Osorio A.M., Colli L., Franceschi N., Mantovani R., Pilla F., Komjanc M., Achilli A., Hauffe H.C., Ajmone Marsan P. (2024).
Genetic legacy and adaptive signatures: investigating the history, diversity, and selection signatures in Rendena cattle resilient to eighteenth century rinderpest epidemics. Genetics Selection Evolution, 56: 32.
Vicelli B., Puopolo G., Angeli G., Gualandri V. (2024).
First report of strawberry bacterial blight caused by Pantoea ananatis in Italy. Journal of Plant Pathology, 106: 755-756.
Zapponi L., Chiesa S.G., Anfora G., Chini L., Gallimbeni L., Ioriatti C., Mazzoni V., Saddi A., Angeli G. (2024).
Combined effect of timing, position and management on Halyomorpha halys feeding injury assessment on apple cultivars. Journal of Applied Entomology, 148(9): 1027-1036.
Zoli M., Rossi L., Fronte B., Aubin J., Jaeger C., Wilfart A., Bibbiani C., Bacenetti J. (2024). Environmental impact of different Mediterranean technological systems for European sea bass (Dicentrarchus labrax) and Gilthead sea bream (Sparus aurata) farming. Aquacultural Engineering, 107: 102457.
Articoli pubblicati su riviste tecnico-scientifiche e divulgative
Angeli D., Turrini L., Zeni F., Roman Villegas T. (2024). Effect of postharvest treatments on physiological disorders of ‘Galant’: a new scab resistant apple cultivar. Acta Horticulturae, (1386): 1-4.
Baldessari M., Acler A., Facchini T., Caset D., Rizzolli W., Pettiti F., Nari L. (2024). Agronomia e difesa fitosanitaria contro l’afide lanigero del melo. L’Informatore Agrario, (10): 39-44.
Baldessari M., Tomasi C., Zanoni S., Chiesa S.G., Acler A., Facchini T., Caset D., Rizzolli W., Castegnaro M., Tosi L. (2024).
Pirimicarb contro afide lanigero: efficacia, selettività e residualità. L’Informatore Agrario, 11: 67-70.
Bondesan D., Rizzi C., Angeli G., Ioriatti C., Grella M., Mozzanini E., Balsari P. (2024). La difesa dei meleti montani con impianti sovrachioma. L’Informatore Agrario, 37: 45-48.
Brizio C., Di Palma A., Fontana P., Massa B. (2024).
Methodological approach for recognition of species from 0 kHz - 12 kHz nocturnal PAM recordings: the case of Orthoptera. Atti della Accademia Roveretana degli Agiati. Classe di Scienze Matematiche, Fisiche e Naturali, anno 274, Vol. VI, B(Ser. X): 137-189.
Celotti E., Natolino A., Roman Villegas T., Gallo A. (2024).
Le proteine del lievito: ulteriore strumento per la stabilità proteica dei vini. Rivista di Viticoltura e di Enologia (2): 47-60.
Ciutti F., Carnevali L., Agostini A., Chemello A., Faccenda F., Cappelletti C. (2024).
Specie esotiche invasive di rilevanza unionale. Il Pescatore Trentino, 2: 6-13.
Fontana P. (2024).
Natura magistra. L’Apicoltore italiano, (1): 41-45.
Fontana P. (2024).
Oltre il superorganismo: riflessioni sulla storia naturale di Apis mellifera Linnaeus, 1758. Entomata, 23: 18-29.
Fontana P., Zanotelli L. (2024).
Benedetti fuchi: composizione e sviluppo del superorgansimo alveare. L’Apicoltore italiano, (5): 40-46.
Fontana P., Zanotelli L. (2024).
Chi ha paura delle colonie selvatiche di ape mellifera L’Apicoltore italiano, (8): 39-46.
Fontana P., Zanotelli L. (2024).
L’ape mellifera è un pendolare: siti di nidificazione e siti di foraggiamento. L’Apicoltore italiano, (2): 45-50.
Fontana P., Zanotelli L. (2024). L’apiario naturale e la famiglia allargata di alveari. L’Apicoltore italiano, (3): 40-46.
Fontana P., Zanotelli L. (2024).
La Natura può salvare l’apicoltura? L’importanza delle colonie selvagge e di un approccio più naturale in apicoltura. L’Apicoltore italiano, (9): 35-41.
Fontana P., Zanotelli L. (2024).
La sciamatura non è una malattia. L’Apicoltore italiano, (6): 34-40.
Fontana P., Zanotelli L. (2024).
Le meraviglie del favo naturale. L’Apicoltore italiano, (4): 32-38.
Fontana P., Zanotelli L. (2024).
Una Apis nulla Apis: le colonie selvatiche e la conservazione delle sottospecie e delle popolazioni locali. L’Apicoltore italiano, (7): 38-44.
Franchi R., Iussig G., Silvestri A. (2024).
Monitoraggio permanente della qualità dei foraggi: al via la raccolta delle adesioni. L’Allevatore trentino, XLV(5): 20.
Frittoli E., Iussig G. (2024).
La stagione foraggera 2023 in Trentino. L’Allevatore trentino, XLV(1): 13-16.
Guzzon R. (2024).
Gestione microbiologica delle botti: strategie tradizionali e innovative. VVQ, (1): 68-71.
Guzzon R. (2024).
Gli acidi organici e i microrganismi dei mosti e dei vini: un rapporto complesso. Millevigne, (2): 30-33.
Guzzon R. (2024).
Nuovi lieviti per nuovi vini: dalla selezione al miglioramento dei lieviti enologici tra passato e futuro. Millevigne, (4): 28-31.
Guzzon R. (2024).
I batteriofagi in enologia. VVQ, (8): 64-68.
Guzzon R. (2024).
Lieviti e alcol da problema a soluzione? VVQ, (2): 34-39.
Guzzon R. (2024).
Lieviti non-Saccharomyces, opportunità e limiti nella filiera enologica. Vite & Vino, (5): 2-8.
Guzzon R. (2024).
Terroir microbico del vigneto, tra pratiche agronomiche e variabili ambientali. Vite & Vino, (4): 2-6.
Guzzon R. (2024).
Un naufrago in bottiglia. VVQ, (5): 22-26.
Guzzon R. (2024).
Una specie minore alla conquista del vino. VVQ, (5): 16-21.
Guzzon R., Facchinelli G., Paolini M., Roman Villegas T., Larcher R. (2024).
Soluzioni efficaci per una corretta fermentazione malolattica. Vite & Vino, (2): 44-49.
Hauffe H.C., Komjanc M., Partel E, (2024).
Conoscere la genetica della razza Rendena per la sua salvaguardia. Agricoltura Trentina, 43: 19.
Ioriatti C., Mazzoni V., Anfora G., Gelmetti A. (2024).
Integrated grape production in Trentino (Northern Italy): where are we after thirty years since its first implementation?. IOBC/WPRS Bulletin, 171: 51-56.
Iussig G. (2024).
La stagione foraggera 2024 in Trentino”. Terra Trentina, 63(2): 74.
Iussig G. (2024). Giornata tecnica ovicaprini. L’Allevatore trentino, XLV(3): 12.
Micheli F., Iob C., Coller E., Moser D. (2024).
Innovazione in melicoltura: sistemi multiasse a confronto. L’Informatore Agrario, 37: 40-44.
Pantezzi T., Gottardello A., Franchini S., Dallabetta N. (2024). A comparison of sweet cherry planting systems and orchard tree densities in the northern Italian region of Trentino (Italy). Acta Horticulturae, 1408: 317-324.
Pantezzi T., Gottardello A., Franchini S., Zago M., Gatti G., Folini L., Draicchio P. (2024). Sweet cherry rootstock evaluations in a sub-alpine environment. Acta Horticulturae, 1408: 237-244.
Penner F., Gelmetti A., Robol F., Trainotti N., Guaita Algarra R., Secchi M. (2024). Importanza del monitoraggio nella gestione della flavescenza. L’Informatore Agrario, 17: 54-57.
Roner I., Mazzucchi M., Partel E., Sandri N., Iussig G. (2024). Escherichia coli STEC: un patogeno da imparare a conoscere. L’Allevatore trentino, XLV(4): 14-20.
Roner I., Mazzucchi M., Partel E., Sandri N., Iussig G. (2024). Quanto la gestione può limitare la presenza di E. coli Stec in stalla. Stalle da latte, (5): 44-48. Salmaso N., Cappelletti C., Ciutti F. (2024). Ecologia degli ambienti acquatici. Terra Trentina, 63(1): 26.
Schiavon S., Mazzucchi M., Iussig G., Roman Villegas T. (2024). Concorsi formaggi di malga: i concorsi dei formaggi di malga, un volano per la valorizzazione di prodotto e la crescita della professionalità in malga. L’Allevatore trentino, XLV(6): 18-20.
Soppelsa S., Gasser M., Zago M., Martinatti P., Pantezzi T., Carli C., Giordano R. (2024). La fragolicoltura in ambiente montano conquista nuovi spazi. Rivista di Frutticoltura e di Ortofloricoltura, 87(3): 35-41.
Tavella L., Cottura M., Fassio A., Baldessari M., Tomasi C., Zanoni S., Chiesa S.G. (2024). Afide lanigero e suo parassitoide: biologia e fattori di disturbo. L’informatore Agrario, 10: 35-38.
Tonina L., Maresi G., Endrizzi E., Angeli G. (2024). Paysandisia, le palme del Trentino sono in pericolo. Terra Trentina, 63(1): 8-9.
Tonina L., Santoiemma G., Dal Zotto G. (2024). Il moscerino dei piccoli frutti Drosophila suzukii: l’insetto e il paesaggio, diffusione e gestione nel Nord Italia. Natura Alpina, 1-2: 25-42.
Turrini L., Paolini M., Zeni F., Tonidandel L., Angeli D., Larcher R., Roman Villegas, T. (2024). Evaluation of an optimized enzymatic biosensor for ethanol used in apple storage management with low oxygen stress. Acta Horticulturae, (1386): 379-384.
Waldner A., Dallago G., Porro D. (2024). Un approccio innovativo alla nutrizione del melo. L’Informatore Agrario, 12: 43-46.
Waldner A., Torresani R. (2024). Nuove varietà di melo, risposte al diradamento chimico. L’Informatore Agrario, 14: 41-45.
Zanzotti R., Chiusole M., Bertoldi D., Maines R., Morelli R., Prodorutti D. (2024). Riduzione del dosaggio rameico possibile ed efficace. L’Informatore Agrario, 9: 61-64.
Contributi a convegni pubblicati
Baldessari M., Tomasi C., Chiesa S.G., Zanoni S., Guarnone A. (2024).
Evidenze sperimentali sull’efficacia di azadiractina nel contenimento di afide lanigero del melo e selettività nei confronti del parassitoide Aphelinus mali. In: Giornate Fitopatologiche 2024: qualità delle piante, qualità, ambiente, Bologna, 12-15 marzo 2024: 81-90.
Bargna S., Coller E., Zanoni S., de Concini M., Corradini S., Prodorutti D., Angeli G. (2024). Scopazzi del melo: correlazione tra malattia e vetustà delle piante. In: Giornate Fitopatologiche 2024: qualità delle piante, qualità, ambiente, Bologna, 12-15 marzo 2024: 341-348.
Bibbiani C., Tonasso R., Gentili M., Fronte B., Rossi L. (2024).
Integrated monitoring and control system for oxygen distribution in a land-based aquaculture facility. In: 2024 IEEE International Workshop on Metrology for Agriculture and Forestry (MetroAgriFor), Padova, 29-31 ottobre 2024: 501-506.
Bona D., Bertoldi D., Silvestri S., Iussig G. (2024).
From soil to forage in Alpine region: three-year monitoring of nutrient and organic carbon circularity in mountain permanent meadows. In: Centennial Celebration and Congress of the International Union of Soil Sciences: 100 years of soil science: past achievements and future challenges, Florence, Italy, 19-21 May 2024: 1141.
Bona D., Bertoldi D., Zaccone C., Borgonovo G., Mazzini S., Silvestri S., Tambone F. (2024). Some effects of hydrochar, compost and their mix on soil organic carbon and nutrients. In: Centennial Celebration and Congress of the International Union of Soil Sciences: 100 years of soil science: past achievements and future challenges, Florence, Italy, 19-21 May 2024: 304.
Bondesan D., Baldessari M., Clappa E., Rizzi C. (2024). Applicazioni localizzate alla parte basale del tronco per il controllo dell’afide lanigero del melo (Eriosoma lanigerum). In: Giornate Fitopatologiche 2024: qualità delle piante, qualità, ambiente. Bologna, 12-15 marzo 2024: 143-150.
Bondesan D., Ganarin G., Miorelli P., Rizzi C., Angeli G. (2024). Investigations on spray drift mitigation by means of artificial barriers in high tunnel strawberries. In: 16th Slovenian conference on plant protection with international participation. Bohinjska Bistrica (Slovenija), March 5-6, 2024. Ljubljana: Društvo za varstvo rastlin Slovenije: 191-196.
Bondesan D., Grella M., Rizzi C., Mozzanini E., Balsari P., Angeli G., Ioriatti C. (2024). Sistemi a punto fisso per la difesa del melo dalla ticchiolatura (Venturia inaequalis): primi risultati. In: Giornate Fitopatologiche 2024: qualità delle piante, qualità, ambiente. Bologna, 12-15 marzo 2024: 433-440.
Bonini A., Tamaño G., Fariña L., Boido E., Dellacassa E., Pianezze S., Perini M. (2024).
Avances en la identificación de mieles: variabilidad de las relaciones isotópicas estables de mieles mono y poliflorales de la zona citrícola de Salto/Concordia y de zonas costeras uruguayas. In: CUQA 8: Congreso Uruguayo de Química Analítica. Montevideo, Uruguay, 13 -15 de Noviembre de 2024: 62-63.
Brizio C., Di Palma A., Fontana P., Massa B. (2024).
Passive acoustic monitoring as a possible method to detect night-singing Orthoptera. In: Fourth European Congress on Orthoptera Conservation (ECOC IV), 4-6 July 2024. Rovereto (TN): Fondazione Museo Civico di Rovereto: 41.
Cappelletti C., Salmaso N., Boscaini A., Manfrini M., Faccenda F., Ciutti F. (2024).
Identification of reliable metrics to assess the effects of trout farming on biological water quality in Alpine rivers (Trentino Province): integration of morphological and DNA metabarcoding approaches. In: XXVIII Congresso AIOL: Acqua: elemento vitale, risorsa essenziale: condividere le conoscenze per affrontare il cambiamento, Lecco, 24-28 giugno 2024: Associazione Italiana di Oceanologia e Limnologia (AIOL): 79.
Cappelletti C., Ciutti F. (2024).
Alien species in Lake Garda. In: Euregio Biodiversity Research Conference 2024, EUBIRECO, Bolzano, 22-23 novembre 2024: 49-50.
Cappello N., Savastano R., Paolini M., Amato F., Fouquet E., Vivas N., Francesca N., Schiavon S., Guzzon R., Larcher R., Roman Villegas T. (2024).
Effect of varied Kluyveromyces marxianus-to-Saccharomyces cerevisiae coinoculum ratio on the aroma composition of Gewürztraminer wines. In: 38th EFFoST International Conference 2024: Future Food Systems: Innovation through Progress at Scientific Interfaces, Bruges, Belgium, 12-14 November 2024: P2.3.041.
Carrau F., Valera M.J., Boido E., Gallo A., Roman Villegas T., Schneider R., Dellacassa E. (2024). Mixed cultures of Hanseniaspora vineae and Saccharomyces cerevisiae: the compromise between completing fermentation and increasing wine flavor complexity. In: 16th International congress on yeasts 2024, Cape Town (South Africa), September 29-October 3, 2024: 24.
Celotti E., Roman Villegas T., Gallo A., Larcher R., Damijanić K., Staver M., Dminić Rojnić I., Šegon P., Natolino A. (2024).
Yeasts protein extracts: new low impact tool for wine protein stability. In: 45th Word Congress of Vine and Wine, Dijon, France, 14-18 October 2024.
Checola G., Sonego P., Zorer R., Mazzoni V., Ghidoni F., Gelmetti A., Franceschi P. (2024).
A novel dataset and deep learning object detection benchmark for grapevine pest surveillance. In: Open International Conference on Grapevine Physiology and Biotechnology (Open-GPB2024), Logroño-La Rioja, July 7-11, 2024.
Chemello A., Ciutti F., Salmaso N., Boscaini A., Manfrin M., Faccenda F., Cappelletti C. (2024).
Morphological and DNA metabarcoding approaches to identify reliable metrics for the assessment of trout farming-related effects on biological water quality in Alpine rivers. In: Euregio Biodiversity Research Conference 2024, EUBIRECO, Bolzano, 22-23 novembre 2024: 51-52.
Chen L., Khatri P.K., Paolini M., Larcher R., Ziller L., Magdas D.A., Marincas O., Roncone A., Bontempo L. (2024).
Stable isotope ratio analysis of volatile organic compounds for the botanical characterization and authentication of lavender essential oil. In: The 4th MS-NatMedDay, Salerno, 15-16 febbraio 2024. Università degli studi di Salerno: 43.
Chiesa S.G., Tomasi C., Zanoni S., Sofia M., Clappa E., Ruocco G., Angeli G., Baldessari M. (2024). Prove di efficacia di alcuni insetticidi su Scaphoideus titanus in sperimentazione di semicampo. In: Giornate Fitopatologiche 2024: qualità delle piante, qualità, ambiente, Bologna, 12-15 marzo 2024: 169-175.
Ciutti F., Blanco S., Obertegger U., Bertoli M., Pizzul E., Pastorino P., Prearo M., Cappelletti C. (2024). Exploring benthic diatom diversity in a high-altitude lake. In: XXVIII Congresso AIOL: Acqua: elemento vitale, risorsa essenziale: condividere le conoscenze per affrontare il cambiamento, Lecco, 24-28 giugno 2024: 110.
Dalmaso G., Baldessari M. (2024).
Diffusion and host preference of Orientus ishidae (Hemiptera: Cicadellidae) in Norther Italy apple orchards. In: In: 16th Slovenian conference on plant protection with international participation. Bohinjska Bistrica (Slovenija), March 5-6, 2024. Ljubljana: Društvo za varstvo rastlin Slovenije: 508-513.
Devetak M., Hoblaj S., Jančar M., Rot M., Baldessari M., Malagnini V., Pedrazzoli F. (2024). First report of the species Aculus olearius Castagnoli (Eriophyidae) on olive crops in Slovenia. In: 16th Slovenian conference on plant protection with international participation. Bohinjska Bistrica (Slovenija), March 5-6, 2024. Ljubljana: Društvo za varstvo rastlin Slovenije: 143-147.
Fontana P. (2024).
Records on the possible effect of climate changes on the distribution of some orthopteroid insects. In: Fourth European Congress on Orthoptera Conservation (ECOC IV), 4-6 July 2024. Rovereto (TN): Fondazione Museo Civico di Rovereto: 20-21.
Forte F., Ortego J., Trillo M., Freda F., Bologna M.A., Massa B., Fontana P., Riccieri A. (2024). An integrative taxonomy approach towards the conservation of the Italian endemic genus Italopodisma Harz, 1973 (Orthoptera: Acrididae). In: Fourth European Congress on Orthoptera Conservation (ECOC IV), 4-6 July 2024. Rovereto (TN): Fondazione Museo Civico Rovereto: 48-49.
Forte F., Trillo M., Freda F., Bologna M.A., Massa B., Fontana P., Riccieri A., Ortego J. (2024).
Taxonomic and conservation genomic assessment of the Italian endemic genus Italohippus Fontana & La Greca, 1999 (Orthoptera: Acrididae). In: Fourth European Congress on Orthoptera Conservation (ECOC IV), 4-6 July 2024. Rovereto (TN): Fondazione Museo Civico di Rovereto: 49-50.
Gallo A., Roman Villegas T., Celotti E., Paolini M., Natolino A., Tonidandel L., Barbero A., Nardin T., Marangon M., Curioni A., Larcher R. (2024).
The use of aspergillopepsin-I in winemaking. In: 13th In Vino Analytica Scientia: analytical chemistry for wine, brandy and spirits, Davis, CA, July 9-12, 2024: 74.
Gallo A., Roman Villegas T., Larcher R., Schneider R., Barbero A., Tonidandel L., Pradal M., Farines V., Galeote V. (2024).
The expression of STR3 and IRC7 are differently affected by oxygen addition during fermentation. In: 16th International congress on yeasts 2024, Cape Town (South Africa), September 29-October 3, 2024: 64.
Gallo A., Roman Villegas T., Larcher R., Schneider R., Tonidandel L., Barbero A., Farines V., Pradal M., Galeote V. (2024).
Influence of organic nitrogen supplementation on yeast gene expression and volatile thiol composition of wines. In: 16th International congress on yeasts 2024, Cape Town (South Africa), September 29-October 3, 2024: 63.
Gallo A., Roman Villegas T., Paolini M., Celotti E., Natolino A., Tonidandel L., Barbero A., Nardin T., Schneider R., Larcher R. (2024).
Does treatment of grape juice with aspergillopepsin-i influence wine aroma? In: 45th Word Congress of Vine and Wine, Dijon, France, 14-18 October 2024.
Gattolin A., Antonelli F., Franceschi P., Paolucci F., Corradini S., Zottele F. (2024).
IRRITRE: Infrastruttura e strumenti per l’irrigazione in Trentino. In: XXVI Convegno Nazionale di Agrometeorologia: approcci innovativi a supporto delle produzioni agrarie in un contesto climatico in evoluzione, L’Aquila, June 5-7, 2024: 133-135.
Grio M., Fontana P. (2024).
The brief history of orthopterology in Italy and the birth of the GRIO (Gruppo di Ricerca Insetti Ortotteroidei - Research Group for Orthopteroid Insects). In: Fourth European Congress on Orthoptera Conservation (ECOC IV), 4-6 July 2024. Rovereto (TN): Fondazione Museo Civico di Rovereto: 50-51.
Guzzon R., Roman Villegas T., Tatti A., Rota Stabelli O., Larcher R. (2024).
Exploring the genomic diversity of yeast involved in spontaneous fermentation: from studies to select autochthonous strains of different Italian wineries to extensive phylogenetic survey about the Italians’ population of S. cerevisiae. In: 45th Word Congress of Vine and Wine, Dijon, France, 14-18 October 2024.
Ioriatti C., Mazzoni V., Chiesa S.G., Angeli G., De Concini M., Panizza C., Zapponi L., Anfora G. (2024).
Classical biological control of BMSB in apple orchard, a successful story?. In: ICE 2024: XXVII International congress of Entomology: new discoveries through consilience, Kyoto, Japan, August 25-30, 2024.
Larcher R., Dekker S., Nardin T. (2024).
Evidence of the correlation between the oxygen radical absorbance capacity (ORAC) and the potential development of atypical aging (ATA) in white wines. In: 5th MS-Wine Day: Traces in the glass mass spectrometry for quality and profiling in wines, fermented beverages, and distillates, Asti, Italy, May 22-24, 2024: 27.
Larcher R., Vinotti G., Martinelli F., Nardin T. (2024).
Comparative analysis of carotenoid and fat-soluble vitamin content in dairy products: a comparison between Alpine and industrial products. In: 10th International Conference on Food Chemistry & Technology, Valencia, Spain, November 25-27, 2024: 66.
Larcher R., Vinotti G., Martinelli F., Nardin T. (2024).
Comparative study of carotenoid and fat-soluble vitamin levels in alpine vs. industrial dairy products. In: 8th MS Food Day, Torre Canne (BR), Italy, October 16-18, 2024: 230-231.
Litrenta F., Perini M., Cavallo C., Pianezze S., Lo Turco V., Potorti A.G., Di Bella G., Liotta L. (2024). Use of chemical and isotopic fingerprints to establish the geographical origin of “Nero dei Nebrodi” pig meat. In: 11th International Symposium on Recent Advances in Food Analysis (RAFA-2024), Prague, Czech Republic, November 5-8, 2024. Praha: University of Chemistry and Technology: 247.
Longa C.M., Maresi G. (2024).
Seed-borne fungi associated with tree-of-heaven (Ailanthus altissima (Mill.) Swingle). In: 12th International Mycological Congress (IMC12), Maastricht, NL, 11-15 August 2024: 415.
Malacarne M., Tonidandel L., Barbero A., Larcher R. (2024).
Influence of the de-alcoholisation process on pesticide residues in de-alcoholised wines. In: 15th European Pesticide Residue Workshop, Zürich, Switzerland, 16-20 September 2024: 249.
Malossini U. (2024).
Presence and spread of grapevine yellows and esca disease complexes in two contiguous vineyards (cv Pinot b. and Nosiola) in Trentino. In: XXIX Congress of the Italian Phytopathological Society: New challenges in Plant Pathology between sustainable crop production and climate change, Trento, 9-11 September 2024: 165.
Malossini U., Bianchedi P., Bragagna P., Gualandri V. (2024).
Risultati pluriennali di prove di trasmissione in campo con viti indicatrici innestate su viti infette testate sierologicamente per i virus ARMV, GFLV, GLRaV-1, GLRaV-3, GVA, GFKV. In: Giornate Fitopatologiche 2024: qualità delle piante, qualità, ambiente, Bologna, 12-15 marzo 2024: 349-354.
Malossini U., Bianchedi P., Faralli M., Ferrazza M., Moscon R., Roman Villegas T., Porro D. (2024).
Caratteristiche vegeto produttive di sei cloni di Pinot bianco coltivati in un vigneto in Trentino (20182023). In: CONAVI 2024: X Convegno Nazionale di Viticoltura, Alghero, 11-13 giugno 2024: 32.
Martinatti P., Ganarin G., Miorelli P., Brentari L., Pantezzi T. (2024). Substrati organici per fragola fuori suolo da prodotti derivati: primi test su materiali disponibili in Trentino. In: Giornata Tecnica SOI sui Substrati Colturali, Passariano (UD), 24 settembre 2024.
Mattedi C., Zottele F., Centurioni F., Caffarra A., Corradini S. (2024).
Coupling stem water potential and soil water potential on irrigated and not irrigated vines: preliminary results for Vitis vinifera L. cv Teroldego. In: XXVI Convegno Nazionale di Agrometeorologia: approcci innovativi a supporto delle produzioni agrarie in un contesto climatico in evoluzione, L’Aquila, June 5-7, 2024: 123-128.
Mazzucchi M., Peterlini M. (2024). Sostenibilità economica degli allevamenti trentini da latte. In: XIV Convegno SoZooAlp - Allevamenti montani sostenibili: nuove generazioni, nuove prospettive. Quaderno SoZooAlp, 12/2024: 25-39.
Morelli R., Bertoldi D., Chiusole M., Maines R., Prodorutti D., Zanzotti R. (2024). Fertilizzazione dell’erbaio da sovescio: una strategia per ottimizzare la nutrizione del vigneto. In: CONAVI 2024: X Convegno Nazionale di Viticoltura, Alghero, 11-13 giugno 2024: 88.
Morelli R., Zanoni S., Bona D., Prodorutti D., Bertoldi D., Cristoforetti A., Pedò S., Zanzotti R. (2024). Nutrition of apple orchard with livestock-derived fertilisers: dynamics and losses of soil mineral nitrogen. In: Centennial Celebration and Congress of the International Union of Soil Sciences, Florence - Italy, May 19-21, 2024: 1359.
Morpurgo M., Marrone F., Ciutti F., Cappelletti C., Vorhauser S., Alber R., Dossena M., Salmaso N., Fontaneto D., Caputo L., Vecchioni L. (2024).
The freshwater jellyfish Craspedacusta sowerbii species complex (Cnidaria, Olindiidae) in Italy: distribution and genetic lineages. In: Euregio Biodiversity Research Conference 2024, EUBIRECO, Bolzano, 22-23 novembre 2024: 58.
Mozzanini E., Grella M., Marucco P., Bondesan D., Ioriatti C., Balsari P., Gioelli F. (2024).
Confronti preliminari tra differenti layout di un sistema a punto fisso per l’applicazione dei prodotti fitosanitari in vigneto. In: Giornate Fitopatologiche 2024: qualità delle piante, qualità, ambiente, Bologna, 12-15 marzo 2024: 423-432.
Mucci M., Giuliani G., Tomasi C. (2024).
Valutazione di prodotti alternativi per ridurre il potenziale ascosporico di Venturia inaequalis. In: Giornate Fitopatologiche 2024: qualità delle piante, qualità, ambiente, Bologna, 12-15 marzo 2024: 193-200.
Mucci M., Waldner A. (2024).
Laminarina e zolfo nel contenimento dell’oidio del melo in Trentino. In: Giornate Fitopatologiche 2024: qualità delle piante, qualità, ambiente, Bologna, 12-15 marzo 2024: 111-118.
Nardin T., Franceschini J., Martinelli F., Larcher R. (2024).
Investigating nitrosamine formation in meat: effects of cooking, digestion, and preservatives. In: 10th International Conference on Food Chemistry & Technology, Valencia, Spain, November 25-27, 2024: 51.
Nardin T., Dekker S., Roman T., Martinelli F., Larcher R. (2024).
Exploring polysulfides in wine: formation, degradation and implications for quality. In: 5th MS-Wine Day: Traces in the glass mass spectrometry for quality and profiling in wines, fermented beverages, and distillates, Asti, Italy, May 22-24, 2024: 29.
Nardin T., Martinelli F., Larcher R. (2024).
New approach to traceability of oenological tannin origin: high-resolution mass suspect screening study. In: 5th MS-Wine Day: Traces in the glass mass spectrometry for quality and profiling in wines, fermented beverages, and distillates, Asti, May 22-24, 2024: 49.
Nardin T., Franceschini J., Martinelli F., Larcher R. (2024).
Exploring nitrosamine formation in meat: impact of cooking, digestion, and preservation. In: 8th MS Food Day, Torre Canne (BR), Italy, October 16-18, 2024: 93-94.
Natolino A., Roman Villegas T., Voce S., Tat S., Celotti E., Comuzzo P. (2024).
Chitosan from mushroom by-products: sustainable extraction process and winemaking application. In: 45th Word Congress of Vine and Wine, Dijon, France, 14-18 October 2024.
Obertegger U., Corradini S., Cerasino L., Weiss L.C. (2024).
A long-term perspective on hypolimnetic dissolved oxygen and surface CO2? Case study mountain Lake Tovel. In: Euregio Biodiversity Research Conference 2024, EUBIRECO, Bolzano, 22-23 novembre 2024: 26.
Obertegger U., Corradini S., Cerasino L., Weiss L.C. (2024).
Mixing drives hypolimnetic dissolved oxygen, but what about CO2? Case study mountain Lake Tovel. In: XXVIII Congresso AIOL: Acqua: elemento vitale, risorsa essenziale: condividere le conoscenze per affrontare il cambiamento, Lecco, 24-28 giugno 2024: 36.
Paolini M., Chen L., Roncone A., Nardin T., Bontempo L., Larcher R. (2024).
Characterization of the natural vanilla samples of different botanical and geographical origin based on the aromatic profile. In: 8th MS Food Day, Torre Canne (BR), October 16-18, 2024: 152.
Paolini M., Gallo A., Cappello N., Larcher R., Roman Villegas T. (2024).
The volatile composition of wine is affected by the Hanseniaspora vineae-to-Saccharomyces cerevisiae inoculum ratio. In: 5th MS-Wine Day: Traces in the glass mass spectrometry for quality and profiling in wines, fermented beverages, and distillates, Asti, 22-24 maggio 2024: 20.
Paolini M., Roman Villegas T., Cisilotto B., Moser S., Cappello N., Larcher R. (2024).
Base wines for sparkling wine from resistant varieties: effect of the altitude on the aromatic profile. In: 5th MS-Wine Day: Traces in the glass mass spectrometry for quality and profiling in wines, fermented beverages, and distillates, Asti, 22-24 maggio 2024: 47.
Perini M., Pianezze S. (2024).
Analisi degli isotopi stabili: un valido strumento per garantire l’autenticità di composti fitoterapici e nutraceutici. In: Piante e Salute: tra evidenze e criticità: incontro tra ricerca e aziende, Padova, 20 settembre 2024.
Perini M., Pianezze S. (2024).
Applicazione degli isotopi stabili di bioelementi a supporto dell’analisi forense. In: 4th MS Forensics 2024: L’errore nell’ambito delle applicazioni di chimica forense, Roma, 21-22 marzo 2024: 29.
Perini M., Pianezze S. (2024).
How to guarantee authenticity and traceability of agri-food and supplements products thanks to the application of isotopic analysis of bioelements. In: Benelux Association of Stable Isotope Scientists (BASIS) Annual Meeting 2024, Amsterdam, 24-25 April 2024: 19-20.
Perini M., Guzzon R., Violardo F., Pianezze S., Larcher R. (2024).
Correlation between stable isotopic composition of the fungus Aspergillus niger and its growth substrate and the extracted chitin. In: 45th World Congress of Vine and Wine, Dijon, 14-18 October 2024 (IVES Conference Series).
Pianezze S., Perini M., Masuero D., Carpino S., Barilaro N., Di Martino V., Bontempo L. (2024).
Stable isotope ratio analysis to detect biosynthetic citric acid addition to Italian tomato sauce. In: 8th MS Food Day, Torre Canne (BR), October 16-18, 2024: 249-250.
Prodorutti D., Bugiani R., Rizzi C., Coller E., Vendrame N., Zardi D., Stensvand A., Philion V., Pertot I. (2024).
Release of Venturia inaequalis ascospores induced by sprinkler irrigation on sunny days results in a lower risk of primary infections. In: XXIX Congress of the Italian Phytopathological Society, Trento, 9-11 September 2024: 36.
Roman Villegas T., Cappello N., Dell’Oca D., Natolino A., Celotti E., Larcher R., Gallo A. (2024). Long-term memory of experts for the definition of wine aroma descriptors of resistant varieties. In: 38th EFFoST International Conference 2024: Future Food Systems: Innovation through Progress at Scientific Interfaces, Bruges, Belgium, 12-14 November 2024: P2.1.029.
Rossi L., Zoli M., Giocapelli F., Bacenetti J. (2024). How Agriculture 4.0 solutions can reduce the environmental impact of viticulture? In: 2024 IEEE International Workshop on Metrology for Agriculture and Forestry (MetroAgriFor), Padova, 29-31 ottobre 2024: 478-481.
Rossi Stacconi M.V., Anfora G., Grassi A., Fellin L., Puppato S., Ioriatti C. (2024). Prospects and constraints in the implementation of Drosophila suzukii classical biological control in Italy four years after the first release. In: Tavola Rotonda Accademia Nazionale Italiana di Entomologia “Biological Control of threats to the biosecurity of agricultural and forestry systems: Italian Projects and Innovative Strategies”, Napoli, Italy, 14 giugno 2024: 133-136.
Santoro E., Cliceri D., Faralli M., Roman Villegas T., Carlin S., Bertamini M., Gasperi F. (2024). Effetto della gestione della chioma in vigneto sul profilo sensoriale di vini rossi. In: VIII Convegno nazionale SISS, Alghero, 22-24 maggio 2024: 53.
Solovyev P., Franceschi P., Perini M., Bontempo L. (2024).
Utilizzo della spettroscopia RMN nell’analisi dei mosti d’uva. In: VIII Workshop Applicazioni della risonanza magnetica nella scienza degli alimenti, Roma, 20-21 giugno 2024.
Tami F., Fontana P., Tirello P. (2024).
Orthoptera species widespread in Friuli Venezia Giulia region but rare or absent in most of Italy. In: Fourth European Congress on Orthoptera Conservation (ECOC IV), 4-6 July 2024. Rovereto (TN): Fondazione Museo Civico di Rovereto: 57.
Tatti A., Longa C.M., Pedrazzoli F., Turroni L., Padovani C., Mazzoni V., Segata N., Guzzon R., Rota Stabelli O. (2024).
Exploring the genomic diversity of wild S. cerevisiae wine strains in spontaneous fermentation. In: 12th International Mycological Congress (IMC12), Maastricht, NL, 11-15 August 2024: 436.
Tonidandel L., Barbero A., Suman M., Giannioti Z., Bontempo L., Larcher R. (2024). Behavior of pesticide residues in the transition from wheat to related baked products. In: 15th European Pesticide Residue Workshop, Zürich, Switzerland, 16-20 September 2024: 248.
Tonina L., Zanettin G., Puppato S., Grassi A., Miorelli P., Tolotti G., Angeli G., Pantezzi T. (2024). Esperienze di gestione integrata di Anthonomus rubi su fragola in Trentino. In: Giornate Fitopatologiche 2024: qualità delle piante, qualità, ambiente, Bologna, 12-15 marzo 2024: 185-198.
Waldner A., Dallago G. (2024).
Valutazione dell’attività erbicida e spollonante di un nuovo formulato a base di pyraflufen etile+cletodim su melo. In: Giornate Fitopatologiche 2024: qualità delle piante, qualità, ambiente, Bologna, 12-15 marzo 2024: 301-310.
Waldner A., Dallago G. (2024).
Verifica dell’efficacia spollonante ed erbicida di una formulazione di acido pelargonico su melo in Trentino. In: Giornate Fitopatologiche 2024: qualità delle piante, qualità, ambiente, Bologna, 12-15 marzo 2024: 311-320.
Zanoni S., Branz A., Rizzi E., Coller E., Baldessari M. (2024).
Syrphid releasing vs Eriosoma lanigerum: preliminary results. In: 16th Slovenian conference on plant protection with international participation. Bohinjska Bistrica (Slovenija), March 5-6, 2024. Ljubljana: Društvo za varstvo rastlin Slovenije: 469-475.
Zanoni S., Tomasi C., Baldessari M., Chiesa S.G. (2024).
Susceptibility of aphid parasitoid Aphelinus mali (Haldeman) to different active ingredients commonly used in organic apple orchards in Trentino (North Italy). In: 16th Slovenian conference on plant protection with international participation. Bohinjska Bistrica (Slovenija), March 5-6, 2024. Ljubljana: Društvo za varstvo rastlin Slovenije: 461-468.
Zanzotti R., Roman Villegas T., Prodorutti D., Bertoldi D., Morelli R. (2024). Esperienza pluriennale di confronto tra gestioni agronomiche in vigneto. In: CONAVI 2024: X Convegno Nazionale di Viticoltura, Alghero, 11-13 giugno 2024: 105.
Monografie e capitoli di libro
Bondesan D., Miorelli P., Rizzi C., Angeli G. (2024).
Further investigations on spray drift mitigation by means of artificial barriers in high tunnel strawberries. In: International Advances in Pesticide Application (editor(s) Balsari P., Buttler Ellis C., Cooper S., Gil E., Glass R., Magri B., Mountfort Smith C., Nuyttens D., Thomas J., Van de Zande J.). Warwick UK: the Association of Applied Biologists (Aspects of applied biology): 278-285.
Fontana P., Malagnini V. (2024).
La fabbrica del miele: dal fiore alla tavola. In: Generazione Honey: viaggio alla scoperta del miele prodotto da api italiane: se è italiano vale di più (editor(s) Agra editrice). Roma: Agra: 19-24.
Fontana P. (2024).
Dialogo al “METS” 2. In: Tradizione, Diversità, Cambiamento 2.: Migrazione, pluralità e cambiamento come parti integranti delle identità culturali e delle tradizioni nelle regioni alpine: relazione finale (editor(s) Emeri D., Zambaldi D.) Salzburg: Robert Jungk Bibliothek für Zukunftsfrage (JBZ-Arbeitspapiere): 33-34.
Fontana P. (2024).
Coleotteri e api. In: Passione per i Coleotteri (editor Mezzalira F.). Vicenza: Ronzani: 34-46.
Fontana P. (2024).
Tutti vogliono salvare le api: api, apicoltura e biodiversità. Verona: WBA Project.
Franchi R. (2024).
La realtà di Agri90 di Storo. In: I cereali in Trentino: storie di antiche coltivazioni e di nuove opportunità (a cura di Bleggi D., Menguzzato A., Eccel E.), Trento: Provincia autonoma di Trento: 53-55.
PRODOTTI EDITORIALI
Notiziario tecnico del Centro Trasferimento Tecnologico della Fondazione Edmund Mach
Direttore responsabile: Silvia Ceschini Direttore Tecnico: Maurizio Bottura
Autorizzazione Tribunale di Trento n. 1 del 02.03.2018
Fondazione Mach Notizie
https://ctt.fmach.it/Divulgazione/Fondazione-Mach-Notizie
1 - 11/06/2024
Bollettini
https://ctt.fmach.it/Divulgazione/Messaggistica-tecnica-e-bollettini
difesa integrata di base
Bollettini fenologici delle specie prative
Bollettini distribuzione effluenti zootecnici nelle ZVN
- novembre
Aprile - maggio
Novembre, febbraio e marzo
Approfondimenti monografici del Centro Trasferimento Tecnologico della Fondazione Edmund Mach
//ctt.fmach.it/Divulgazione/Editoria
FRUTTICOLTURA INTEGRATA 2024.
Guida pratica alla coltivazione del melo
18 - Marzo 2024 / Barchetti D., Bertagnolli A., Berti M., Branz A., Chini L., Defant C., Delaiti L., Flaim D., Iachemet D., Iori L., Panizza C., Pezzè M., Prantil M., Rizzi E., Toniolli F., Zaffoni M., Zorzi C., Angeli D., Baldessari M., Bondesan D., Corradini S., Cristoforetti A., Gualandri V., Micheli F., Torresani R., Turrini L., Zeni F., Zottele F., Zapponi L.
Pagine 204
La Guida raccoglie le informazioni essenziali per una conduzione ottimale dei frutteti secondo la produzione integrata che sono frutto dell’esperienza sia dei tecnici consulenti che degli sperimentatori della FEM. Con questo lavoro si è voluto concentrare in un unico manuale le indicazioni che periodicamente vengono fornite ai produttori tramite i vari canali informativi. Nella Guida sono illustrate le indicazioni per controllare le principali avversità e le operazioni agronomiche utili per raggiungere la migliore produttività e qualità.
CERASICOLTURA DEL TRENTINO ALTO ADIGE. Prove sperimentali agronomiche per la coltivazione del ciliegio
19 – Ottobre 2024 / Gottardello A., Giuliani G., Pantezzi T., Gatti G., Perli I. Pagine 40
La coltura del ciliegio in Trentino-Alto Adige negli ultimi anni si è evoluta verso una coltivazione altamente specializzata che richiede sì notevoli investimenti ma che permette di ottenere produzioni di elevato valore economico e qualitativo. Per erogare un servizio ai produttori adeguato è importante il costante aggiornamento dei tecnici, reso possibile solo attraverso una stretta connessione alla sperimentazione, in particolare quando questa viene condotta negli stessi ambienti di coltivazione. La Fondazione Mach e il Centro di Sperimentazione Laimburg da diverso tempo conducono attività di sperimentazione su ciliegio orientando le linee di studio in base alle problematiche che emergono dal territorio.


PRODOTTI EDITORIALI
Monografie
//ctt.fmach.it/Divulgazione/Editoria

RAPPORTO 2023
AA. VV., Pagine 184, Rapporto di attività ISSN 20-37-7541
La quindicesima edizione del Rapporto del Centro Trasferimento Tecnologico della Fondazione E. Mach illustra in 45 relazioni tecnico-scientifiche le principali attività di sperimentazione, servizio e consulenza svolta dal personale del Centro nel 2023. Il Rapporto è corredato dalla sezione ”Attività in sintesi” che riporta i dati più significativi relativi a servizi, analisi di laboratorio e attività sperimentali, nonché l’elenco delle pubblicazioni scientifiche, tecniche e divulgative, gli eventi organizzati e dati relativi al personale del Centro.
EVENTI ORGANIZZATI 2024
7 febbraio 4a Giornata tecnica olivicoltura nelle regioni produttive Nord-Est italiano e Slovenia Arco e diretta streaming ERSA Agenzia Regionale per lo Sviluppo Rurale del Friuli Venezia Giulia, Istituto Agrario e Forestale di Nova Gorica, Università di Verona
21 febbraio 27a Giornata tecnica La frutticoltura delle Valli del Noce Cles e diretta streaming Melinda, APOT
20 marzo 10a giornata tecnica piccoli frutti
San Michele all’Adige e diretta streaming
30 luglio Porte aperte Azienda de Bellat Loc. Spagolle, Castelnuovo
1 agosto Prove sperimentali in viticoltura biologica
San Michele all’Adige e diretta streaming
21 agosto Porte aperte al frutteto sperimentale di Denno Loc. Pinè
FORMAZIONE PER ADULTI
Corsi per il rilascio / rinnovo dell’autorizzazione all’acquisto e uso (utilizzatori professionali) e vendita (distributori) dei prodotti fitosanitari (patentino) e per consulenti
(Delibera GP n. 1965 del 27 novembre 2020)
Rilascio autorizzazione per utilizzatori professionali (20 ore) 5
Rinnovo autorizzazione per utilizzatori professionali (12 ore) /
Rinnovo autorizzazione per utilizzatori professionali (da 1 a 11 ore come completamento del percorso formativo a crediti) /
Rinnovo autorizzazione per utilizzatori professionali (12 ore e ridotti) 7
Rilascio autorizzazione per la vendita dei prodotti fitosanitari (25 ore) 1
Rinnovo autorizzazione per la vendita dei prodotti fitosanitari (12 ore) /
Rilascio autorizzazione per l’attività di consulente (25 ore)
Rinnovo autorizzazione per l’attività di consulente (12 ore)
Totale partecipanti: 2.101
Formazione permanente per frutticoltori
a distanza e videoconferenza
a distanza
a distanza
In presenza in aula
a distanza
a distanza e in presenza in aula
Corsi organizzati in base all’Accordo dei servizi FEM-APOT dal 22 ottobre 2024 al 13 dicembre 2024 nell’ambito del percorso formativo a crediti per il rinnovo dell’autorizzazione all’acquisto e uso dei prodotti fitosanitari.
Formazione per viticoltori
Corsi organizzati in base all’Accordo dei servizi FEM-CAVIT dal 28 ottobre 2024 al 28 novembre 2024 nell’ambito del percorso formativo a crediti per il rinnovo dell’autorizzazione all’acquisto e uso dei prodotti fitosanitari.
Numero totale di edizioni organizzate (2 ore/edizione)
Numero totale dei partecipanti
Formazione per allevatori
Argomento Luogo
Incontro formativo sul tema STEC per gli allevatori della zona di Pinzolo Pinzolo
Incontro tecnico per allevatori ovicaprini San Michele all’Adige
Altri corsi di formazione
Edizioni
Corso teorico pratico apicoltura naturale con arnie Top Bar
di formazione sulla tecnica curetage
Incontro formativo su potatura di riforma
Tipo/sedi
In presenza (Cembra, Lavis, Roverè della Luna, Mori, Mezzolombardo, Nogaredo, Sarche, Riva del Garda, Aldeno, Avio, Isera)
Co-organizzatori
LatteTrento
Fondazione Edmund Mach, Vigalzano di Pergine Valsugana (TN)
Edmund Mach, San Michele all’Adige (TN)
Riva del Garda (TN)
INSEGNAMENTO
Laurea di primo livello in viticoltura ed enologia
Centro Agricoltura, Alimenti, Ambiente - C3A (Università degli Studi di Trento).
Insegnamenti relativi al secondo semestre aa 2023/2024 e al primo semestre aa 2024/2025
Laurea magistrale agrifood innovation management
Centro Agricoltura, Alimenti, Ambiente - C3A (Università degli Studi di Trento).
Insegnamenti relativi al secondo semestre aa 2023/2024 e al primo semestre aa 2024/2025
Corsi professionalizzanti e post diploma
Formazione PhD
TESI DISCUSSE NEL 2024
Laurea di primo livello
Nome Titolo
Giulio Barozzi L'invecchiamento dei vini rossi in anfora: effetto della tipologia sulla componente fenolica
Pietro Bicego Nuovo approccio analitico per la determinazione delle mannoproteine mediante cromatografia ionica
Anita Boscaro Paiola
Filippo Candioli
Qualificazione e quantificazione dei carotenoidi nell’uva
Valutazione dell’utilizzo dell’acido fumarico nelle prime fasi di vinificazione
Lorenzo Camellini Effetti del trattamento dell’acido fumarico come acidificante nei mosti
Anita Dal Santo Instabilità del tartrato di calcio nei vini bianchi
Luigi Ferrari
Sperimentazione diagnostica in due vigneti della Franciacorta per la gestione di giallumi e virosi della vite
Antonio Maria Fioretti Esperienze di utilizzo di Kluyveromyces marxianus in inoculo sequenziale nella vinificazione in bianco
Nicolò Fornasiero
Maria Gasparin
Anna Mittempergher
Matteo Ranzi
Annalaura Tanghetti
Valutazione della colorazione del filetto di trota iridea in relazione a diverse diete: confronto da analisi strumentali e panel test
Derivati cianici in enologia: nuovo approccio alla quantificazione in cromatografia ionica con detector amperometrico
Studio di proantocianidine in tannini condensati mediante cromatografia liquida accoppiata a spettrofotometria di massa ad alta risoluzione
Studio sull’ecologia di Anthonomus rubi in un’azienda di piccoli frutti trentina
Determinazione di solfuri liberi e totali in cromatografia ionica con detector amperometrico per l’analisi di prodotti enologici
Università
Relatore/CorrelatoreSupervisore/Co-supervisore FEM-CTT
Corso di Laurea in Viticoltura ed Enologia, C3AUniversità di Trento Tomas Roman
Corso di Laurea in Viticoltura ed Enologia, C3AUniversità di Trento
Corso di Laurea in Viticoltura ed Enologia, C3AUniversità di Trento
Corso di Laurea in Biotecnologie, Università degli studi di Ferrara
Corso di Laurea in Viticoltura ed Enologia, C3AUniversità di Trento
Corso di Laurea in Viticoltura ed Enologia, C3AUniversità di Trento
Corso di Laurea in Viticoltura ed Enologia, C3AUniversità di Trento
Roberto Larcher, Tiziana Nardin, Francesca Martinelli
Roberto Larcher, Tiziana Nardin, Francesca Martinelli
Tomas Roman
Roberto Larcher, Tiziana Nardin, Raffaele Guzzon
Roberto Larcher, Mario Malacarne
Valeria Gualandri
Corso di Laurea in Viticoltura ed Enologia, C3AUniversità di Trento Tomas Roman, Nicola Cappello, Mauro Paolini
Corso di Laurea in Tecnologie Agrarie ed Acquacoltura del Delta - Università degli Studi di Ferrara Filippo Faccenda, Tiziana Nardin
Corso di Laurea in Viticoltura ed Enologia, C3AUniversità di Trento Tiziana Nardin, Roberto Larcher
Corso di Laurea in Viticoltura ed Enologia, C3AUniversità di Trento Tiziana Nardin, Roberto Larcher, Francesca Martinelli
Corso di Laurea in Scienze e tecnologie agrarie, Università degli Studi di Padova Lorenzo Tonina
Corso di Laurea in Viticoltura ed Enologia, C3AUniversità di Trento Roberto Larcher, Tiziana Nardin
Laurea magistrale
Nome Titolo Università
Joaquin Homero Castanier Polit
Elisa Marchetti
Giulia Vinotti
Evaluating biological control strategies for aphid management: functional responses of predators and insecticide side-effects on parasitoids
Fusariosi del grano: caratterizzazione molecolare, analisi di patogenicità e implicazioni tecnologiche delle specie di Fusarium tossigeni isolati in trentino
Valorizzazione dei prodotti d’alpeggio tramite analisi di composti bioattivi
Premi e riconoscimenti
Relatore/Correlatore FEM-CTT
Corso di Laurea Sustainable agricoltureAgricoltura Sostenibile, Università degli Studi di Padova Serena Giorgia Chiesa
Corso di Laurea Magistrale in biologia della saluteCurriculum Biosanitario-Forense, Università di Bologna
Raffaele Guzzon, Valeria Gualandri
Corso di studio in Scienze della nutrizione umana, Università San Raffaele Roma Tiziana Nardin, Roberto Larcher
XXVI Convegno Nazionale di Agrometeorologia, L’Aquila 05 – 07 giugno 2024
Premio miglior poster
Mattedi Cecilia, Zottele Fabio, Centurioni Francesco, Caffarra Amélia, Corradini Stefano
Coupling stem water potential and soil water potential on irrigated and not irrigated vines. Preliminary results for Vitis vinifera L. cv Teroldego.
AFFILIAZIONI A SOCIETÀ SCIENTIFICHE/ACCADEMIE
SOCIETÀ SCIENTIFICA/ACCADEMIA - SITO WEB COMPONENTI
Accademia Italiana della Vite e del Vino - www.aivv.it
Accademia Olimpica, Vicenza - www.accademiaolimpica.it
Accademia roveretana degli agiati - www.agiati.it
American Phytopathological Society - www.apsnet.org
Associazione Costitutori Viticoli Italiani - ACOVIT - www.acovit.it
Assoenologi - www.assoenologi.it
AAB (Association of Applied Biologists) - www.aab.org.uk
ADCF (Association pour le développement de la culture fourragère) - www.adcf.ch
AIAM - Associazione Italiana di Agrometeorologia - www.agrometeorologia.it
AIPP - Associazione Italiana per la Protezione delle Piante - www.aipp.it
API - Associazione Piscicoltori Italiani - www.api-online.it
CISBA - Centro Italiano Studi Biologia Ambientale - www.cisba.it
Collegio Nazionale degli Agrotecnici e degli Agrotecnici Laureati - www.agrotecnici.it
Coloss - Honey bee research association - www.coloss.org
Federazione Nazionale degli Ordini dei Chimici e dei Fisici - Ordine Regionale dei Chimici e dei Fisici del Trentino Alto Adige www.chimicifisici.it
Federazione Italiana Dottori in Scienze della Produzione Animale - www.fidspa.it
GLOSOLAN - Global Soil Laboratory Network - www.fao.org/global-soil-partnership/glosolan Gruppo Microbiologia della Vite e del Vino - www.simtrea.org/it/gmvv-il-gruppo
Ordine Nazionale dei Dottori Agronomi e Dottori Forestali - www.conaf.it
ONAF Organizzazione Nazionale Assaggiatori Formaggi - www.onaf.it
Ordine dei Medici Veterinari - www.ordineveterinaritrento.it
Free Software Foundation - www.fsf.org
ICVG - International Council for the Study of Viruses and Virus-like Diseases of the Grapevine - www.icvg.org
ISHS - International Society for Horticultural Science - www.ishs.org
MCI - Mastitis Council Italia - www.mastitalia.org
Società Chimica Italiana - www.soc.chim.it
SIN - Società Italiana di Nematologia - www.nematologia.it
SIMTREA - Società Italiana di Microbiologia Agraria, Alimentare e Ambientale - www.simtrea.org
SISS - Società Italiana della Scienza del Suolo - www.scienzadelsuolo.org
SIVE - Società Italiana di Viticoltura ed Enologia - www.siveonline.it
Umberto Malossini, Roberto Larcher, Tomas Roman
Paolo Fontana
Paolo Fontana
Daniele Prodorutti
Umberto Malossini (presidenza-segreteria)
Franca Ghidoni (segretaria di sezione), Tomas Roman (Direttivo), Umberto Malossini, Duilio Porro, Paolo Martinatti, Federico Bruni
Daniel Bondesan
Gabriele Iussig
Stefano Corradini, Fabio Zottele
Umberto Malossini, Gino Angeli
Filippo Faccenda, Michele Povinelli
Francesca Ciutti
Paolo Martinatti
Paolo Fontana
Roberto Larcher, Mario Malacarne, Matteo Perini, Loris Tonidandel
Massimiliano Mazzucchi (Consiglio Direttivo)
Laboratorio chimico - reparto agraria
Raffaele Guzzon
Massimiliano Mazzucchi
Massimiliano Mazzucchi
Erika Partel, Michele Povinelli
Fabio Zottele
Umberto Malossini, Valeria Gualandri
Duilio Porro, Dario Angeli
Erika Partel
Roberto Larcher, Matteo Perini, Tiziana Nardin
Valeria Gualandri, Umberto Malossini
Raffaele Guzzon
Raffaella Morelli
Umberto Malossini
SOCIETÀ SCIENTIFICA/ACCADEMIA - SITO WEB COMPONENTI
SILPA - Società Italiana Laboratori Pedologici e Agrochimici - www.silpalab.it
SIPAV - Società Italiana di Patologia Vegetale - https://www.sipav.org/
SEI (SEA) - Società Entomologica Italiana (Sezione di Entomologia Agraria) https://www.societaentomologicaitaliana.it/sezione-di-entomologia-agraria/
SOI - Società di Ortoflorofrutticoltura Italiana - www.soihs.it
Società di Scienze Naturali del Trentino - http://www.naturalishistoria.it
SoZooAlp_ Società per lo studio e la valorizzazione dei sistemi zootecnici alpini www.sozooalp.it
The Orthopterists' Society - orthsoc.org
World Biodiversity Association onlus - https://biodiversityassociation.org/it
Laboratorio chimico
Valeria Gualandri
Lorenzo Tonina
Umberto Malossini, Duilio Porro, Roberto Zanzotti, Raffaella Morelli, Daniele Prodorutti, Sara Zanoni, Stefano Pedò
Lorenzo Tonina
Erika Partel (Direttivo), Gabriele Iussig
Paolo Fontana
Paolo Fontana (Presidente), Lorenzo Tonina
PARTECIPAZIONE COMITATI E GRUPPI DI LAVORO
COMITATI/GRUPPI DI LAVORO
Associazione Italiana Apiterapia
Comitato Albo Melissopalinologi (ministeriale)
Collegio dei Docenti del Dottorato di Agrifood and Environmental sciences - Università di Trento
COMPONENTI
Paolo Fontana
Paolo Fontana (presidente)
Roberto Larcher, Tomas Roman
Comitato provinciale della pesca Filippo Faccenda
Comitato di certificazione e salvaguardia e imparzialità, nell’ambito dell’organismo di controllo delle denominazioni di origine di interesse provinciale della Camera di Commercio Industria Artigianato e Agricoltura di Trento
Comitato tecnico Marchio Qualità Trentino
Commissione assaggio concorso Giornate del Riesling (Naturno, I)
Commissione valutazione formaggi di malga Formai dal Mont Tassullo
Commissione valutazione formaggi di malga della Valsugana
Maurizio Bottura, Alberto Gelmetti (sostituto)
Erica Candioli
Raffaele Guzzon
Silvia Schiavon (organizzazione), Massimiliano Mazzucchi (supporto)
Silvia Schiavon (organizzazione), Massimiliano Mazzucchi (supporto)
Commissione assaggio grappe per il rilascio del marchio dell’Istituto tutela grappa del Trentino Paolo Barchetti
Commissione suolo Consorzio Vini Trentino
Commissione SQNPI Consorzio Vini Trentino
Commissione fitofarmaci Consorzio Vini Trentino
Commissione provinciale di gestione Disciplinare di produzione integrata del settore melo
Commissione provinciale di controllo Disciplinare di produzione integrata del settore melo
Commissione provinciale di gestione Disciplinare di produzione integrata del settore piccoli frutti, orticoltura e mais da polenta
Commissione provinciale di controllo Disciplinare di produzione integrata del settore piccoli frutti, orticoltura e mais da polenta
Commissione metodi analitici dell’Organizzazione Internazionale della Vigna e del Vino (OIV Commission II “OENOLOGY”)
Commissione Microbiologia dell’Organizzazione Internazionale della Vigna e del Vino (OIV Commission “MICRO”)
Commissione esame corso Trentinerbe
Comitato tecnico scientifico rivista Vite & Vino (Edizioni L’Informatore Agrario)
Comitato tecnico scientifico delle Giornate Fitopatologiche (Università di Bologna)
Comitato tecnico scientifico tutela api autoctone
Comitato Tergeo (Unione Italiana Vini) - Giuria Challenge Enovitis
CREA - Albo esperti nazionale (SSD-AGR/12 Patologia vegetale)
Eufrin (European Fruit Institutes Network) - Sustainable Fruit Production to minimize residues Working group
Eufrin (European Fruit Institutes Network) - Fruit Thinning Working Group
Gruppo di lavoro permanente per la protezione delle piante MASAF sez. Materiali di moltiplicazione della vite (D.M. 30.06.2016 n. 1173)
Gruppo di lavoro per la rete laboratoristica nazionale MASAF
Gruppo di lavoro Diabrotica del Servizio fitosanitario nazionale
Gruppo di lavoro post-raccolta SOI-ISHS
Gruppo di lavoro viticoltura SOI
Gruppo Ricerca Italiano Modelli Protezione Piante (GRIMPP)
Gruppo di lavoro analisi impiego prodotti fitosanitari e impatto sulla salute PAT
Gruppo di lavoro implementazione PAN trattamenti centri abitati PAT
Duilio Porro, Stefano Pedò, Roberto Zanzotti
Maurizio Bottura, Roberto Zanzotti, Gastone Dallago
Maurizio Bottura, Alberto Gelmetti
Gastone Dallago, Tommaso Pantezzi, Maurizio Bottura
Dario Angeli, Lorenzo Turrini
Tommaso Pantezzi, Maurizio Bottura
Dario Angeli, Lorenzo Turrini
Matteo Perini (esperto)
Raffaele Guzzon (esperto)
Luigi Bertoldi
Raffaele Guzzon
Gastone Dallago
Paolo Fontana
Stefano Pedò
Umberto Malossini
Gino Angeli
Roberto Torresani
Umberto Malossini
Valeria Gualandri
Roberta Franchi
Dario Angeli
Duilio Porro
Gastone Dallago
Gastone Dallago
Gastone Dallago
COMITATI/GRUPPI DI LAVORO
Gruppo di lavoro implementazione PAN trattamenti in ambito extra agricolo PAT
Gruppo di lavoro misure per il miglioramento dello stato qualitativo dei corpi idrici con impatti da fitofarmaci utilizzati in agricoltura (Art. 8 PAN)
ISHS Membership - Workgroup Mineral Nutrition of Fruit Crops, Commission Irrigation and Plant Water RelationsCommission Plant Substrates and Soilless Culture
NPVV - Nucleo di Premoltiplicazione Viticola delle Venezie
Nucleo di Premoltiplicazione Viticola C. Naldi, Regione Emilia-Romagna
OIV Organizzazione Internazionale della Vite e del Vino - Esperto permanente nella sezione Specific Sub-Commission
OIV Organizzazione Internazionale della Vite e del Vino - Esperto permanente nella sezione Methods of Analysis Sub-Commission
Servizio di Ispezione ai Centri di controllo funzionale delle macchine irroratrici (delibera PAT n. 2008 del 2012).
Sistema di qualità nazionale per la produzione integrata MASAF - Gruppo di lavoro difesa (DM 2722 del 17 aprile 2008)
Sistema di qualità nazionale per la produzione integrata MASAF - Gruppo di lavoro agronomia (DM 2722 del 17 aprile 2008)
Società Italiana Laboratori Pedologici e Agrochimici (SILPA)
Tavolo tecnico-scientifico nazionale di coordinamento Halyomorpha halys - MASAF
Tavolo tecnico-scientifico nazionale su Elateridi della patata - MASAF
Tavolo di lavoro Gestione sostenibile degli effluenti zootecnici (Accordo di Programma APPA, Servizio Agricoltura PAT, FEM, APOT, FPA, Consorzio Vini)
Tavolo settore zootecnico PAT (FEM, FPA, APSS, Ordine medici veterinari, CONCAST, Latte Trento)
Tavolo provinciale apicoltura-frutticoltura
Working Group EPPO (European Plant Protection Organization) - Pest Risk Analysis on D. suzukii
COMPONENTI
Gastone Dallago
Gino Angeli, Daniel Bondesan, Andrea Branz
Duilio Porro
Maurizio Bottura
Umberto Malossini (Comitato Tecnico Scientifico)
Matteo Perini
Matteo Perini
Daniel Bondesan
Gastone Dallago
Gastone Dallago (supplente)
Andrea Ceschini (Consiglio Direttivo)
Serena Giorgia Chiesa
Luigi Bertoldi
Roberta Franchi, Gabriele Iussig
Erika Partel, Gabriele Iussig
Paolo Fontana, Livia Zanotelli, Maurizio Bottura, Matteo de Concini
Alberto Grassi

IL PERSONALE DEL CTT 2024
Direzione
Bottura Maurizio Dirigente
Cimarolli Donatella, De Oliva Sarah, Demattè Lidia, Lorandini Luisa, Pancher Sabrina, Paternoster Maria Cristina, Pedrazzoli Rudi
Unità Comunicazione tecnica e supporto ai servizi
Candioli Erica Responsabile
Cainelli Roberta, Dalpiaz Michela, Tomasi Arianna
Dipartimento Innovazione nelle produzioni agrarie e zootecniche
Pantezzi Tommaso Responsabile
Unità Frutticoltura
Pantezzi Tommaso Responsabile
Andreatti Nicola, Barchetti Daniele, Bertagnolli Andrea, Berti Michele, Branz Andrea, Chini Loris, Chini Maurizio, de Concini Matteo, Defant Cristian, Delaiti Lodovico, Flaim Damiano, Gabardi Deborah, Iachemet Davide,
Iori Lorenzo, Mattè Bruno, Panizza Claudio, Pezzè Massimo, Prantil Massimo, Toniolli Fabio, Zaffoni Mattia
Personale non strutturato
Chini Christian, Dalpiaz Veronica, Marcolla Alessandro, Martini Elena, Rizzi Erica, Zorzi Cristiano
Unità Piccoli frutti, olivo e ortofloricoltura
Pantezzi Tommaso Responsabile
Bertoldi Luigi, Brentari Luca, Ganarin Gianpiero, Giuliani Gianluca, Gottardello Angela, Grassi Alberto, Martinatti Paolo, Miorelli Paolo, Morten Michele, Puppato Simone, Zanoni Paolo
Personale non strutturato
Dallago Alex, Marchio Luca, Menestrina Camilla, Rossi Elena
Unità Frigoconservazione e certificazioni agroalimentari
Angeli Dario Responsabile (Benvenuti Fabrizio fino al 31/07/2024)
Ceccato Mirko, Pallaoro Marco, Pancheri Ivo, Pangrazzi Marcello, Turrini Lorenzo, Zeni Fabio, Zucal Michele
Personale non strutturato
Pedergnana Alessandro, Valentini Milena, Viliotti Giuseppe
Unità Viticoltura
Gelmetti Alberto Responsabile
Bianchedi Pier Luigi, Chiusole Marco, Del Fabbro Rolando, Ghidoni Franca, Lucin Roberto, Malossini Umberto, Margoni Michele, Mattedi Flavio, Penner Francesco, Zuanazzi Mauro
Personale non strutturato
Dall’Agnol Nicola
Unità Risorse foraggere e produzioni zootecniche
Iussig Gabriele Responsabile
Franchi Roberta, Mazzucchi Massimiliano, Partel Erika, Peterlini Marco, Sandri Nicola
Personale non strutturato
Roner Ingrid, Silvestri Andrea
Dipartimento Sperimentazione agraria, forestale e ambientale
Dallago Gastone Responsabile
Unità Protezione delle piante agroforestali e apicoltura
Angeli Gino Responsabile
Bargna Sacha, Bondesan Daniel, Chiesa Serena Giorgia, Endrizzi Emanuel, Fontana Paolo, Maresi Giorgio, Rizzi Claudio, Sofia Monica, Toldo Luca, Tonina Lorenzo, Zanotelli Livia
Personale non strutturato
Bertoldi Alessia, Boneccher Giorgia, Clappa Elena, Salvadori Michela, Santuari Daniele, Scrinzi Riccardo
Unità Agricoltura biologica e qualità del suolo
Prodorutti Daniele Responsabile
Coller Emanuela, Forno Flavia, Maines Romano, Morelli Raffaella, Pedò Stefano, Zanoni Sara, Zanzotti Roberto
Personale non strutturato
Delaiti Simone, Raiola Pasquale, Spagnolli Olmo
Unità Sperimentazione in frutticoltura
Micheli Franco Responsabile
Guerra Andrea, Iob Cristian, Moser Damiano, Pasqualini Jonathan, Torresani Roberto
Personale non strutturato
Odorizzi Davide
Unità Agrometeorologia e irrigazione
Corradini Stefano Responsabile
Andreis Daniele, Biasi Alessandro, Paternolli Ugo, Piffer Ivan, Zottele Fabio
Personale non strutturato
Centurioni Francesco, Gebremedhin Desta Gebre, Mattedi Cecilia
Unità Acquacoltura e idrobiologia
Faccenda Filippo Responsabile
Cappelletti Cristina, Ciutti Francesca, Povinelli Michele, Tanel Marco
Personale non strutturato
Chemello Andrea, Ciani Elia, Rossi Lorenzo
Unità Centro di saggio
Dallago Gastone Responsabile
Baldessari Mario, Delaiti Marco, Giuliani Graziano, Mucci Massimo, Porro Duilio, Tomasi Cristina, Waldner Andrea
Dipartimento Alimenti e trasformazione
Larcher Roberto Responsabile
Unità Chimica vitienologica e agroalimentare
Larcher Roberto Responsabile
Barbero Alice, Barchetti Paolo, Bertoldi Daniela, Ceschini Andrea, Colapietro Marco, Dalvit Federica, Decarli Fabrizio, Malacarne Mario, Martinelli Francesca, Merci Daniele, Nardin Tiziana, Paolini Mauro, Perini Matteo, Pianezze Silvia, Pilati Michela, Rossi Sergio, Sartori Loretta, Sigismondi Lorena, Todeschi Stefania, Tonidandel Loris, Trainotti Debora
Personale non strutturato
Bortolotti Selene, Camellini Lorenzo, Tanghetti Annalaura
Unità Diagnostica fitopatologica
Gualandri Valeria Responsabile
Bragagna Paola, Cainelli Christian, Tolotti Gessica
Personale non strutturato
Fattore Thomas, Vicelli Bianca
Unità Trasformazione enologica e alimentare
Roman Tomas Responsabile
Bruni Federico, Cappello Nicola, Facchinelli Giovanna, Guzzon Raffaele, Schiavon Silvia
Personale non strutturato
Mittempergher Anna
Hanno collaborato con noi i dipendenti a tempo indeterminato
dell’Azienda Agricola FEM:
Brugnara Luigi, Caset Danilo, Delvai Walter, Moscon Renzo
Hanno frequentato le nostre strutture:
47 frequentanti per dottorati di ricerca, borse di studio e progetti di ricerca, tirocini curricolari, tesi di laurea, alternanza scuola lavoro per un totale di 4.164 giornate lavorative.
